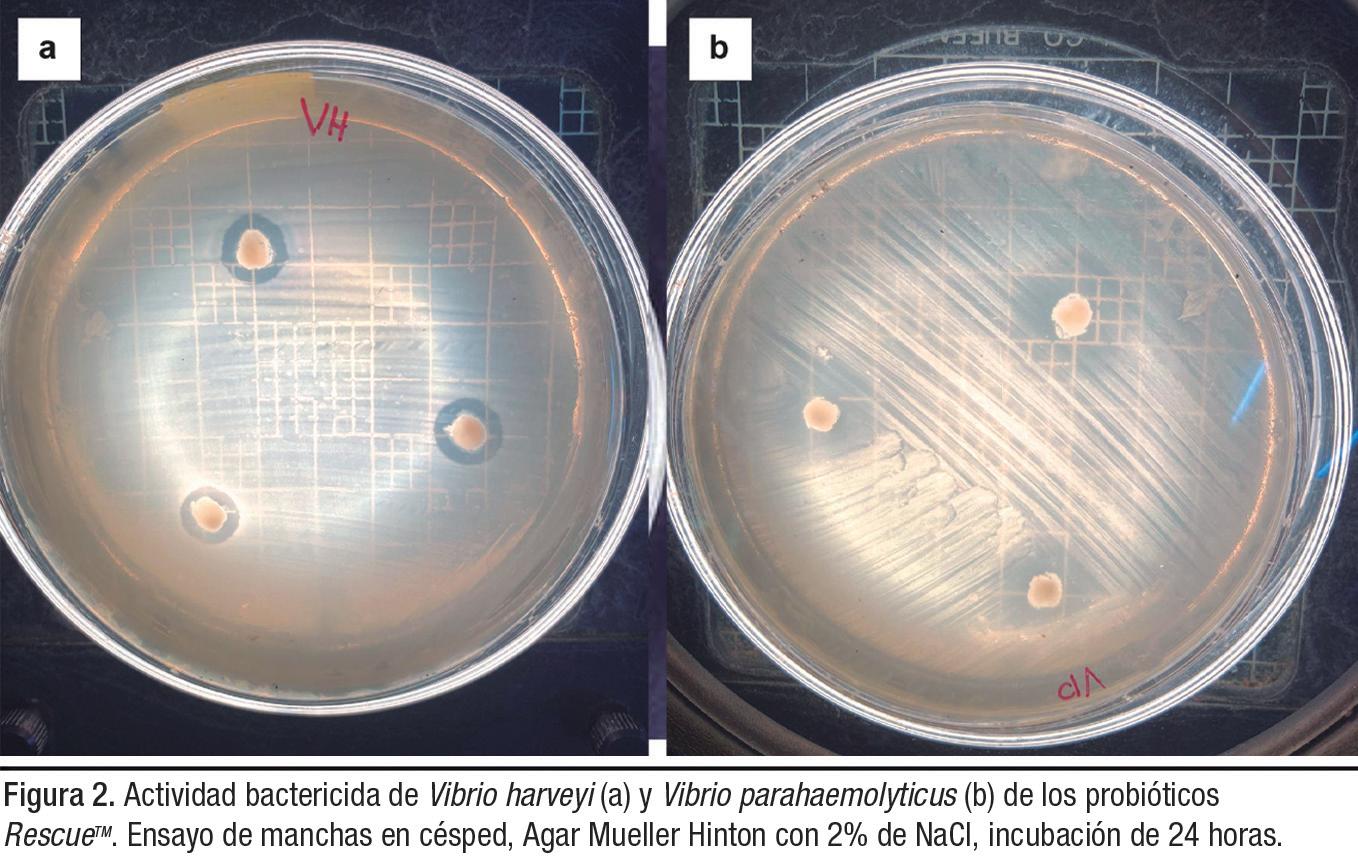

Tu nuevo aliado para el cuidado del camarón, que se adapta a diferentes retos promoviendo un cultivo exitoso.
Para más información sobre nuestros productos contacta a nuestros asesores Cargill

Los efectos del cambio climático en el crecimiento de la producción acuícola mundial: desafíos, afectaciones e impacto económico
Los efectos del cambio climático en el crecimiento de la producción acuícola mundial: desafíos, afectaciones e impacto económico

Motiv representa un nuevo enfoque único para las dietas de los camarones. En lugar de depender de aditivos para obtener beneficios funcionales, simplifica la dieta con un macro ingrediente funcional. Por medio de un proceso de fermentación único, Motiv promueve un ambiente intestinal saludable. Esto resulta en un mayor crecimiento y tasa de supervivencia debido a un mejor aprovechamiento de nutrientes y resistencia a las enfermedades, por medio de una respuesta inmune y resistencia al estrés mejoradas. La fuerza para el crecimiento y la vitalidad. motivshrimp.com

Los efectos del cambio climático en el crecimiento de la producción acuícola mundial: desafíos, afectaciones e impacto económico


Noticias
Perspectivas
Diagnóstico de la piscicultura marina en Baja California Sur, México
Directorio
Análisis
DIRECTOR Salvador Meza info@dpinternationalinc.com
EDITOR ASOCIADO
Marco Linné Unzueta
COORDINADORA EDITORIAL
Karelys Osta edicion@dpinternationalinc.com
DIRECCIÓN ADMINISTRATIVA
Adriana Zayas Amezcua administracion@dpinternationalinc.com
COORDINACIÓN DE OPERACIONES
Johana Freire opm@dpinternationalinc.com
COLABORADORES EDITORIALES Carlos Rangel Dávalos
DISEÑO EDITORIAL / PUBLICITARIO Perla Neri / Rozana Bentos design@dpinternationalinc.com
VENTAS Y MARKETING crm@dpinternationalinc.com
CIRCULACIÓN Y SUSCRIPCIONES Renée Meza suscripciones@panoramaacuicola.com
OFICINA EN LATINOAMÉRICA
Empresarios No. #135 No. Int. Piso 7 Oficina 723, Col. Puerta de Hierro, C.P. 45116 Zapopan, Jal., México. Cruza con las calles Av. Paseo Royal Country y Blvrd. Puerta de Hierro Tels: +(33) 8000 0578
OFICINA EN ESTADOS UNIDOS DP INTERNATIONAL INC. 401 E Sonterra Blvd. Sté. 375 San Antonio, TX. 78258 info@dpintertnatinonalinc.com
COSTO DE SUSCRIPCIÓN ANUAL
$750.00 M.N. DENTRO DE MÉXICO USD $100.00 EE.UU., CENTRO Y SUDAMÉRICA €80 EUROPA Y RESTO DEL MUNDO (SEIS NÚMEROS POR UN AÑO)
PANORAMA ACUÍCOLA MAGAZINE, Año 29, marzo - abril 2024, es una publicación bimestral editada y distribuída por Design Publications, S.A. de C.V. Av. Empresarios #135 Piso 07 Oficina 723 Col. Puerta de Hierro CP. 45116. Zapopan, Jalisco, México. Tel: +52 (33) 80 00 05 78, www.panoramaacuicola.com, info@dpinternationalinc.com. Editor Responsable: Salvador Antonio Meza García. Número de Reserva de Derechos de Uso Exclusivo 04-2019071712292400-01, licitud de Título No. 12732, Licitud de Contenido No. 10304, ambos otorgados por la Comisión Calificadora de Publicaciones y Revistas Ilustradas de la Secretaría de Gobernación. Permiso SEPOMEX No. PP-14-0033. Impresa por Negocios Gráficos Grafinpren S.A. Teléfono: 04-2221362 ext 28 / 0959537917. Av. C.J. Arosemena Km 2.5 Antiguo Coliseo Granasa, Guayaquil, Ecuador. Este número se terminó de imprimir el 30 de septiembre de 2023 con un tiraje de 3,000 ejemplares. La información, opinión y análisis contenidos en esta publicación son responsabilidad de los autores y no reflejan necesariamente el criterio de esta editorial. Queda estrictamente prohibida la reproducción total o parcial de los contenidos e imágenes de la publicación sin previa autorización de Design Publications, S.A. de C.V.
Tiraje y distribución certificados por Lloyd International
Visite nuestra página web: www.panoramaacuicola.com

También síganos en:
Artículo de fondo
Consumo de oxígeno de Litopenaeus vannamei en estanques intensivos basado en Modelado de Sistemas Dinámicos
Artículos
Evaluando el Costo del Ciclo de Vida de un sistema de bombeo
La importancia de la industria del rendering en América del Norte para la fabricación de alimentos acuícolas sostenibles
Revolucionando la cría del camarón: los beneficios únicos de MOTIVTM
Soluciones innovadoras de Megasupply: tratamiento biorremediador para suelos en piscinas acuícolas
Suplementación alimentaria con una mezcla probiótica de Bacillus para el control de Vibrio patógenos en camarones cultivados
Entrevista exclusiva con Cargill®: descubriendo
AquaxcelTM Adapt, la innovación en nutrición para camarones
Manejo de laboratorios de larvas: la importancia del vínculo entre apetito y estrés
aquaManager, proveedor líder en tecnología para una acuicultura precisa, automatizada y predecible
Soluciones microbianas: fuente inigualable de soluciones para la cría de camarón
Descubre cómo la innovación y la tecnología están abordando los nuevos desafíos de la acuicultura
¡Únete al Simposio de Acuicultura en Guatemala 2024!
4to Summit Latinoamericano por la Sustentabilidad Pesquera y Acuícola: es tiempo de acción












CIDEEA
Carpe Diem
En la mira
Financiamiento para la acuicultura
Agua +
Nueva
¿Diversificación o diversión?
Debemos consolidar la cooperación de las diversas regiones. ¿Podrá la Comunidad de los Países del Golfo (GCC) poner el ejemplo?
100% Fish, el nuevo modelo de negocio
Licencia social
Estrategias para controlar el síndrome de necrosis hepatopancreática aguda (AHPNS/EMS) y la enfermedad altamente letal del vibrio (HLVD/GPD/TPD) (Parte 2)
Tratamiento de lodos en estanques acuícolas mediante tecnología simbiótica
Impacta “El Niño”
Mejore el rendimiento de su email marketing

Las labores que se llevan a cabo como parte del principio de la pesca responsable, proporcionan a la autoridad pesquera y acuícola bases científicas sólidas, con datos fidedignos para conservar, ordenar y desarrollar la pesca y, de esta manera, contribuir al cuidado de la biodiversidad, los ecosistemas y el hábitat acuático.
Sin embargo, la actividad acuícola ha mostrado un crecimiento continuo en los últimos años y, ante la tendencia mundial, el deber rector de sus promotores será el diseño de políticas públicas que permitan fomentar un crecimiento ordenado de la acuicultura a nivel mundial, con metas claras por región, que atiendan la creciente demanda de la población, en cuanto a proteína animal de calidad, empleos e ingresos. Ante el panorama de estancamiento de la producción de proteína animal proveniente de los productos pesqueros, la alternativa para este tipo de proteína es la acuicultura y, al respecto, se cuenta con una amplia diversidad de climas y especies acuáticas autóctonas, en cada región del mundo, que pueden ser susceptibles de aclimatación para su cultivo en sistemas controlados. Es importante mencionar que, a pesar de que la acuicultura es uno de los sectores primarios con mayor crecimiento a nivel mundial, la producción acuícola es vulnerable a los efectos adversos de las enfermedades y condiciones ambientales. En los últimos años, el salmón del Atlántico cultivado en Chile, las ostras en Europa y la cría de camarón marino en varios países de Asia, América del Sur y África, se han visto afectadas por brotes de enfermedades que han causado pérdidas parciales o, en algunos casos, totales de la producción.
Por otro lado, el modelo de producción, enfocado principalmente a una sola especie de alto valor, operado por grandes empresas, no
es eficiente ni permite solventar el problema alimenticio de las diversas regiones del mundo, ya que, este tipo de productos se encuentra fuera del alcance del 99% de la población.
Adicionalmente a lo anterior, las problemáticas que enfrenta el sector acuícola son:
1. La escasa participación del sector privado, en particular, si la acuicultura se enfoca en grandes proyectos, con alto nivel de tecnificación en especies de alta demanda económica.
2. Los grupos de interés están desvinculados, sin mecanismos para el intercambio de información, avances y tecnología. Trabajos científicos aislados, los cuales deberán ser atendidos de manera conjunta entre los productores y los centros de investigación.
3. Inexistencia de una planeación gubernamental o un ordenamiento que guíe a la región hacia una sustentabilidad alimentaria en materia acuícola.
4. Carencia de tecnologías ecoeficientes probadas, aplicables a las condiciones de cada una de las regiones mundiales. Se debe “adaptar”, y no copiar, paquetes tecnológicos de producción.
5. Falta de capacitación para el sector acuícola tecnificado y el rural.
6. Empleos acuícolas mal remunerados.
7. Deseconomías de escala.
8. Bajo nivel de organización de los acuicultores.
9. Sector acuícola con bajos niveles de comercialización y desarrollo de sus productos.
10. Carencia de estudios de mercado y falta de estrategias para darle valor a los productos.
11. Falta de promoción a nivel nacional, lo que refleja un bajo consumo de productos acuícolas.
12. Conocimiento biológico parcial de las especies de cultivo.
13. Estudios limitados de reproducción en cautiverio.
14. Producción deficiente de semilla.
15. Falta de infraestructura para pruebas piloto.
16. Selección de especies inadecuadas.
17. Canales de comercialización limitados.
18. Mercado nacional no diferenciado.
19. Baja contribución porcentual, en términos productivos, al resto de las actividades acuícolas.
20. Escaso conocimiento de enfermedades acuícolas y sus tratamientos preventivos/correctivos.
21. Afectación climática.
Por lo anterior, y con un énfasis en el Desarrollo Regional, dado que los niveles de prosperidad en el mundo muestran grandes contrastes íntimamente ligados a las diferentes capacidades productivas, se deberá hacer frente a los retos mencionados y poder detonar un mayor crecimiento económico, buscando construir un sector productivo que garantice la seguridad alimentaria mundial. Esto implica impulsar al sector, con la ayuda de inversión en desarrollo de capital físico y humano. Siendo necesario, además, fomentar modelos de asociación que aprovechen economías de escala y generen valor agregado, así como otorgar certidumbre en la actividad agroalimentaria mediante mecanismos de administración de riesgos. Asimismo, se deberá incentivar el aprovechamiento sustentable de los recursos naturales de cada una de las regiones, a través de un marco de respeto que equilibre los factores de la producción a efecto de promover el empleo de calidad.
Editor Asociado Marco Linné Unzueta

El acuerdo beneficia a más de 500 estudiantes y tiene como objetivo identificar talentos en el área de nutrición animal

Cargill de México y la Universidad Autónoma de Querétaro (UAQ), anunciaron la firma de un convenio de colaboración que busca en conjunto realizar actividades académicas, de investigación, eventos relacionados a la nutrición animal, así como despertar en los estudiantes el interés por las áreas de producción y salud animal.
Este acuerdo surge como una necesidad de colaborar muy de cerca con las instituciones educativas para el desarrollo de investigación en esta práctica, con la intención de compartir los resultados obtenidos a los clientes de Cargill. Este acercamiento y relacionamiento permitirá identificar profesionistas que puedan desempeñar un papel en la industria.
El convenio en conjunto incluye la colaboración en temas de desarrollo de talentos, así como la generación e implementación de investigación para llevar innovación a los productores de proteína animal en México, dos áreas importantes para el propósito y visión de Cargill.
La firma de convenio con la Licenciatura en Medicina Veterinaria y Zootecnia de la UAQ, beneficia a los estudiantes y equipos de investigación de la Universidad y a Cargill, una colaboración mutua que ha existido y existirá entre las dos partes, que fomentará la captación de talentos y el desarrollo de innovación en nutrición animal.
Dentro de la Licenciatura en Medicina Veterinaria y Zootecnia, colaboran especialistas en el área de nutrición, salud, calidad de carne,
bioquímica, histología, reproducción y producción animal sustentable, lo que permitirá conectar con otras áreas relacionadas a la nutrición animal.
“En Cargill Animal Nutrition producimos soluciones innovadoras, transformadoras y sustentables para la industria de la producción animal. Esto significa ayudar a alimentar a un mundo creciente y a encontrar nuevas formas de maximizar la conversión de alimentos y mejorar el rendimiento animal”, señaló Raphael Oliveira, director de Cargill Animal Nutrition para México. “El convenio con la UAQ refuerza nuestro compromiso con la comunidad académica al proporcionarle las herramientas necesarias para su desarrollo y crecimiento en este sector, así como compartir el amplio conocimiento especializado que tenemos en soluciones de nutrición animal”.
“Para la UAQ, es importante que las empresas tengan contacto con las instituciones educativas para promover el acercamiento de los estudiantes y enriquecer los conocimientos teóricos en prácticos, además de despertar su interés en diferentes áreas de la producción y salud animal”, comentó el Dr. José Guadalupe Gómez Soto, director de la Facultad de Ciencias Naturales. “Desarrollar juntos nuevos conocimientos es un punto importante para llevarlo a los clientes finales y mejorar la salud y productividad, además del cuidado del medio ambiente”, reiteró el Dr. Gómez Soto.
En su compromiso de nutrir al mundo de manera segura, respon-
sable y sostenible, Cargill continúa con sus esfuerzos para romper barreras y forjar un futuro más próspero en las comunidades donde tiene presencia.
Acerca de Cargill
Cargill se compromete a suministrar alimentos, ingredientes, soluciones agrícolas y productos industriales para nutrir al mundo de forma segura, responsable y sostenible. Situados en el centro de la cadena de suministro, colaboramos con agricultores y clientes para obtener, fabricar y suministrar productos vitales para la vida.
Los 160,000 miembros de nuestro equipo innovan con propósito, proporcionando a los clientes lo esencial para que las empresas crezcan, las comunidades prosperen y los consumidores vivan bien. Con 159 años de experiencia como empresa familiar, miramos hacia el futuro manteniéndonos fieles a nuestros valores. Priorizamos a las personas. Apuntamos a la excelencia. Hacemos lo correcto, hoy y para las futuras generaciones. Para más información, visite cargill.com y nuestro Centro de Noticias.
Acerca de la Facultad de Ciencias Naturales
La Facultad de Ciencias Naturales (FCN) forma parte de las trece Facultades de la Universidad Autónoma de Querétaro, desarrolla sus actividades sustantivas como lo son docencia, investigación y extensión. Su misión describe el compromiso social de mejorar continuamente los programas académicos y los mecanismos de aprovechamiento y actualización de recursos humanos y materiales en las áreas biológica, ambiental, veterinaria y de nutrición humana. Para más información, visite Facultad de Ciencias Naturales UAQ.
Para más información: Contacto: Mónica Guerrero, monica_guerrero@cargill.com
Se trata del biólogo marino Marcelo Oyarzún, que cuenta con más de 20 años de experiencia en la industria salmonicultura chilena, quien representará a la compañía en ambos países.
 Por: Aker BioMarine.
Por: Aker BioMarine.
Aker BioMarine (AKBM), innovadora empresa especializada en biotecnología y pesca de krill antártico, dedicada a mejorar la salud humana y del planeta, informó que el pasado 1 de febrero Marcelo Oyarzún Roa, asumió el cargo de gerente técnico de ventas para Chile y Ecuador.
Biólogo Marino de la Universidad Austral de Chile (UACH) y diplomado en Gestión y Estrategia de Ventas en la Universidad de Chile, el profesional cuenta con una exitosa trayectoria de dos décadas en la industria del salmón. Los inicios de su carrera se remontan al 2000, cuando se integró a la empresa Marine Harvest (actualmente MOWI) en el área de producción. Seis años más tarde migró a Skretting Chile, productora de alimentos para la acuicultura, donde se desempeñó primero como asistente técnico, en el Área Comercial, y luego, a partir de 2019, como product manager Fish Quality, donde se destacó por el desarrollo de diversos e innovadores proyectos para clientes.
“Estoy muy feliz de unirme a una empresa global como esta, con una visión clara del negocio, donde espero impulsar una estrategia comercial muy orientada al cliente. Me atrae mucho la innovación, y
el trabajo de Aker BioMarine me resulta tremendamente inspirador, por lo que comienzo este nuevo desafío con mucho entusiasmo”, declara Marcelo Oyarzún. Esta nueva designación se enfoca en el fortalecimiento de la presencia y el énfasis de Aker BioMarine en la región, particularmente en Chile y Ecuador.
“Sudamérica, con Chile y Ecuador especialmente, es una región importante para Aker BioMarine y la industria acuícola en general. Estamos felices de darle la bienvenida a nuestro colega Marcelo Oyarzún a nuestra compañía y con su experiencia y competencia construir una presencia aún más fuerte en la región en el futuro”, dice Sigve Nordrum, EVP Feed Ingredient en Aker BioMarine.
Tras su designación como gerente técnico de ventas de Aker BioMarine, el profesional asume el desafío de representar a la compañía en ambos países, dando continuidad a la implementación de la estrategia y plan de acción definidos para la región. Asimismo, será el responsable de potenciar el acercamiento con los clientes de las empresas de alimento y difundir los alcances del trabajo realizado en I&D por AKBM.
“Mi vida profesional siempre ha estado ligada a la profundización de las propuestas de valor de los productos con los que me he relacionado, lo que me ha permitido formar equipos con distintas áreas, internas o externas, logrando gestionar sólidos proyectos. Mi carrera la he enfocado, principalmente, en buscar soluciones a través de una buena estrategia del uso de dietas, por lo que entiendo el impacto y la importancia de contar con los nutrientes necesarios para enfrentar los desafíos asociados a la producción intensiva de peces. En los últimos años, mi principal foco ha estado en la calidad del producto final, lo que sin duda hoy es uno
de los grandes temas. Considero que un buen alimento es parte de la solución para avanzar hacia una industria cada día más sustentable. Por eso, estoy feliz de aportar hoy con este objetivo desde otra vereda”, recalca el ejecutivo.
En la actualidad, el producto más destacado de AkerBioMarineen Chile es Qrill™ Aqua Total, considerado como un “súper ingrediente” debido a que su composición nutricional es muy completa, pues contiene nutrientes funcionales como nucleótidos, omega 3 ligado a fosfolípidos, astaxantina y colesterol, entre otros.
Gracias a su composición, es altamente versátil, pues permite evaluar, en conjunto con los clientes, distintos enfoques para la estrategia de alimentación, ya sea en dietas funcionales, transferencia y engorda. Los beneficios de Qrill™ Aqua Total están enfocados en mejorar la robustez de los peces cultivados, optimizando su desempeño productivo, salud y bienestar, lo que finalmente repercute en la salud de las personas, que es uno de los objetivos de Aker BioMarine. Cada uno de estos atributos están documentados por el Departamento de I&D de la compañía, con publicaciones abiertas al público.
Para compartir esta experiencia y resolver dudas sobre Qrill™ Aqua Total, Aker BioMarine participó este año en AquaSur 2024, donde Marcelo Oyarzún estuvo acompañado de Valentina Tapia, VP Salmon Group en AKBM, quien viajó a Chile especialmente para este evento.
“Considerando los desafíos que enfrenta hoy el cultivo del salmón en nuestro país, queremos escuchar a nuestros actuales y potenciales clientes para entender sus necesidades presentes y futuras, y así poder reforzar nuestro rol de partner confiable y permanente”, concluye el profesional.

Un estudio publicado recientemente y realizado por Spring Genetics Tilapia en Miami, Aker BioMarine Antarctic AS y el Instituto de Ciencias del Mar (LABOMAR) en el noroeste de Brasil, evaluó si la inclusión de harina de krill en la dieta influía en el rendimiento reproductivo de la tilapia del Nilo y en la calidad y la cantidad de la descendencia.
El estudio concluyó que la inclusión de harina de krill resultó en efectos positivos sobre el rendimiento reproductivo de la tilapia del Nilo y una mayor supervivencia de las larvas.
La harina de krill ha emergido como un ingrediente marino rico en nutrientes y sostenible para los alimentos de acuicultura, una fuente de fosfolípidos, proteína marina de alta calidad, altos niveles de ácidos grasos omega-3: EPA y DHA, y astaxantina, todos ellos conocidos por ser beneficiosos para el crecimiento y la salud de los peces.
La harina de krill satisface las necesidades nutricionales y de sostenibilidad de los alimentos para acuicultura
La tilapia es el segundo pez más cultivado en acuicultura, y los
productores buscan descendencia de alta calidad para mejorar su producción total. En el presente estudio, los científicos evaluaron específicamente cómo los distintos niveles de harina de krill en la dieta de la tilapia del Nilo influían en factores como desove, cantidad y calidad de huevos, y supervivencia de las larvas.
“A través de estudios anteriores, hemos aprendido que los lípidos y los ácidos grasos esenciales pueden tener un efecto positivo en el rendimiento reproductivo de los peces. Tradicionalmente, los agricultores han incluido la harina y el aceite de pescado en los alimentos para satisfacer estas necesidades, pero debido a la creciente escasez y los costos fluctuantes, se necesitan ingredientes más sostenibles y efectivos. Aquí, la harina de krill podría ser parte de la solución para llenar ese vacío,” dice Kiranpreet Kaur, directora de I+D, Salud y Nutrición de Peces, Aker BioMarine.
Ensayo de alimentación con harina de krill en tilapia del Nilo
El ensayo de alimentación se realizó en instalaciones de cría de tilapia en Miami, Florida, durante 12 semanas. Los 792 reproductores de tilapia se dividieron en 12 jaulas, cada una

con una proporción de 3:1 hembras y machos. Los peces se alimentaron dos veces al día con una de las tres dietas de prueba: inclusión de harina de krill al 2%, inclusión de harina de krill al 5% o una dieta control que imita el alimento comercial para reproductores de tilapia del Nilo.
“Como socio local y facilitador de este estudio, especializado en la cría de tilapia del Nilo, buscamos continuamente formas innovadoras de mejorar el crecimiento, la supervivencia, y el rendimiento total. Para nosotros es importante asociarnos con otras partes interesadas, como Aker BioMarine, para realizar ensayos como este y aprender más sobre ingredientes prometedores como la harina de krill y cómo puede ayudarnos a mejorar el rendimiento de los reproductores,” afirma Hideyoshi Segovia Uno, CEO y copropietario de Spring Genetics.
Resultados clave del ensayo de alimentación de reproductores de tilapia del Nilo durante 12 semanas
“Al investigar los efectos de la harina de krill en el rendimiento reproductivo de los reproductores de tilapia del Nilo, observamos efectos positivos significativos. En resumen, observamos una mayor producción de huevos, un aumento de la frecuencia de desove y una mejora de la supervivencia larval comparado con la dieta de control –resultados que coinciden con estudios previos sobre la harina de krill en la dieta de peces marinos reproductores–. Este estudio ayuda a clarificar la relación entre nutrición y reproducción, así como el rendimiento general de los reproductores. Destaca el potencial para mejorar el rendimiento reproductivo de la tilapia,” dice el Dr. Alberto Nunes de LABOMAR y primer autor de este estudio.
Examinando los resultados detalladamente:
Producción total de huevos
9 La tilapia del Nilo alimentada con un 2% de harina de krill logró una producción de huevos un 18% superior a la del grupo control.
9 La tilapia del Nilo alimentada con un 5% de harina de krill logró una producción de huevos un 30% superior a la del grupo control.
Desove
9 La tilapia del Nilo alimentada con un 2% de harina de krill logró un 14% más de hembras desovando que el grupo control.
9 La tilapia del Nilo alimentada con un 5% de harina de krill logró un 29% más de hembras desovando que el grupo control.
9 La mayoría de las hembras que recibieron harina de krill en la dieta desovaron dos veces, comparado con los peces en el grupo control que desovaron mayoritariamente una vez durante el ensayo.
Supervivencia larvaria
9 La dieta con un 5% de harina de krill tuvo un efecto positivo sobre el número total de larvas 10 días después de la eclosión, un 10% más que el grupo control.
Composición del huevo
9 Los huevos de la tilapia del Nilo contenían un mayor contenido de grasa cuando los peces fueron alimentados con harina de krill.
9 Los niveles de ácidos grasos n-3, con EPA y DHA, fueron más altos en el grupo alimentado con un 5% de harina de krill comparado con el grupo control.
“En general, este estudio sugiere los efectos positivos de la inclusión de la harina de krill sobre el rendimiento reproductivo y la supervivencia larvaria en tilapia del Nilo,” añade Kiranpreet Kaur. “Estos resultados son un fuerte indicio de que la harina de krill es un ingrediente marino viable y rico en nutrientes para la dieta de reproductores de tilapia del Nilo. Esperamos seguir investigando para saber más.”
Enlace al artículo completo en el Journal of Applied Aquaculture: https://www.tandfonline. com/doi/full/10.1080/10454438.2024.2319646
Para obtener más información, póngase en contacto: Tormod Sandstø Director de Comunicaciones, Aker BioMarine ASA T: +47 90943215 E: tormod.sandsto@akerbiomarine.com


La organización de productores de camarón ecuatoriana Sustainable Shrimp Partnership (SSP) acaba de cumplir seis años de vida. Durante estos seis años, SSP y sus miembros han logrado avances que han sido significativos para el sector y que han redefinido la industria del camarón. Para ellos, estos logros reflejan un compromiso integral con la promoción de la sostenibilidad y la excelencia en cada fase de la cadena de suministro.
Entre los miembros fundadores de SSP se encuentran empresas ecuatorianas destacadas como Grupo Almar, Grupo Camaronero Champmar, Corporación Lanec, Omarsa, Promarisco y Songa. Su compromiso con la sostenibilidad coloca a SSP a la vanguardia de la transformación, permitiéndole abordar los desafíos actuales, anticipar los futuros e inspirar a otros a seguir su ejemplo, aseguran.
“El éxito de SSP no habría sido posible sin el compromiso de nuestros miembros. Ellos han tomado la iniciativa, demostrando que es posible conseguir una acuicultura limpia y sostenible, colaborando para identificar áreas de mejora y liderar el camino hacia un futuro más responsable para la industria”, expresa la directora de SSP, Pamela Nath.
El papel de sus miembros
En este sexto aniversario, la SSP resalta que es esencial reconocer el papel de sus miembros como motor de cambio. Ellos han implementado proyectos que promueven la transparencia y la responsabilidad ambiental y social, al mismo tiempo que se han comprometido en proveer de camarones producidos bajo los estándares más altos, libres de antibióticos, con un impacto neutro en el agua y completamente rastreables.
Además de los fundadores, existen también otros actores que han influido en el desarrollo y crecimiento de SSP a lo largo de estos años: sus miembros asociados. A pesar de que no son productores directos de camarón, tienen un rol fundamental para alcanzar la sostenibilidad en toda la cadena de valor de la acuicultura de camarón. Los miembros asociados SSP incluyen a BASF, BIOMAR, DSM-Firmenich, INVE Aquaculture, Houdek – Prairie Aquatech, MSD Salud Animal, Skretting y Vitapro.
“Las alianzas con nuestros miembros asociados tienen como objetivo combinar experiencia, redes de contacto y recursos innovadores para impulsar prácticas responsables. Ellos aportan una perspectiva diversa y conocimientos especializados que complementan nuestra labor. Su compromiso con la sostenibilidad no solo fortalece nuestra red, sino que también fomenta la colaboración entre diferentes actores de la industria. En SSP, estamos seguros de que el trabajo en equipo es crucial para alcanzar nuestros objetivos”, detalló Nath.
Avances significativos
Durante estos seis años, SSP y sus miembros han logrado avances significativos que han redefinido la industria del camarón. En primer lugar, la implementación de la calificación SSP ha sido un hito fundamental, ya que este estándar garantiza los más altos niveles sociales y ambientales en la producción de camarón, mediante verificaciones constantes en las granjas para asegurar la ausencia de antibióticos, un impacto neutro en el agua y una trazabilidad completa del producto, utilizando tecnología block-
chain para asegurar transparencia y confianza.
La creación de la Mesa de Liderazgo en Sostenibilidad también ha sido clave en este progreso, ya que ha permitido a la SSP participar en diversos y significativos proyectos con organizaciones destacadas. Entre ellos, la conservación y protección de manglares en Ecuador en asociación con la Universidad de Clark y el World Wildlife Fund (WWF), la promoción de la equidad laboral y salarios justos en colaboración con Sustainable Trade Initiative (IDH) y Aquaculture Stewardship Council (ASC), el Grupo de Trabajo en Acuicultura sobre Huella Ambiental, también con IDH.
En conjunto con The Nature Conservancy (TNC), se ha dedicado a la producción de camarones con una huella de carbono reducida, y finalmente, SSP se ha convertido en miembro de la plataforma de resistencia antimicrobiana de la Organización de las Naciones Unidas para la Agricultura y la Alimentación (FAO).
Más recientemente, el lanzamiento del “Programa Scale Up” para laboratorios de larvas ha sido hito importante, ya que tiene como objetivo fomentar el manejo sostenible de la producción larvaria de camarón, reconociendo y promoviendo a los laboratorios comprometidos con la mejora de la calidad del producto y su impacto ambiental y social.
Además, SSP ha llevado a cabo varias actividades de concientización para consumidores, como el “Shrimp Summit Ecuador”. Este evento ofrece a minoristas y proveedores de mariscos la oportunidad de conocer de cerca el compromiso de los productores ecuatorianos con la producción sostenible de camarón.

Abastible presenta innovadora solución para aumentar la productividad de los centros de cultivos

El equipo de especialistas en eficiencia energética de la compañía diseñó una plataforma para medir el comportamiento de los salmones, a partir del análisis de las variables críticas del ciclo, que mediante la integración de inteligencia artificial y machine learning, permite accionar medidas predictivas, reduciendo costos operacionales, merma y mejorando la productividad.
En el marco de Aquasur 2024, el encuentro más relevante de la industria acuícola, Abastible presentó su nueva solución, que busca predecir el comportamiento de los salmones, a partir del análisis de las variables críticas del ciclo: oxígeno, temperatura, salinidad, calibre y distribución del salmón, desperdicio de alimento, uso de preparados y detección de cuerpos extraños.
Ignacio Mackenna, gerente comercial de Soluciones Energéticas de Abastible, detalló que “con esta información y tecnología avanzada en clasificación de datos, impulsada por inteligencia artificial y machine learning se establecen medidas predictivas y de gestión, que permitirán obtener beneficios concretos como la reducción de la mortalidad y homogeneidad de crecimiento del salmón, optimización del uso de preparados, estabilizar y controlar el caudal de oxígeno y gestionar alertas de acercamiento de cuerpos extraños”.
Esta iniciativa complementa el robusto portafolio de soluciones energéticas para el segmento acuícola, compuesto por soluciones térmicas y eléctricas, como la optimi-
zación de central de vapor, hornos incineradores de mortalidad y residuos sólidos, temperado de agua en pisciculturas, climatización de espacios, así como la generación de electricidad en zonas donde no es posible enlazar con el sistema interconectado.
A lo anterior, se suman las soluciones de movilidad como la conversión diésel a gas en motores fuera de borda, reduciendo la contaminación y el riesgo de derrame de combustible, con la instalación de cilindros de fibra de carbono de última tecnología, más livianos y que permiten ver al operador fácilmente el nivel de llenado de cada uno. Esto viene complementado con instalaciones marinas de gas en pontones, plataformas y catamaranes que permiten abastecer combustible con todos los estándares de seguridad, facilitando la logística de operación.
La integración de estas soluciones es realizada por una red de especialistas de Abastible para diseñar e implementar proyectos que permiten aumentar la productividad de los procesos, mejorando la eficiencia en el consumo energético y disminuyendo las emisiones contaminantes.
En Aquachile, por ejemplo, en su piscicultura de Hollemberg, en la región de Magallanes, Abastible implementó una solución energética integral, que permitirá optimizar el consumo de energía, a través de un proyecto de cogeneración, para obtener energía eléctrica y térmica de forma simultánea para sus proce-
sos productivos acuícolas, bajando considerablemente la huella de carbono y disminuyendo el uso de energía. Además, el equipamiento de medición utilizado permite el seguimiento energético en tiempo real, tanto del uso de combustible como de energía eléctrica y térmica aportada.
Por su parte, la salmonera Cooke, apoyada por Abastible, llevó a cabo en sus operaciones un proyecto de generación eléctrica a gas licuado (GL) en su base de Aysén, que mejoró considerablemente las emisiones de gases efecto invernadero al medio ambiente, que evita los derrames de hidrocarburos al agua; además, eliminó completamente la manipulación de combustibles de sus operarios.
En tanto, la compañía realizó el último y más reciente proyecto en Alimar -procesadora de alimentos de pescado-, con lo que, con las medidas de eficiencia energética aplicadas en la producción de vapor, han permitido aumentar sus KPIs en la disminución de emisiones contaminantes y alcanzar importantes beneficios energéticos.
“En Abastible queremos movilizar a toda la acuicultura hacia una operación más eficiente, aportando con proyectos innovadores y seguros que diseñamos y desarrollamos en conjunto con nuestros clientes, que permiten fomentar el uso eficiente de energía en los procesos, asegurando la continuidad operacional”, señaló Mackenna.

La piscicultura marina de Baja California Sur (B.C.S.) se desarrolla gracias a que la entidad cuenta con una ubicación geográfica privilegiada, una gran riqueza y diversidad de recursos naturales; de allí la importancia de conocer acerca de la vigencia de los Permisos de Acuacultura de Fomento y Concesiones de Acuacultura Comercial en el Estado de B.C.S., con la finalidad de profundizar en los aspectos más relevantes relacionados con el desarrollo, la evolución y el impacto del cultivo de peces.
Por: Víctor Laurencez-Reyes, José A. Estrada-Godinez, Marisela Aguilar-Juárez, Ma. del Rosario Pacheco-Marges, Deneb Maldonado-García, Minerva C. Maldonado-García, Juan C. Lapuente-Landero*
Introducción
De acuerdo con el informe de la Organización de las Naciones Unidas para la Alimentación y la Agricultura (FAO), titulado “Agricultura mundial: hacia los años 2015/30”, enfrentamos una desnutrición crónica que afecta a más de 800 millones de personas: el 17% de la población de países en desarrollo. El objetivo de este informe sobre la alimentación, de reducir a la mitad el número de personas desnutridas, es altamente improbable que se alcance en 2030 (FAO, 2002). La producción acuícola en el continente americano fue de 3,799 toneladas, de las cuales 1,059 toneladas de peces de aleta provinieron de la acuicultura marina y costera (FAO, 2020). En el año 2020, la producción total de la pesca y la acuicultura fue de 214 millones
de toneladas a nivel mundial, 90.3 millones de toneladas provinieron de las pesquerías (una reducción del 4.4 % del volumen total de la pesca), y 122.6 millones de toneladas de la acuicultura (FAO, 2022). La población global está en constante crecimiento y, con ello, la demanda de alimentos.
En 2017, el pescado representó alrededor del 17% de la proteína de origen animal y el 7% de todas las proteínas consumidas en el mundo (CONAPESCA, 2017). De 1961 a 2017, la tasa media de crecimiento anual del consumo de pescado fue de un 3.1%, superando la tasa media de crecimiento anual de la población, además del consumo de otras proteínas de origen animal, excepto la carne de aves de corral, la cual presenta una tasa de
crecimiento anual del 4.7% (FAO, 2020). CONAPESCA (2018) reportó 10.7 toneladas de atún de cultivo, la mayor parte de la piscicultura marina que se desarrolla en México a escala comercial.
La piscicultura marina de Baja California Sur (B.C.S.) se desarrolla debido a que la entidad posee una ubicación geográfica privilegiada, una gran riqueza y diversidad de recursos naturales. Dado lo anterior, es importante conocer acerca de la vigencia de los Permisos de Acuacultura de Fomento (P.A.F.) y Concesiones de Acuacultura Comercial (C.A.C.), con la finalidad de profundizar en los aspectos más relevantes relacionados con el desarrollo, la evolución y el impacto de esta actividad, en virtud de que el cultivo de peces marinos contri-

Las campañas que hace la industria están sujetas a una adecuada selección de especies para la conformación de paquetes biotecnológicos, donde los criterios biológicos, tecnológicos y económicos preseleccionados sean, cada uno, submodelos que generen juntos los modelos de producción con llave en mano.
buye a la seguridad alimentaria de la región y del país, así como a la generación de divisas, el desarrollo regional, la creación de nuevas fuentes de empleo y, con esto, puede contribuir de manera significativa a reducir la presión sobre varios recursos pesqueros de gran importancia comercial.
El territorio de Baja California Sur tiene 73,909.4 km2 que representa el 3.8 % de la superficie del país (INEGI, 2021). Las principales zonas agrícolas se ubican en los Valles de Santo Domingo en el Municipio de Comondú, de Vizcaíno en el municipio de Mulegé, El Carrizal, Los Planes y Todos Santos en el Municipio de La Paz y San José del Cabo en el Municipio de Los Cabos. La actividad agrícola dispone de un potencial de superficie regable de hasta 61,725 hectáreas; sin embargo, en base al volumen de agua concesionado, solo es factible sembrar en promedio 36,000 hectáreas por año (COPLADEBCS, 2017), por lo que se advierte que esta actividad no genera aparentemente impacto negativo en la entidad.
Debido al escenario anterior, la formulación de proyectos productivos en el ámbito de la piscicultura marina es estratégica, por lo que la correcta selección de especies con potencial acuícola, tomando en cuenta los criterios sugeridos por
Polanco et al. (2000) así como de Álvarez-Lajonchere e Ibarra-Castro (2013), sugieren considerar criterios biológicos, tecnológicos y económicos, de tal forma que estos tres temas puedan engranarse con la secuencia adecuada y así generar paquetes biotecnológicos, importantes para la consolidación de modelos acuícolas.
En 1976, con la Secretaría de Pesca, inició en México el cultivo de peces marinos en B.C.S., concretamente en el estero de Santo Domingo (Avilés-Quevedo y Mazón-Suastegui, 1996), investigando con el pámpano (Trachinotus parientesis). En 1990, el Instituto Mexicano de Investigación en Pesca y Acuacultura Sustentables (IMIPAS) desarrolló trabajos a nivel experimental en su planta piloto del Centro Regional de Investigación Pesquera La Paz, B.C.S. (CRIP-La Paz), seguido de varias instituciones de la entidad.
A fines de la década de los noventas e inicios del 2000, el Centro de Investigaciones Biológicas del Noroeste (CIBNOR) comenzó trabajos de investigación en esta área con algunas especies de peces marinos, logrando avances técnicocientíficos en el ámbito de la reproducción en cautiverio con jurel, pez fuerte, Seriola rivoliana, pargo rojo del Pacífico o huachinango,
Lutjanus peru y robalo blanco del Pacífico (Centropomus viridis), empezando el desarrollo industrial de esta actividad. En este estudio se identifica el interés del sector productivo, tanto social como privado, por incursionar en el cultivo de peces marinos en las costas del Pacífico mexicano, siendo predominante B.C.S. (Álvarez-Lajonchere et al., 2006).
La acuicultura en esta zona presenta una tendencia hacia el crecimiento, lo cual no se refleja de la misma manera respecto a las pesquerías. Aun así, es una de las entidades más destacadas por su abundancia y variedad en productos pesqueros, considerando los estragos que empiezan a percibirse en las poblaciones silvestres, debido al excesivo esfuerzo pesquero, el calentamiento global, el aumento de gases de efecto invernadero en la atmósfera, el alto contenido de carbono inorgánico disuelto en el agua superficial, que trae consigo una disminución en el pH, generando la acidificación en el océano, por lo que se complica la disponibilidad de carbonatos para la formación de las carcasas de calcio en el caso de los moluscos, pero también el pH al regular procesos biológicos y químicos, combinado con el aumento de temperatura, derivando en la eutrofización que −por consecuencia−

presenta la desoxigenación, también causada por la combinación de los eventos antes mencionados, entre otros, por Chapa-Balcorta et al. (2016).
Debido al nivel de desarrollo que ha alcanzado la piscicultura marina en B.C.S., se hace indispensable contar con información real y reciente sobre las operaciones comerciales; por lo que el objetivo de este artículo es conocer el comportamiento de la actividad, la expedición de Permisos de Acuacultura de Fomento (P.A.F.) y Concesiones de Acuacultura Comercial (C.A.C.) en el contexto de la piscicultura marina en Baja California Sur.
Material y métodos
Como parte de un proyecto del Programa Operativo Anual (POA) de 2017, dirigido y financiado por la Dirección General de Investigación en Acuacultura (DGAIA) del IMIPAS, se realizaron visitas en las unidades de producción acuícola (UPA) de peces marinos del Estado de Baja California Sur en 2017. También, se visitó un laboratorio de producción de crías de peces marinos en Baja California, ya que, es el proveedor de los sistemas de engorda en B.C.S. en una misma empresa (Figura 1). Se contó con el apoyo en el análisis de información por la Coordinación del Programa de Acuicultura del CIBNOR, referente
al tema de competencias laborales. Se realizaron visitas de orden técnico in situ con el objetivo de catacterizar las UPA. Con el apoyo de la DGAIA-IMIPAS, se revisó la información de datos en fuentes oficiales (SOAP, 2021) y Acuasesor (2021) referente a los permisos y concesiones otorgados desde que iniciaron estos instrumentos, con la finalidad de conocer a través del tiempo, partiendo del inicio de la actividad en comento, el estado que guarda la operación de las UPA de la piscicultura marina en el Estado de Baja California Sur.
En el año 2000, se expidieron los primeros P.A.F., que estarán vigentes hasta este año 2024, para jurel y corvina; sin embargo, esta última especie no se está cultivando en la entidad. Para el caso de las C.A.C. se cuenta con registros desde 1994, resaltando de alguna forma la preferencia por los tunidos y los jureles. Son pocos los P.A.F. y C.A.C. vigentes. Estos permisos como concesiones tienen un tiempo de vigencia que deriva del marco legal, el cual es precisamente para demostrar la viabilidad técnica y financiera (Figura 2).
Las especies de peces marinos que se cultivan actualmente en B.C.S. son jurel de Castilla (Seriola lalandi), esmedregal (Seriola rivo-
liana), totoaba (Totoaba macdonaldi), y pargo rojo del Pacífico (Lutjanus peru), identificadas como las que reúnen atributos acuícolas para desarrollar la tecnología de su cultivo. Por ejemplo, en el caso del jurel (Seriola lalandi), también llamado Hiramasa, Kingfish o Amberjack, las principales características para desarrollar su cultivo fueron las siguientes:
9 Cuenta con mercado.
9 Existe tecnología probada en otros países.
9 Afinidad al país y a la región.
9 Factibilidad para ser llevado a escala comercial.
El análisis del trabajo realizado permitió identificar algunas necesidades periféricas para las UPA, observándose que son específicas de las actividades que desarrollan, algunas de las cuales coinciden. A continuación, se enlistan las necesidades de esta industria:
9 Mantenimiento de reproductores.
9 Producción de alimento vivo.
9 Desarrollar microdietas nacionales (de calidad).
9 Desarrollar línea de investigación para patógenos y su tratamiento (veterinarios en peces marinos).
9 Transporte de peces por mar y tierra: para reproductores y juveniles.

9 Abastecimiento de alimento fresco congelado de buena calidad para los reproductores.
9 Investigación y producción de alimento peletizado nacional para peces marinos.
9 Mayor investigación en enfermedades propias de la especie, y servicios veterinarios, laboratorios de análisis genéticos y bacteriológicos, con equipo necesario para los estudios a nivel nacional.
9 Barcazas más grandes para maniobras de cambio de redes y movimiento de jaulas.
9 Oxígeno disuelto.
9 Proceso del producto.
9 Servicios veterinarios.
9 Listado de profesionales especializados en piscicultura marina.
En referencia al tema de establecer esquema de certificación de competencias laborales para granja, laboratorio u otro (UPA), y base de datos con profesionales en acuicultura, es oportuno señalar que relativamente hace poco tiempo, ha comenzado la formación de profesionales especializados en cultivo de peces marinos en el estado. La Universidad Autónoma de Baja California Sur inició con una carrera sobre Bioingeniería en Acuicultura, la cual estará generando los primeros egresados. Es conveniente contar con un catálogo de
productos ofrecidos por las instituciones, de acuerdo a las necesidades de la industria, el cual es una tarea aún pendiente.
CIBNOR, mediante un proyecto de investigación de cuatro años que ha desarrollado desde el año 2000, logró obtener reproductores nacidos y criados en cautiverio para el caso del pargo colorado del Pacífico L. peru, que incluso sirvieron de pie de cría para que la industria desarrollara un sistema de maduración de reproductores en cautiverio.
Discusión
Considerando las especies que se cultivan en B.C.S., antes mencionadas y tomando en cuenta a Avilés-Quevedo & Mazón-Suastegui (1996) y Lajonchere et al. (2006), se iniciaron trabajos con L. peru, L. guttatus, L. argentivenris, L. aratus y cabrilla P. maculatofasciatus, antes con pámpano (T. parientesis) y se continua los esfuerzos con el pargo rojo del Pacífico (L. peru), estimando los tiempos y la inversión, que es grande, para estabilizar los protocolos de maduración (de 5 a 8 años) y demás procesos (biológicos, tecnológicos y económicos), como los larvarios, maternidades, preengorda, con su respectiva estandarización y homologación de procedimientos hasta cerrar el ciclo.
Las campañas que hace la industria están sujetas a una adecuada selección de especies (Polanco et al., 2000 y Lajonchere e Ibarra, 2013) para la conformación de paquetes biotecnológicos, donde los criterios biológicos, tecnológicos y económicos preseleccionados sean, cada uno, submodelos que generen juntos los modelos de producción con llave en mano.
Estos proyectos avanzan en la entidad, aun cuando no están totalmente integrando los actores que intervienen o deben intervenir en la cadena de valor de esta actividad. Dado que parte de la real importancia de la maricultura (piscicultura marina) de peces marinos radica en bajar la presión sobre la pesca, haciendo uso de prácticas productivas en lugar de extractivas, se debe considerar: el uso de biotecnología para realizar criopreservación y vitrificación, entre otros, para conservar los recursos genéticos sobreexplotados con importancia comercial y ecológica; el bajo o nulo consumo de energía fósil (combustibles y electricidad), sustituyendo fuentes de energías tradicionales por nuevas fuentes de energías renovables que coadyuven a la sustentabilidad como puede ser el uso de la fuerza de las mareas, solar o eólica. También, se deben considerar los análisis de costos para alcanzar la

El cultivo de peces marinos está recibiendo cada vez mayor importancia, atención y debe promoverse y supervisarse para lograr un desarrollo de la bioeconomía respetuoso con el clima y el medioambiente.
eficiencia de la producción, definir las funciones de producción para los diferentes sistemas de cultivo, y los estudios medioambientales pertinentes, como las mareas y corrientes, entre otros.
Conclusiones
Debido a la expansión de la población en la entidad y su vocación turística, la demanda de pescado y productos pesqueros aumentará. Su creciente demanda obliga a utilizar mejor los recursos actuales, lo cual podría dar lugar a que se reduzcan los desechos y se destine más pescado al consumo humano y menos a la elaboración de alimento balanceado. La mayor demanda de pescado se satisfará, principalmente, incrementando la producción del sector acuícola, con el consiguiente aumento de la demanda de alimento balanceado. El cultivo de peces marinos está recibiendo cada vez mayor importancia, atención y debe promoverse y supervisarse para lograr un desarrollo de la bioeconomía respetuoso con el clima y el medioambiente. Se advierte una amplia área de oportunidad para Baja California Sur por las bondades geográficas con que cuenta, la calidad y las características del medioambiente, siendo un medio marino con especies de alto
valor comercial en el ámbito de la escama, oportunidad que vale la pena explorar y desarrollar con la piscicultura marina sustentable. En resumen, en la entidad existen instituciones de investigación superior de excelente nivel que pueden ofrecer servicios de investigación, proveedores de servicios, y áreas de oportunidad para generar nuevas empresas que aporten servicios y generen fuentes de trabajo en una actividad que está produciendo e impactando de manera positiva en el sector alimentario de México. Sin embargo, el país no solo necesita paquetes biotecnológicos completos, también se requiere un mercado nacional sólido, casos de éxito, reducir los riesgos de la actividad, certidumbre jurídica con un marco legal saludable, porque las inversiones están dirigidas a proyectos rentables y las estrategias deben dirigirse a lo que es posible vender.
A la Dirección General de Investigación en Acuacultura del Instituto Mexicano de Investigación en Pesca y Acuacultura Sustentables (IMIPAS), a la M. en C. Sandra Medina Gómez del CRIPA La PazIMIPAS, a la Coordinación del Programa de Acuicultura del Centro de Investigaciones Biológicas del
Noroeste (CIBNOR), al Comité Estatal de Sanidad Acuícola de B.C.S. y a la industria piscícola marina de México.
Las referencias y fuentes consultadas por el autor en la elaboración de este artículo están disponibles bajo petición previa a nuestra redacción.
Víctor Laurencez-Reyes1 , José A. Estrada-Godinez2, Marisela AguilarJuárez2, Ma. del Rosario PachecoMarges2, Deneb Maldonado-García3, Minerva C. Maldonado-García3, Juan C. Lapuente-Landero4
1 Posgrado en Ciencias en Recursos Acuáticos, Facultad de Ciencias del Mar, Universidad Autónoma de Sinaloa. Paseo Claussen s/n Col. Los Pinos, C.P. 82000, Mazatlán, Sinaloa, México. Responsable de la correspondencia: 19941277. laurencez@ms.uas.edu.mx
2 Facultad de Ciencias del Mar, Universidad Autónoma de Sinaloa, Paseo Claussen s/n Col. Los Pinos, C.P. 82000, Mazatlán, Sinaloa, México.
3 Centro de Investigaciones Biológicas del Noroeste A. C., Av. Instituto Politécnico Nacional 195, Playa Palo de Santa Rita Sur; C. P. 23096, La Paz, B.C.S. México.
4 Instituto Mexicano de Investigación en Pesca y Acuacultura Sustentables, Av. México 190, Col. del Carmen, Delegación Coyoacán, C. P. 04100, CDMX.


En el cultivo intensivo de camarón, el consumo de oxígeno es un indicador importante que afecta en gran medida su condición fisiológica como organismo de cría. En este artículo, se presentan los resultados de una investigación cuyo objetivo fue determinar dinámicamente el consumo oxígeno del Litopenaeus vannamei, en cultivo intensivo, así como las variables calidad de agua y crecimiento del camarón, basado en el Modelado de Sistemas Dinámicos.
Por: Redacción PAM*El oxígeno disuelto (OD) es el parámetro de calidad del agua más importante y dinámico en el sistema de cultivo, ya que los organismos aeróbicos del agua necesitan tasas de oxígeno suficientes para los procesos bioquímicos. En principio la solubilidad del oxígeno en los estanques intensivos depende de las condiciones de pH, temperatura, salinidad, turbulencia y parámetros de presión atmosférica. Dinámicamente, la concentración de OD fluctuará debido a procesos biológicos, físicos y químicos. En cultivo intensivo, el camarón es una biota acuática que requiere oxígeno para el proceso de equilibrio bioenergético en su sistema metabólico. La tasa de consumo de oxígeno afecta, en gran medida, el estado de su sistema metabólico durante su crecimiento y desarrollo. Los siguientes resultados derivan de un estudio que tuvo como objetivo medir la dinámica del consumo de oxígeno por camarones en estan-

La tasa de consumo de oxígeno afecta en gran medida el estado del sistema metabólico del camarón durante su crecimiento y desarrollo.
ques intensivos, y su relación con las variables de calidad de agua y crecimiento del camarón.
Metodología
Este estudio se llevó a cabo durante el periodo de cultivo de Litopenaeus vannamei (abril y junio de 2019), en la zona de acuicultura intensiva de la aldea de Bayeman, distrito Tongas, regencia Probolinggo, Indonesia, bajo un diseño de investigación causal ex-post-facto. La recolección de los datos de consumo de oxígeno, crecimiento biológico y calidad de agua, se realizó cada 10 días desde el inicio de la siembra hasta la cosecha.
El cultivo de L. vannamei se llevó a cabo en dos estanques de 400 m², revestidos con polietileno de alta densidad (HDPE, por sus siglas en inglés), con una densidad de población de 112 camarones/ m² y el uso de aireadores de 4 hp en cada estanque. Los datos de tasa de consumo de oxígeno de los organismos se tomaron a partir del muestreo aleatorio de cuatro camarones de cada estanque, los cuales contaban con órganos corporales completos, movimiento activo e intestinos llenos. Luego, se realizaron pruebas experimentales en un tanque de 20 L y un medidor de OD (AZ 8402, China).
La medición de los parámetros de calidad de agua, como pH, temperatura, oxígeno disuelto y salinidad, se llevó a cabo in situ; mientras la de fosfato, nitrito, nitrato, nitrógeno amoniacal total (TAN, por sus siglas en inglés) y materia orgánica total (TOM) se realizó cada 10 días, ex situ, en el laboratorio del BBPAP de Situbondo.
Resultados y discusión
Durante el período de crecimiento, la tasa de consumo de oxígeno del camarón evidenció una tendencia descendente, según el modelo de regresión Y = 9.444 - 0.047x. La mayor tasa de consumo de oxígeno fue de 0.450 mgO2/L, y la menor de 0.002 mgO2/L (Figura 1). Esto significa que cuanto mayor es el peso del camarón, menor es la tasa de demanda de oxígeno, debido a que los camarones pequeños


necesitan mayor energía para su sistema metabólico. Además, la tasa de consumo de oxígeno de los organismos también se ve afectada por condiciones ambientales, como temperatura y salinidad (Bett y Vinatea, 2009). Los resultados de otros estudios confirman que la tasa mínima de consumo de oxígeno para camarones juveniles es de 0.65 mg/L, con un peso medio corporal (ABW, por sus siglas en inglés) de 4.1 g (Vinatea et al., 2009).
En el gráfico ABW vs. ganancia (de peso) media diaria (ADG) del camarón (Figura 2), se observa que el ABW sigue aumentando desde la siembra hasta la cosecha. Sin embargo, la ADG parece experimentar un descenso a los 50 días de cultivo, y después permanece estable. El estancamiento del crecimiento a los 50 días se debe a la elevada densidad de pobla-
ción y biomasa de camarones en los estanques, así como a los bajos niveles de salinidad del agua, los cuales afectan las condiciones biológicas de crecimiento y el equilibrio del sistema de osmorregulación de los organismos (Bray et al., 1994; Sookying et al., 2011; Chand et al., 2015). Estas condiciones también afectarán genéticamente el nivel de producción de la hormona inhibidora de la muda (MIH, por sus siglas en inglés) en cada fase del crecimiento del camarón (Gao et al., 2016).
La tasa de crecimiento del camarón evidencia un comportamiento exponencial con respecto a la edad de 30-50 días. A partir de estos resultados, se espera definir estrategias para estimular el crecimiento del camarón durante este periodo. La ingeniería podría enfocarse en gestionar los hábitos de alimenta-

ción de los organismos y añadir suplementos (Jayesh et al., 2015).
Con base en el análisis de simulación, bajo el concepto de modelado de sistemas dinámicos, se demuestra que el consumo de oxígeno fue lineal a la dinámica de la ADG, e inversamente proporcional a la tasa de aumento de la biomasa de camarón en los estanques (Figura 3). Esto significa que la tasa de consumo de oxígeno experimentará una fluctuación acorde con la tasa de crecimiento del camarón, ya que, durante su crecimiento, fisiológicamente es necesario contar con
niveles de oxígeno suficientes para cumplir con su actividad metabólica. La tasa de oxígeno disuelto requerida para el proceso metabólico del camarón adulto, a una temperatura estable de 28-33°C, es de 1.49 mg/L (Niu et al., 2003).
El aumento de la biomasa de camarón, que se describe como una curva de crecimiento sigmoidal durante el período de cultivo, repercutirá en el aumento del nivel de acumulación de nutrientes, el cual generará un exceso de enriquecimiento del medio acuático del estanque (Wu et al., 2014).
Las aguas ricas con exceso de nutrientes provocarán floraciones de plancton en los estanques y un desequilibrio del ecosistema (Muendo et al., 2014). Estas floraciones también afectarán las condiciones de consumo del plancton en la cadena alimentaria de los estanques.
Según los datos de calidad de agua, la tasa de consumo de oxígeno tiene una estrecha correlación negativa con los parámetros de salinidad y TOM; sin correlacionar con otros parámetros. La relación negativa con la salinidad, indica


Según los datos sobre la calidad de agua, la tasa de consumo de oxígeno tiene una correlación negativa con los parámetros de salinidad y materia orgánica total.
que la fluctuación de iones minerales en los estanques afecta en gran medida la tasa de consumo de oxígeno por el metabolismo del camarón debido a su mecanismo de osmorregulación (Re y Díaz, 2011).
El aumento de la tasa de consumo de oxígeno es una respuesta fisiológica del camarón para mantener una condición corporal, que le permita continuar en una condición homeostática como consecuencia de las fluctuaciones en los niveles de salinidad del agua (Hernandez et al., 2005). Mientras tanto, el aumento de los niveles de materia orgánica a causa del incremento de la biomasa del camarón, afectará el
aumento de la demanda de oxígeno en el sedimento y en la columna de agua para el proceso de respiración de los organismos (Luong et al., 2016; Leduc y Pilditch, 2017).
En cuanto a la variable crecimiento biológico del camarón, la tasa de consumo de oxígeno cuenta con una estrecha relación con el ABW, pero no con la ADG. Esto se debe a que, durante su vida, la tasa de consumo de oxígeno de los camarones, en cada fase de crecimiento o en cada peso corporal, tiene diferentes tasas de demanda de oxígeno (Budiardi et al., 2005).
Los camarones pequeños tienen una mayor propensión al consumo

de oxígeno para su actividad metabólica (Djawad y Jompa, 2002).
Las diferentes tasas de consumo de oxígeno en el sistema metabólico, durante cada etapa de crecimiento de los organismos, también se predicen como respuesta de adaptación fisiológica y conductual (Kieffer and Wakefield, 2009; Bouyoucos et al., 2018).
A partir de los resultados del estudio, se puede concluir que las fluctuaciones dinámicas en el consumo de oxígeno y la ganancia (de peso) media diaria del camarón, en cultivo intensivo, están estrechamente influenciadas por la estabilidad de las condiciones de calidad de agua en su hábitat.
Esta es una versión resumida desarrollada por el equipo editorial de Panorama Acuícola Magazine del artículo “OXYGEN CONSUMPTION OF LITOPENAEUS VANNAMEI IN INTENSIVE PONDS BASED ON THE DYNAMIC MODELING SYSTEM” escrito porWAFI,A.- Universitas Ibrahimy,ARIADI,H.- Universitas Pekalongan,MUQSITH,A.- Universitas Ibrahimy,MAHMUDI,M. and FADJAR,M.Universitas Brawijaya. La versión original, incluyendo tablas y figuras, fue publicada en FEBRERO de 2021 en JOURNAL OF AQUACULTURE AND FISH HEALTH. Se puede acceder a la versión completa a través de 10.20473/jafh.v10i1.18102.

Una de las principales razones por las cuales muchos sistemas de bombeo operan significativamente fuera de su punto de eficiencia óptimo, aumentando su consumo energético y desgastando de forma prematura componentes de los equipos, es que las organizaciones se enfocan en el precio de compra del sistema, en lugar del Costo del Ciclo de Vida del mismo, incluyendo costos operativos y de mantenimiento.
Por: Ing. Raúl Oramas*
Los sectores agrícolas y acuícolas dependen en gran medida de sistemas de bombeo que requieren cantidades significativas de agua. Sin embargo, en muchos casos, la energía eléctrica o el combustible utilizados suelen exceder los requerimientos reales del proceso, lo que resulta en un desperdicio conside-
rable de energía. Este exceso de energía no solo se pierde, sino que también genera vibraciones, ruidos no deseados y un exceso de calor en los componentes del sistema de bombeo. Estos efectos adicionales aumentan los costos de mantenimiento y, a su vez, incrementan significativamente el consumo de combustible o electricidad.
La situación se agrava debido al constante aumento de las tarifas de energía y el costo del combustible, lo que ha encarecido el proceso de bombeo. Como resultado, muchos productores se enfrentan a dificultades para llevar a cabo el riego de sus cultivos y/o la toma de agua para sus procesos acuícolas de manera eficiente y sostenible.
En general, ante una necesidad, existen dos opciones: una económica y práctica a corto plazo, que garantiza el suministro de agua necesario para la aplicación específica; y otra que se centra en costos operativos, confiabilidad, eficiencia y durabilidad.
Las causas más comunes que generan esta problemática son:
9 Equipos de bombeo diseñados para operar en rangos diferentes a los requeridos.
9 Impulsores que están desajustados.
9 Impulsores dañados.
9 Uso de motores sobredimensionados para la aplicación de bombeo.
9 Falta de realización de mantenimientos requeridos.
9 Diferencias en las condiciones de operación.
9 Mala instalación de los sistemas de bombeo.
Conceptos críticos, que ante los ojos de un productor pudieran parecer insignificantes, como el diseño de alturas equivocadas de bombeo, el uso de conductos de sección reducida, el uso inapropiado de equipos diseñados para otra aplicación, pueden resultar en un consumo excesivo de energía. Esto ocurre por la falta de orientación especializada, sobre todo, en la fase inicial de cada proyecto, lo que al final conlleva a generar costos operativos elevados e innecesarios.
Para evitar los escenarios antes mencionados, existe la necesidad de optimizar las condiciones de operación de muchos sistemas de bombeo, con la finalidad de que operen de manera eficiente y confiable en cada proceso.
Tal optimización de los sistemas de bombeo involucra un análisis profundo de cómo todos y cada uno de los componentes del sistema funciona en conjunto. Este proceso de identificación es clave para poder entender y eliminar de manera eficiente las variables que afectan el óptimo desempeño de un sistema de bombeo, reduciendo el consumo energético y mejorando su confiabilidad.
Una de las principales razones por las cuales muchos sistemas de bombeo operan significativamente por fuera de su punto de eficiencia óptimo, aumentando su consumo energético y desgastando de forma prematura componentes de los



equipos, es que las organizaciones se enfocan en el precio de compra del sistema, en lugar del Costo del Ciclo de Vida (LCC, por sus siglas en inglés) del mismo, incluyendo costos operativos y de mantenimiento; sin tener en cuenta que el costo de adquisición de un sistema de bombeo representa apenas un 10% de su costo de vida, mientras que el costo energético equivale a un 40%, mostrando así que el enfoque debe ser analizar de una manera global el proyecto y a un tiempo de vida estimado.
Otros datos que los productores no contemplan, y que hacen parte del LCC de un sistema de bombeo, son: instalación y puesta en marcha equivalente al 7%, costo operativo del 10%, costo de mantenimiento y reparaciones del 25%, costo de downtime o inactividad del 3% y costo por impacto ambiental equivalente al 5%.
Por otro lado, mientras que el ahorro energético es importante, hay otros beneficios relacionados con la optimización de los sistemas de bombeo. Por ejemplo, mayor

Para garantizar el éxito y la efectividad de un proyecto de inversión en sistemas de bombeo, es fundamental contar con el respaldo y la asesoría de una firma especializada en ingeniería de bombeo.
confiabilidad, menor uso y desgaste de componentes, costo de mantenimiento reducido, reducción de pérdidas productivas, incremento de capacidad de utilización y reducción del impacto ambiental. Para justificar un mejoramiento del sistema se deben considerar todos estos elementos, lo que compromete el costo total asociado con la adquisición, operación y mantenimiento durante su ciclo de vida.
La falta de una orientación clara sobre los estándares para el diseño de sistemas de bombeo eficientes permite que firmas de ingeniería genéricas desarrollen proyectos a bajo costo. Sin embargo, aunque estos proyectos cumplan con las especificaciones solicitadas por sus clientes, suelen descuidar la eficiencia energética y los costos a largo plazo para el comprador. Como resultado, el propietario u operador de la bomba se enfrenta a las consecuencias de estas deficiencias. En este sentido, se sugiere buscar la asesoría de empresas expertas para garantizar soluciones óptimas y eficientes.
En general, ante una necesidad, existen dos opciones: una económica y práctica a corto plazo, que garantiza el suministro de agua necesario para la aplicación específica; y otra que se centra en costos operativos, confiabilidad, eficiencia y durabilidad. A menudo, esta última opción, aunque no es la más económica inicialmente, resulta ser la mejor cuando se consideran los costos operativos a largo plazo.
Con la reducción de costos operativos al optimizar los sistemas de bombeo, los productores obtendrán una mayor rentabilidad. Así mismo, al reducir el consumo de energía eléctrica o combustible, cada proyecto contribuirá con la sostenibilidad general del sector y la economía de cada país.
Para garantizar el éxito y la efectividad de un proyecto de inversión en sistemas de bombeo, es fundamental contar con el respaldo y la asesoría de una firma especializada en ingeniería de bombeo. La colaboración con expertos en este campo asegurará que se implementen soluciones óptimas y eficientes
que cumplan con las necesidades específicas del cliente, además de garantizar la maximización de la eficiencia energética y la reducción de costos a largo plazo.
Este enfoque especializado es especialmente relevante en proyectos con el potencial de marcar una diferencia significativa en estos sectores dependientes del bombeo. Al mejorar la eficiencia y la sostenibilidad de los sistemas de bombeo, se puede contribuir en gran medida al desarrollo y la competitividad del sector agrícola y/o acuícola en el país.

es
*Ing. Raúl Oramas Jefe de Zona México ETEC www.etecinternational.com info@etecinternational.com roramas@etecinternational.com


En América del Norte, la industria del rendering juega un papel crucial en la promoción de prácticas sostenibles, especialmente en el sector de la acuicultura. Este artículo explora cómo la transformación de subproductos animales en harinas y aceites está revolucionando la industria de alimentos acuícolas, contribuyendo a la sostenibilidad ambiental y económica.
Por: Redacción de PAM*
El rendering es un proceso industrial que transforma subproductos de la producción animal (como grasa, huesos y sangre) en productos de alto valor como proteínas y grasas. Este proceso ayuda a ges-
tionar eficientemente los residuos y convertir, lo que podría considerarse desperdicio, en ingredientes útiles para diversos sectores, incluida la acuicultura.
Una de las mayores contribuciones de la industria del rendering,
es su impacto ambiental positivo. Al procesar los subproductos animales, la cantidad de desechos que terminarían en vertederos se reduce de manera significativa, lo que a su vez disminuye las emisiones de gases de efecto invernadero.
El uso de productos derivados del rendering en la alimentación acuícola está ganando popularidad, como una alternativa sostenible a las harinas de pescado tradicionales, que a menudo se obtienen de poblaciones de peces salvajes.
Además, el proceso de rendering es responsable de la recuperación anual de aproximadamente 3.7 mil millones de galones de agua, los cuales retornan al medio ambiente de manera segura.
El papel del rendering en la acuicultura sostenible
El uso de productos derivados del rendering en la alimentación acuícola está ganando popularidad, como una alternativa sostenible a las harinas de pescado tradicionales que, a menudo, se obtienen de poblaciones de peces salvajes. Los productos renderizados proporcionan una fuente de proteínas y grasas de alta calidad, las cuales puede reducir la dependencia de los recursos marinos, promoviendo así una acuicultura más sostenible. Los subproductos de la carne usados en la alimentación acuícola son apreciados por su alto contenido de proteínas y la presencia de aminoácidos esenciales, indispensables para el crecimiento y la salud de los peces. Estos ingredientes pueden contener entre un 40% y un 60% de proteína, con una digestibilidad que puede superar el 90%, haciéndolos comparables a otras fuentes de proteínas de alta calidad.
Estos subproductos ofrecen una buena fuente de lípidos, incluidos ácidos grasos esenciales, los cuales son importantes para el desarrollo neurológico y la salud general de los peces. Sin embargo, el perfil de ácidos grasos puede variar, y es necesario ajustar las dietas para asegurar el balance nutricional adecuado.
Manejo de subproductos de la carne para alimentos acuícolas bajo estándares de sanidad
El uso de subproductos de la carne en la alimentación acuícola ofrece una alternativa sostenible y económicamente viable a las fuentes tradicionales, como la harina de pescado. No obstante, su correcto manejo es esencial para garantizar la seguridad y la calidad del alimento final. Este artículo explora las mejores prácticas y estándares
de sanidad en el manejo de subproductos de la carne destinados a la alimentación acuícola.
La implementación de estándares de sanidad adecuados es básica para prevenir la contaminación y asegurar que los subproductos de la carne sean aptos para el consumo acuícola. Estos estándares abarcan procedimientos de higiene, control de temperatura, y medidas de seguridad durante el procesamiento y almacenamiento.
Proceso de higiene y seguridad
1. Recepción y almacenamiento. La recepción de los subproductos debe realizarse en instalaciones que cumplan con las normativas sanitarias. Es clave que estos materiales se almacenen a temperaturas adecuadas para prevenir el crecimiento de bacterias patógenas y la descomposición.
2. Procesamiento. Durante el procesamiento, es fundamental utilizar equipos en buen estado y limpios. Esto incluye la limpieza regular para eliminar residuos de materiales anteriores que pudieran generar contaminación cruzada.
3. Control de temperatura. Mantener los subproductos a temperaturas controladas durante el procesamiento es indispensable para inhibir el crecimiento de microorganismos. La aplicación de calor adecuado durante el proceso de rendering, ayuda a eliminar patógenos potenciales.
4. Evaluación de riesgos. La metodología de Análisis de Peligros y Puntos Críticos de Control (HACCP, por sus siglas en inglés) es un enfoque sistemático para identificar, evaluar y controlar los riesgos sanitarios. La implementación de un plan HACCP es determinante para asegurar la inocuidad de los subproductos procesados.
Normativas y certificaciones
La adhesión a normativas locales e internacionales es vital para la comercialización de subproductos
de la carne en la industria acuícola; implicando certificaciones de procesos que validan el cumplimiento de los estándares de sanidad y calidad requeridos.
Desafíos y perspectivas futuras
A pesar de los beneficios evidentes, la industria del rendering enfrenta desafíos, incluyendo la necesidad de cumplir con regulaciones estrictas y la aceptación del mercado. El futuro del rendering en la producción de alimentos acuícolas depende de la capacidad de la industria para innovar y mejorar continuamente sus procesos, garantizando la seguridad y la calidad del producto final.
La industria del rendering en América del Norte es un pilar fundamental para la sostenibilidad de la producción de alimentos acuícolas. Al transformar eficazmente los subproductos animales en recursos valiosos, esta industria realiza un importante aporte, tanto a la protección ambiental como al fortalecimiento de la economía y al desarrollo social. Con desafíos por superar y oportunidades por aprovechar, el futuro del rendering y su contribución a la acuicultura sostenible, se presenta prometedor.
Este análisis detallado demuestra como el rendering es más que un simple proceso de gestión de residuos; es una iniciativa sustentable que puede jugar un rol significativo en la nutrición global y la protección del medio ambiente. Al avanzar hacia prácticas de producción más sostenibles, la industria del rendering se establece como un modelo a seguir en la economía circular y la sostenibilidad global.

Este artículo es patrocinado por NORTH AMERICAN RENDERERS ASSOCIATION (NARA).
En la búsqueda de una cría de camarones sostenible y eficiente, la industria se enfrenta a numerosos retos, desde la sostenibilidad medioambiental hasta la salud y el crecimiento de los organismos.
MOTIVTM es un producto de fermentación patentado por Cargill® , diseñado para hacer frente a estos problemas. Este artículo profundiza en cómo
MOTIVTM está estableciendo nuevos estándares en los alimentos para camarones, mejorando la respuesta inmune y optimizando el uso de nutrientes para potenciar la energía y el crecimiento.
Por: Panorama Acuícola Magazine*
Afrontar los retos de la industria del camarón
La industria del camarón se enfrenta a varios retos críticos, como brotes de enfermedades, necesidad de fuentes de alimento sostenibles y exigencia de mayores tasas de crecimiento sin comprometer el medio ambiente. Las soluciones tradicionales de alimentación no suelen ofrecer un enfoque equilibrado a estos problemas, por lo que se hace necesaria una solución más innovadora y sostenible.
MOTIVTM: un producto de fermentación patentado
MOTIVTM destaca como una solución innovadora, desarrollada gracias a la tecnología de fermentación patentada por Cargill®. No se trata simplemente de una fuente de proteínas, sino de un macroingrediente diseñado para potenciar los beneficios nutritivos y funcionales de las dietas para camarones. Mediante el uso de cepas específicas de microorganismos, MOTIVTM se produce en un entorno controlado, garantizando una alta calidad y consistencia.
La ciencia detrás de MOTIVTM
El proceso de fermentación patentado que permite la elaboración de MOTIVTM, involucra el cultivo de microorganismos seleccionados
que son beneficiosos para la nutrición del camarón. El resultado es un producto rico en nutrientes esenciales, como aminoácidos, vitaminas y minerales, cruciales para el crecimiento y la salud óptimos del camarón.
MOTIVTM es un concentrado superior de proteína de maíz fermentada, con un impresionante contenido proteínico del 69%, muy bajo en carbohidratos (1.7%), libre de antinutrientes y abundantemente rico en nutrientes beneficiosos para
la salud. El secreto de la eficacia de MOTIVTM es un proceso de fermentación especializado que libera un mayor potencial de la proteína para mejorar el crecimiento, el factor de conversión alimenticia (FCR, por sus siglas en inglés) y la supervivencia, destinado especialmente a favorecer la salud del camarón y superar el estrés y las enfermedades. Por lo tanto, MOTIVTM es una excelente fuente de proteínas funcionales de alta calidad para alimentos de camarones y peces marinos.
MOTIVTM destaca por ser una solución innovadora desarrollada mediante la tecnología de fermentación patentada de Cargill®

El proceso de fermentación también enriquece MOTIVTM con altos niveles de ácidos orgánicos y carotenoides naturales.

En el ámbito de la nutrición acuícola, la fermentación es un proceso crítico que permite a los microorganismos transformar las proteínas en unidades más pequeñas y fáciles de absorber, conocidas como péptidos. MOTIVTM aprovecha este proceso para producir una fuente de proteínas con una digestibilidad superior y un perfil robusto de aminoácidos esenciales, predominantemente presentes en estas cadenas peptídicas. Estos péptidos, especialmente ricos en aminoácidos bioactivos, son muy favorables para el sistema digestivo del camarón, lo que refuerza la salud intestinal, reduce el estrés y tiene efectos antioxidantes, antibacterianos e inmunitarios. El proceso de fermentación también enriquece a MOTIVTM con altos niveles de ácidos orgánicos y carotenoides naturales. Además, la biomasa fermentada resultante actúa como prebiótico, fomentando la proliferación de bacterias intestinales benéficas y suprimiendo las poblaciones patógenas de Vibrio mediante un mecanismo conocido como “quorum sensing”.
Optimizando la acuicultura con MOTIVTM: resultados probados en el crecimiento y la salud del camarón
Comprender la naturaleza intrínseca de los camarones, como organismos rudimentarios, revela su aguda vulnerabilidad al estrés, la cual requiere
una rápida asimilación de nutrientes a partir de su sistema digestivo simple. En cambio, los peces marinos exhiben un voraz apetito carnívoro, por lo que necesitan alimentos compuestos de proteínas altamente concentradas, con un mínimo de carbohidratos y desprovistos de antinutrientes, para la formulación de dietas óptimas. Aquí radica el ingenio de MOTIVTM, un alimento a medida, ideal tanto para camarones como para peces marinos, aclamado por su mínimo contenido de carbohidratos y su ausencia de antinutrientes. Extensas investigaciones y ensayos de campo subrayan la eficacia de MOTIVTM cuando se incorpora entre un 7.5% y un 10.0% en las fórmulas de alimentos para camarones, demostrando mejoras sustanciales en los resultados de crecimiento y salud. Los beneficios demostrados de MOTIVTM para la acuicultura incluyen:
1. Aumento del crecimiento: un notable aumento promedio del 11% en el peso del camarón, junto con una reducción del 8% en el FCR, lo que indica un proceso de crecimiento más eficiente.
2. Mayor tasa de supervivencia: con MOTIVTM, los camarones evidencian un aumento promedio del 4% en las tasas de supervivencia, contribuyendo a lograr cosechas más robustas.
3. Mejora la coloración: un aumento promedio de 1.5 puntos en la escala de color, lo que indica una mejor calidad general y comerciabilidad.
4. Eficiencia en costos de las fábricas de alimentos: la integración de un mínimo de 7.5% de MOTIVTM puede suponer una importante reducción de costos, eliminando la necesidad de 25 ppm de astaxantina y reduciendo los gastos en USD 31.50 por tonelada métrica de alimento.
5. Ahorros adicionales: la misma tasa de inclusión, permite reducir el uso de ácido láctico en 5.4 kg, equivalente a una reducción en costos de USD 8.64 por tonelada métrica de alimento.
La eficacia de MOTIVTM en la formulación de alimentos no solo mejora la salud y el crecimiento de los camarones, sino que también fomenta la eficiencia económica y ecológica, convirtiéndolo en una opción líder para la industria acuícola con visión de futuro.
Mejorar el aprovechamiento de los nutrientes
El uso eficiente de nutrientes en la cría de camarón es fundamental para mejorar las tasas de crecimiento, minimizar el desperdicio de alimento y reducir el impacto ambiental. Los principios fundamen-

tales de la ciencia de la nutrición y la investigación en acuicultura, proporcionan información valiosa acerca de la forma en la cual innovaciones como MOTIVTM pueden abordar estos aspectos.
1. Mejorar la digestibilidad: la clave para un aprovechamiento eficaz de los nutrientes reside en mejorar la digestibilidad del alimento, lo cual requiere la formulación de alimentos que el sistema digestivo del camarón pueda des-
componer y absorber fácilmente. Productos como MOTIVTM están diseñados con este principio en mente, empleando procesos de fermentación para descomponer los nutrientes complejos en formas más accesibles.
2. Optimización de la absorción de nutrientes: más allá de la digestibilidad, la absorción efectiva de nutrientes es crucial. Esto implica descomposición física de los alimentos y procesos bioquímicos que permiten el transporte

y uso de los nutrientes dentro del organismo del camarón. La mejora de las fórmulas de los alimentos tiene por objeto optimizar estos procesos, garantizando que los camarones dispongan de los nutrientes y puedan usarlos eficazmente.
3. Reducir los residuos mediante una nutrición de precisión: la precisión en la formulación del alimento ayuda a ajustar el contenido de nutrientes del alimento a las necesidades específicas del camarón en las distintas fases de su crecimiento, minimizando los residuos y maximizando la eficacia. Este enfoque de nutrición de precisión contribuye a la sostenibilidad de la cría de camarón, al reducir el exceso de nutrientes que puede contribuir a la contaminación del medio ambiente.
4. Beneficios medioambientales y económicos: el uso eficiente de nutrientes aporta importantes beneficios medioambientales. Al reducir el desperdicio de alimento, se minimiza la carga de
Diversas investigaciones y ensayos de campo destacan la eficacia de MOTIVTM cuando se incorpora entre un 7.5% y un 10.0% en las fórmulas de alimentos para camarones, demostrando mejoras sustanciales en el crecimiento y la salud de los organismos.
alimento no consumido y de productos de excreción en el agua, contribuyendo a mejorar la calidad del agua y reducir el impacto en el medio acuático. Desde el punto de vista económico, el mejor uso del alimento se traduce en una reducción de costos por concepto de alimentación por unidad de camarón producido, aumentando la rentabilidad de las operaciones de cultivo.
5. Innovaciones en la tecnología de los alimentos: innovaciones como MOTIVTM, que aprovechan la tecnología de fermentación patentada, desempeñan un papel fundamental en los avances en el uso eficiente de nutrientes. Al aumentar la biodisponibilidad de los nutrientes y mejorar la salud digestiva de los camarones, estas innovaciones ofrecen una vía hacia prácticas acuícolas más sostenibles y productivas.
Más allá de las proteínas: MOTIVTM como macroingrediente MOTIVTM trasciende el papel de fuente convencional de proteínas en los alimentos para camarones. Como macroingrediente, aporta una solución integral a la dieta, ofreciendo beneficios tanto nutritivos como funcionales. Este doble enfoque garantiza que los organismos reciban los nutrientes necesarios para su crecimiento, a la vez que se benefician de una mejor salud y resistencia, allanando el camino hacia el fortalecimiento de la sostenibilidad y la productividad de la cría de camarón.

Innovaciones como MOTIVTM, que aprovechan la tecnología de fermentación patentada, desempeñan un papel fundamental en el uso eficiente de nutrientes.
El innovador enfoque de MOTIVTM para las dietas de camarón, mediante un proceso de fermentación único, ofrece una solución holística a los retos de la industria camaronera. Su impacto en la mejora de la respuesta inmunitaria y el uso de nutrientes promete la producción de organismos más sanos y de crecimiento más rápido, además de contribuir a la sostenibilidad de las prácticas en la cría de camarón. Los hallazgos de la comunidad científica sobre los beneficios de los probióticos en la acuicultura, refuerzan aún más el potencial de estas innovaciones para transformar la
industria, proporcionando una base sólida para la continua exploración y adopción de soluciones avanzadas como MOTIVTM

Referencias
Effects of hydrolysable tannins on the growth performance, total haemocyte counts and lysozyme activity of Pacific white leg shrimp Litopenaeusvannamei.Aquaculture,Fishand Fisheries, 2(2), p. 82-93. DOI: 10.1002/aff2.37


Megasupply, con más de 25 años de experiencia en I+D en tratamientos biológicos de acuicultura, presenta dos soluciones innovadoras. PromegaBiotic-f® OM TABLETA y PromegaBiotic-f® OM PELLET son tratamientos biorremediadores para suelos de piscinas acuícolas. Contienen una combinación sinérgica de probióticos y microorganismos de biorremediación naturales, junto con enzimas y estimulantes de crecimiento bacteriano, que mineralizan el exceso de materia orgánica del fondo de manera efectiva.
Por: Redacción de PAM*
En la actualidad, la acuicultura se ha convertido en una actividad crucial, ofreciendo beneficios que la destacan a nivel mundial. Además de contribuir significativamente a la seguridad alimentaria, al proporcionar proteína animal para la alimentación humana, la actividad acuícola se presenta como una alternativa eficiente a la pesca extractiva cuando se practica de manera sostenible; ayudando a conservar especies y generando empleos en áreas costeras y rurales, impulsando el desarrollo económico y la reducción de la pobreza.

La diversificación de las economías locales y regionales a través de la acuicultura ofrece una fuente de ingresos alternativa a la agricultura, mientras que la cría en cautiverio de especies en peligro de extinción contribuye a la conservación de la biodiversidad. La innovación tecnológica en este campo, como la biotecnología y la gestión ambiental, también es notable. A pesar del crecimiento y los avances, la acuicultura enfrenta desafíos como enfermedades, contaminación y competencia por recursos. Mejorar la gestión y la sostenibilidad ambiental es fundamental para garantizar su crecimiento continuo y su contribución a la seguridad alimentaria y el desarrollo económico.
Problemas en los suelos de las piscinas acuícolas
Los suelos de las piscinas acuícolas pueden presentar varios problemas, especialmente debido a la acumulación de sedimentos y desechos orgánicos. Con el tiempo, los sedimentos pueden acumularse en el fondo de las piscinas acuícolas, lo que puede afectar la calidad del agua y el hábitat de los organismos acuáticos. En el caso de los desechos orgánicos producidos por peces y otros organismos acuáticos, estos pueden depositarse en el
suelo de las piscinas, favoreciendo la proliferación de bacterias y otros microorganismos no deseados. Para abordar tales problemas, es importante realizar un manejo adecuado de los suelos de las piscinas acuícolas, que incluya la limpieza regular de los sedimentos y la implementación de prácticas de cultivo sostenibles que minimicen la acumulación de desechos orgánicos.
Tratamientos biológicos en acuicultura
Los tratamientos biológicos en acuicultura son métodos que utilizan organismos vivos o sus productos para mejorar la calidad del agua, controlar enfermedades, descomponer desechos orgánicos y promover un ambiente saludable para los organismos acuáticos cultivados. Estos tratamientos pueden incluir el uso de bacterias, hongos, protozoos, algas u otros organismos benéficos.
Un ejemplo común de tratamiento biológico es el uso de bacterias nitrificantes, el cual permite convertir el amonio tóxico producido por los desechos de los peces en compuestos menos tóxicos, como nitritos y nitratos. Otro ejemplo, es el uso de bacterias y enzimas para descomponer los desechos orgánicos acumulados en el fondo de las piscinas de cultivo, lo que ayuda a prevenir la acumulación de sedimentos y mejora la calidad del agua.
En el caso específico de PromegaBiotic-f® OM TABLETA y PromegaBiotic-f® OM PELLET, de Megasupply, se refiere a tratamientos biorremediadores que utilizan probióticos y microorganismos altamente eficientes para descomponer los desechos orgánicos en las piscinas acuícolas, mejorando así la calidad del agua y promoviendo un ambiente más saludable para los organismos acuáticos cultivados.
Características de PromegaBiotic-f® OMTABLETA y PromegaBiotic-f® OM PELLET Mientras PromegaBiotic-f® OM TABLETA cuenta con una conveniente presentación de aproximadamente 14 g y 3 cm de diámetro, para aplicar directamente en zonas de acumulación de materia orgánica, PromegaBiotic-f® OM PELLET tiene una presentación de pellets de 5 mm x 5 mm que se puede utilizar en alimentadores automáticos.
Ambos productos, contienen cuatro cepas de microorganismos altamente eficientes, que trabajan en sinergia para producir biorremediación en conjunto con enzimas activadoras y medio de cultivo. Estos microorganismos de biorremediación mineralizan la materia orgánica disuelta en el agua y en el suelo. Además, tienen la capacidad de reducir la presencia de amonio, nitrato, nitrito, metano y sulfuro de hidrógeno disueltos en el agua, al biorremediar su principal fuente. Esta particular característica permite que PromegaBiotic-f® OM PELLET promueva mejoras significativas en el crecimiento, la supervivencia y la resistencia al estrés de camarones y peces cultivados.
Además, el producto PromegaBiotic-f® OM TABLETA reduce las cargas de Vibrio y algas verde-azules en el agua, procurando mejoras significativas en la calidad del agua, el crecimiento, la supervivencia y la resistencia al estrés de camarones y peces criados.
Ambas presentaciones, son eficaces cuando las condiciones ambientales de los cultivos se mantienen entre los siguientes parámetros: salinidad de 0 a 50‰, temperatura de 11 a 39oC y pH entre 5.6 a 10.6. Los productos PromegaBiotic-f® OM TABLETA y PromegaBiotic-f® OM PELLET de Megasupply están compuestos por cepas de microorganismos biorremediadores, nutrientes, enzimas y medio de crecimiento bacteriano. La concentración de bacterias en PromegaBiotic-f® OM TABLETA es de al menos 5 x 109 UFC/g (5 x 1012 UFC/kg), mientras que en PromegaBiotic-f® OM PELLET es de al menos 2.5 x 109 UFC/g (2.5 x 1012 UFC/kg). Se recomienda almacenar ambos productos a temperaturas comprendidas entre 5 y 25°C, evitando temperaturas superiores a 40°C y la congelación, manteniéndolos alejados de la luz solar directa en un área bien ventilada. Para su uso, PromegaBiotic-f® OM TABLETA se aplica de forma manual en el estanque, distribuyendo la dosis en áreas con acumulación de materia orgánica y, opcionalmente, se puede administrar melaza en la laguna después de la aplicación del producto. Las dosis iniciales sugeridas se encuentran en la Tabla 1, las cuales se deben ajustar según las condiciones de cada granja. La vida útil del producto es

Los desechos orgánicos producidos por peces y otros organismos acuáticos pueden acumularse en el suelo de las piscinas, lo que puede provocar la proliferación de bacterias y otros microorganismos no deseados.
de dos años si se almacena manera adecuada. Se comercializa en cajas de 10 kg, tachos plásticos de 1 kg y 10 kg, y bolsas aluminizadas de 1 kg y 250 g cada una.
El producto PromegaBiotic-f® OM PELLET tiene dos opciones de uso. La primera, para alimentadores automáticos, se divide la dosis semanal por alimentador entre 2 o 3 aplicaciones por semana. Se introduce el producto en el depósito del alimentador automático junto con el alimento balanceado y, de forma opcional, se aplica a la piscina de 10 a 25 litros de melaza
por hectárea, luego de 8 a 12 horas de la aplicación del producto. La segunda opción, correspondiente a la aplicación manual, consiste en administrar la dosis al estanque, repartiéndola en las zonas con exceso de acumulación de materia orgánica, pudiendo incluir de 10 a 25 litros de melaza por hectárea de 8 a 12 horas después de la aplicación del producto (opcional). La vida útil del producto es de dos años si se almacena según lo recomendado. Esta presentación se comercializa en bolsas de 10 kg, 1 kg o 250 g cada una. Las dosis ini-


ciales de tratamiento sugeridas se presentan en la Tabla 2.
Conclusión
La empresa Megasupply, con sus soluciones innovadoras para tratamientos biológicos en acuicultura, demuestra cómo la investigación y el desarrollo en este campo pueden abordar los desafíos ambientales y de producción. Sus productos PromegaBiotic-f® OM TABLETA y PromegaBiotic-f® OM PELLET ofrecen soluciones efectivas para mejorar la calidad del suelo y el agua en las piscinas acuícolas, promoviendo un ambiente más saludable para los organismos acuáticos cultivados. Estos avances tecnológicos reflejan el compromiso de la industria acuícola con la sostenibilidad y la eficiencia, allanando el camino para un futuro más prometedor en la producción de alimentos.

Este artículo es patrocinado por MEGASUPPLY.
Esta es una versión resumida desarrollada por el equipo editorial de Panorama Acuícola Magazine del artículo “PROMEGABIOTIC-F® OM PRESENTACIÓN: TABLETA Y PROMEGABIOTIC-F® OM PELLET:TRATAMIENTO BIORREMEDIADOR PARA SUELOS DE PISCINAS ACUÍCOLAS” escrito por MEGASUPPLY. La versión original se puede acceder a través de https://www.megasupply.net/ productos/promegabiotic-f-om-farmmegaremediation/
Este artículo es patrocinado por ZEIGLER


Una estrategia efectiva contra las mortalidades masivas causadas por las infecciones de Vibrio harveyi y Vibrio parahaemolyticus en Penaeus vannamei cultivados.
Por: Rex Ferdinand M. Traifalgar, Rowena E. Cadiz, Emelyn Joy G. Mameloco, Fredson H. Huervana, Carmelo del Castillo, Mark R. Napulan, Ramir Lee y Craig L. Browdy*
El cultivo de Penaeus vannamei es una industria de miles de millones de dólares. Sin embargo, con la intensificación de los sistemas de cultivo para satisfacer la creciente demanda del mercado, el cultivo se enfrenta a desafíos debido a la aparición de patógenos emergentes que amenazan su viabilidad económica y sostenibilidad. Hasta la fecha, la industria ha sufrido graves pérdidas económicas debido a los brotes de
patógenos bacterianos que incluyen Vibrio parahaemolyticus y Vibrio harveyi luminoso. V. parahaemolyticus es conocido como el agente causante del síndrome de mortalidad temprana (EMS, por sus siglas en inglés), técnicamente conocido como enfermedad aguda de necrosis hepatopancreática (AHPND). Esta enfermedad es causada por una cepa de V. parahaemolyticus (VpAHPND) con neurotoxinas de insectos altamente patógenas para los camaro-
nes, la cual se ha asociado con mortalidades masivas en granjas camaroneras en la región de Asia Pacífico. La enfermedad de vibriosis luminosa causada por V. harveyi, un patógeno bacteriano importante en camarones cultivados, causa mortalidades de hasta el 100% en laboratorios y granjas de engorda.
El control eficiente de patógenos bacterianos en peces, con la aplicación de probióticos, está bien establecido. De manera similar, se
La suplementación dietética con probióticos mixtos de Bacillus podría reducir las poblaciones de V. harveyi y V. parahaemolyticus patógenos, disminuir la virulencia de los patógenos y/o mejorar la resistencia de P. vannamei contra estos agentes infecciosos bacterianos.
conocen algunos reportes sobre la aplicación de bacterias probióticas de ácido láctico para controlar infecciones por AHPND en camarones. Sin embargo, la información sobre probióticos efectivos para controlar tanto el patógeno luminoso V. harveyi como VpAPHND es muy limitada o inexistente. Además, la efectividad de un consorcio probiótico aplicado para controlar Vibrio, que causa enfermedades en camarones, no ha sido completamente analizada.
Este artículo describe el trabajo realizado para evaluar la efectividad de una mezcla de probióticos de Bacillus de especies mixtas, para prevenir la infección causada por V. harveyi luminoso y VpAPHND, en juveniles cultivados de P. vannamei.
Ensayo de alimentación
Para evaluar la eficacia de los probióticos de especies mixtas de Bacillus, se realizó una prueba de alimentación empleando grupos
de P. vannamei que se mantuvieron con dietas suplementadas con los probióticos de prueba y un grupo de control que no recibió suplementación de probióticos. En este estudio se analizó una mezcla seleccionada de especies mixtas de Bacillus (RescueTM Zeigler USA), que se conoce por sus propiedades inhibitorias contra el Vibrio
Los juveniles de prueba (1.0 g de peso promedio) se obtuvieron de un laboratorio local en la isla de Panay, Filipinas. El ensayo tuvo cinco tratamientos en triplicado. Los camarones experimentales se distribuyeron aleatoriamente en 15 tanques de plástico, con una capacidad de 135 litros, a una densidad de 80 organismos por tanque. El grupo de tratamiento incluye el control negativo (un grupo), los controles positivos (dos grupos, uno expuesto a V. harveyi y otro a V. parahaemolyticus), y los dos grupos tratados que recibieron dietas suplementadas con RescueTM (uno
expuesto a V. harveyi y otro a V. parahaemolyticus).
El grupo de control negativo se mantuvo con dietas sin suplementación de probióticos y sin exposición a patógenos. El control positivo, se alimentó con dietas sin suplementos de probióticos, pero expuesto a los patógenos V. harveyi y V. parahaemolyticus. Al grupo tratado, se le suministró dietas suplementadas con probióticos y se expuso a los patógenos bacterianos de prueba.
Los organismos experimentales fueron alimentados diariamente con un 10% de su peso corporal. La asignación de alimento se dividió, de forma equitativa, en cuatro raciones (8:00 a.m., 11:00 a.m., 2:00 p.m. y 6:00 p.m.). Antes del inicio de la prueba de exposición al patógeno, los grupos tratados (dos grupos) fueron alimentados con dietas suplementadas con probióticos (RescueTM, 1 g/kg, 109 CFU/kg de alimento), durante 6 días, para iniciar la colonización probiótica en el intestino (Figura 1). Después del período de prealimentación de 6 días, los grupos expuestos a patógenos fueron desafiados solo durante la alimentación de las 8:00 am, con dietas recubiertas con V. harveyi y V. parahaemolyticus a una concentración LC50 de 107 CFU/g de alimento.

La colonización eficiente de Bacillus de RescueTM podría haber reducido las poblaciones intestinales de V. harveyi y V. parahaemolyticus, inhibiendo la infección y/o la patogenicidad en el hepatopáncreas.

Durante el ensayo, se registraron y recolectaron diariamente los camarones muertos en cada grupo experimental, para calcular las tasas de mortalidad entre los grupos de control y los grupos experimentales. El ensayo terminó el día 21, 15 días después de la exposición al patógeno.
Para confirmar el mecanismo de actividad inhibitoria del probiótico al Vibrio, también se realizó un ensayo de inhibición in vitro con la finalidad de evaluar la actividad bactericida contra V. parahaemolyticus y V. harveyi. La actividad bactericida directa del probiótico se evaluó como una zona clara de inhibición cuando el probiótico se colocó en la capa de los patógenos sembrados en un medio sólido. Los resultados se analizaron mediante SPSS16, con un nivel de significancia establecido en 0.05. El conteo bacteriano se transformó logarítmicamente, antes de someterse a un análisis de varianza de un solo factor (ANOVA), para determinar la existencia de diferencias entre los tratamientos para cada periodo de muestreo. Los resultados con diferencias significativas, se sometieron a un análisis post hoc aplicando la Prueba de Tukey.
Inhibición de Vibrio patógeno
Los resultados de este ensayo confirmaron que los probióticos RescueTM exhibieron una potente actividad bactericida contra los patógenos de prueba, V. parahaemolyticus y V. harveyi. La actividad bactericida directa de los probióticos se manifestó como una zona clara de inhibición cuando el probiótico se colocó en la capa de los patógenos sembrados en un medio sólido (Figura 2a y 2b).
Recuento total de Bacillus en el intestino
Los resultados indicaron que, la suplementación dietética de los probióticos de Bacillus de especies mixtas influyó en los recuentos totales de Bacillus en el intestino de los grupos de camarones tratados, en comparación con los grupos de control (Figura 3). En el grupo de tratamiento con RescueTM, los recuentos totales de Bacillus en el intestino de camarones mostraron un aumento significativo a partir del día 3. El aumento significativo en los contenidos de Bacillus en el
La colonización eficiente de los probióticos RescueTM podría haber impedido la entrada de estos patógenos en el hepatopáncreas y/o reducido su patogenicidad, lo que resultó en una supervivencia significativamente mayor en el grupo de tratamiento en comparación con el grupo de control positivo.
intestino, durante la fase inicial de cría, indicó la colonización de los probióticos aplicados. Se sabe que las especies de Bacillus son colonizadoras de la superficie y, también, se sabe que colonizan eficazmente el tracto digestivo de los organismos acuáticos.
Sin embargo, en el presente trabajo, se encontró que el nivel de recuentos de Bacillus en el intestino era similar en todos los grupos de tratamiento en las últimas semanas del ensayo. Los datos sugieren que los Bacillus endógenos también estaban presentes en el intestino de los camarones, específicamente en el grupo de control negativo. Se
sabe que las especies de Bacillus forman la microflora natural del intestino de los organismos acuáticos y se ha documentado que están presentes en el intestino de los camarones. El aumento en los recuentos de Bacillus, en el intestino del grupo de control, podría atribuirse al crecimiento de esta flora bacteriana normal, en respuesta a los nutrientes provenientes de los alimentos.
Menores recuentos totales para V. harveyi y VpAHPND
Los recuentos totales de colonias de V. harveyi en el intestino del grupo tratado con probióticos fueron

menores que en el grupo de control positivo, en todos los períodos de muestreo (Figura 4a). Sin embargo, la diferencia en recuentos no fue estadísticamente significativa entre los tratamientos. La mayor colonización intestinal de Bacillus en el grupo que recibió cepas probióticas mixtas, podría explicar la tendencia hacia recuentos más bajos de V. harveyi luminoso en el intestino de los camarones. No se observó V. harveyi en el intestino del grupo de control negativo.
A diferencia de los recuentos de colonias de V. harveyi en el intestino, los recuentos de colonias de V. parahaemolyticus en el intestino de los camarones fueron similares en todos los tratamientos y no se pudo observar una clara influencia de la adición de probióticos (Figura 4b). Sin embargo, los recuentos de colonias de V. parahaemolyticus en el hepatopáncreas sugirieron que fueron significativamente más bajos en el grupo tratado con probióticos, en casi todos los periodos de muestreo.
Estos datos indican que, la aplicación dietética de la mezcla de probióticos, promovió la colonización activa de los probióticos de Bacillus en el intestino de los camarones y, en efecto, podría haber inhibido las poblaciones de los patógenos V. harveyi y V. parahemolyticus en el mismo.
Eficacia de los probióticos mixtos de Bacillus en la prevención de la mortalidad Los resultados de la prueba de desafío de infección indicaron que el grupo tratado con probióticos RescueTM, mostró una mejora del 33% (Tratado, 60%) en la supervivencia en comparación con el grupo de control (Control, 46%) cuando estuvo expuesto a V. harveyi luminoso infeccioso. De manera similar, la suplementación con los probióticos mixtos de Bacillus mostró un aumento del 40% en la supervivencia (Tratado, 66%) en comparación con el grupo de control (Control, 47%) después
de la exposición a V. parahaemolyticus patógeno (Figura 5).
Esta mejora en la supervivencia podría atribuirse a la eficiente colonización intestinal de las cepas de Bacillus en la mezcla de probióticos, que podría haber inhibido la entrada al tejido intestinal, la infectividad y/o la patogenicidad de V. harveyi luminoso y V. parahaemolyticus causante de AHPND.
La supervivencia, significativamente mayor, observada en los grupos tratados podría estar asociada con los recuentos numéricamente más bajos de los patógenos bacterianos en el intestino de los camarones. Estos resultados podrían respaldar la hipótesis de que la supresión de la patogenicidad de V. harveyi y V. parahaemolyticus, debido a la suplementación con RescueTM, podría estar relacionada con la alta actividad de colonización intestinal, indicada por recuentos más altos de Bacillus en el intestino de los camarones. La colonización eficiente de Bacillus de RescueTM podría haber reducido las poblaciones intestinales de V. harveyi y
V. parahaemolyticus, inhibiendo la infección y/o la patogenicidad en el hepatopáncreas.
El hepatopáncreas se considera el principal tejido objetivo de V. harveyi y V. parahaemolyticus. Se sabe que V. parahaemolyticus manifiesta su patogenicidad al infectar y dañar las células hepatopancreáticas de los camarones. La colonización eficiente de los probióticos RescueTM podría haber impedido la entrada de estos patógenos en el hepatopáncreas y/o reducido su patogenicidad, lo que resultó en una supervivencia significativamente mayor en el grupo de tratamiento en comparación con el grupo de control positivo.
En conjunto, los hallazgos mostraron que la suplementación dietética con probióticos mixtos de Bacillus podría reducir las poblaciones de V. harveyi y V. parahaemolyticus patógenos, disminuir su virulencia y/o mejorar la resistencia de P. vannamei contra estos agentes infecciosos bacterianos. Será necesario realizar investigaciones adicionales para profundizar en el mecanismo el modo de acción de la

reducción observada en la mortalidad. La suplementación dietética de probióticos RescueTM demostró ser un enfoque efectivo de biocontrol para minimizar la mortalidad y las pérdidas económicas asociadas causadas por la vibriosis luminosa y la AHPND en el cultivo comercial de P. vannamei

Este artículo es patrocinado por ZEIGLER BROS., INC.


Rex Ferdinand M. Traifalgar, Ph.D. Profesor y director del Instituto de Acuicultura.

Rowena E. Cadiz y Fredson H. Huervana Instructores en el Instituto de Acuicultura.


Emelyn Joy G. Mameloco Investigadora asociada en el Instituto de Acuicultura.
Carmelo del Castillo, Ph.D. Director en el Instituto Nacional de Biología Molecular y Biotecnología.
Los autores mencionados son del College of Fisheries and Ocean Sciences de la Universidad de Filipinas Visayas



Mark Rowel Napulan Gerente de Ventas para Asia, con base en Filipinas. Correo electrónico: mark. napulan@zeiglerfeed.com
Ramir Lee Gerente Técnico Regional. Correo electrónico: ramir. lee@zeiglerfeed.com
Craig L. Browdy, Ph.D. Director de Investigación y Desarrollo. Correo electrónico: craig. browdy@zeiglerfeed.com
Los autores mencionados pertenecen al College of Fisheries and Ocean Sciences de la Universidad de Filipinas Visayas.




+ Biodisponibilidad Proceso en frío para preservar ingredientes sensibles
+ Digestibilidad y densidad de nutrientes mejorado Tasas de conversión mejoradas



+ Nutrición equilibrada Mayor absorción de lípidos

AquaxcelTM Adapt de Cargill®: revolucionando la nutrición del camarón en América Latina con soluciones adaptativas para mejorar la eficiencia alimenticia y la supervivencia en condiciones desafiantes.
Por: Panorama Acuícola Magazine*
Panorama Acuícola Magazine, líder en cobertura de la industria acuícola en América Latina, ofrece a sus lectores información valiosa sobre tendencias, tecnología y sostenibilidad en acuicultura. Con una trayectoria de casi tres décadas, la revista se ha establecido como una fuente esencial de conocimientos para profesionales y entusiastas de la acuicultura. Este mes, tenemos el placer de presentar una entrevista
exclusiva con expertos de Cargill® , quienes nos hablan sobre su más reciente innovación: AquaxcelTM Adapt, una línea de productos diseñada para optimizar la nutrición y la salud de los camarones en diversas condiciones de cultivo.
Entrevista con Cargill® sobre AquaxcelTM Adapt Panorama Acuícola Magazine: Buen día, y gracias por compartir con nosotros detalles sobre
AquaxcelTM Adapt. ¿Podrían explicarnos qué características innovadoras presenta esta nueva dieta para la producción de camarones? Cargill®: ¡Gracias a ustedes por la oportunidad! AquaxcelTM Adapt es el resultado de nuestro compromiso continuo en abordar necesidades claves en la acuicultura. AquaxcelTM Adapt es una línea de productos que estamos lanzando en Ecuador y México, con la cual buscamos atender diferentes desa-
AquaxcelTM Adapt contribuye a mantener o mejorar los indicadores productivos en condiciones de cultivo desafiantes, por lo que nuestras dietas permiten a las granjas operar de manera más sostenible, alineándose con las expectativas globales y regionales de producción responsable.
fíos que se presentan en el cultivo del camarón y mantener o mejorar su desempeño en estas condiciones retadoras. En Ecuador, por ejemplo, hemos introducido dos especialidades: AquaxcelTM Adapt Osmo y AquaxcelTM Adapt Shock AquaxcelTM Adapt Osmo es la segunda generación de soluciones que funcionan perfectamente en sistemas con desbalance iónico y/o baja salinidad, ideal durante lluvias intensas o cambios de estación.
AquaxcelTM Adapt Shock , por su parte, es eficaz contra eventos bacterianos extracelulares, como la vibriosis, proporcionando una solución integral para los retos del cultivo. Esta última también está siendo lanzada en México.
Panorama Acuícola Magazine: ¿Cómo se ajusta AquaxcelTM Adapt a las diferentes etapas del ciclo de vida del camarón?
Cargill ® : Nuestra línea AquaxcelTM Adapt es muy versátil. Se puede adaptar tanto a la etapa de iniciadores como a la de crecimiento, según las necesidades específicas del productor. Esto permite una aplicación flexible y efectiva, garantizando que los camarones reciban la nutrición adecuada en cada etapa de su desarrollo.
Panorama Acuícola Magazine: ¿Qué mejoras específicas ofrece AquaxcelTM Adapt en comparación con las dietas tradicionales de camarones?
Cargill®: Las dietas AquaxcelTM Adapt han sido diseñadas para ofrecer mejoras en la eficiencia alimenticia y la tasa de supervivencia en condiciones retadoras. En ambientes de baja salinidad y/o desbalance iónico, por ejemplo, AquaxcelTM Adapt Osmo ha mejorado el factor de conversión alimenticia (FCR, por sus siglas en inglés) al menos en un 3% y aumentado la supervivencia alrededor de un 5%.
Con AquaxcelTM Adapt Shock, la mejora se observa principalmente en la supervivencia y en la reducción significativa de la carga

bacteriana en el hepatopáncreas. Hemos observado mejoras en la supervivencia que oscilan entre un 5% y un 10%.
Estos beneficios se traducen en una mayor resistencia al estrés y un mejor desempeño productivo, lo que es fundamental en entornos desafiantes.
Panorama Acuícola Magazine: ¿Podrían compartir algunas experiencias de campo que demuestren la eficacia de AquaxcelTM Adapt en la producción real de camarones?
Cargill® : En Ecuador, con AquaxcelTM Adapt Osmo se ha visto un mejor desempeño del cultivo ante estas condiciones de baja salinidad o de desbalance iónico, mejorando la tasa de supervivencia y la eficiencia alimenticia. Por otra parte, el uso de AquaxcelTM Adapt Shock ha demostrado resultados alentadores en varias granjas, con
mejoras en la supervivencia y una notable reducción en las cargas bacterianas. Estos resultados son un testimonio del impacto positivo que nuestras dietas pueden tener en la producción de camarones.
Panorama Acuícola Magazine: En términos de impacto fisiológico, ¿qué han observado en los camarones alimentados con AquaxcelTM Adapt?
Cargill ® : El concepto de AquaxcelTM Adapt Osmo fue construido buscando solventar los problemas en el sistema de osmorregulación que se ve afectado, especialmente, en situaciones de desbalance de minerales y/o lluvias intensas. El sistema de osmorregulación del camarón es un éxito de la evolución de las decápodas a lo largo de millones de años, que ha permitido al camarón Litopenaeus vannamei adaptarse a un amplio

En campo, estamos viendo que los camarones alimentados con AquaxcelTM Adapt Osmo muestran una mejora en la osmorregulación y la homeostasis.
rango de salinidad. El punto isoosmótico del camarón se encuentra entre 19 a 25 g/L de salinidad. Fuera de ese rango, el organismo se adapta muy bien gracias al sistema de osmorregulación; sin embargo, con un costo inmunológico y fisiológico. Si sumamos a eso el estrés ambiental (lluvias, oxígenos bajos, nitrogenados, toxinas de algas, bacterias, entre otros), el sistema de osmorregulación puede no funcionar adecuadamente.
En ese sentido, nuestra solución significa una evolución en relación con lo que se encuentra hoy en el mercado, porque el concepto Adapt Osmo va más allá que solo adicionar minerales en el alimento. Nuestra solución contempla también la inclusión de nutrientes funcionales que afectan de manera directa e indirecta el sistema de osmorregulación del camarón. Entre los elementos que afectan de forma directa la osmorregulación, además de los minerales que obviamente son importantes, también se encuentran algunos nutrientes funcionales que mejoran la capacidad de osmorregulación del organismo. Por otro lado, tenemos los nutrientes funcionales que están enfocados en disminuir el estrés oxidativo generado por las condiciones de cultivo. Hay una amplia cantidad de literatura científica que apunta cómo elementos que generan estrés al camarón, pueden bloquear la osmorregulación en hasta 100%.
En campo, estamos viendo que los camarones alimentados con AquaxcelTM Adapt Osmo muestran una mejora en la osmorregulación y la homeostasis. Esta capacidad mejorada para manejar el estrés ambiental y fisiológico se traduce directamente en mejor salud, mayores tasas de crecimiento y menos organismos acalambrados.
En el caso de AquaxcelTM Adapt Shock, el resultado final es que reduce la infección por bacterias extracelulares en el hepatopáncreas, al mismo tiempo que produce una regeneración del tejido hepático, manteniendo una correcta asimilación y aprovechamiento de nutrientes. Eso se debe a que Adapt Shock es un paquete diseñado para tratamiento de enfermedades bacterianas extracelulares, el cual combina aditivos funcionales con efecto bactericida y bacteriostático, elementos que refuerzan la inmunidad del camarón y, finalmente, elementos que ayudan en la recuperación del tejido hepático.
Panorama Acuícola Magazine: Por último, ¿cómo contribuye AquaxcelTM Adapt a mejorar la sostenibilidad y la eficiencia en las granjas de camarones?
Cargill®: AquaxcelTM Adapt contribuye a mantener o mejorar los indicadores productivos en condiciones de cultivo desafiantes, por lo que nuestras dietas permiten a las granjas operar de manera
más sostenible, alineándose con las expectativas globales y regionales de producción responsable.
Conclusión
AquaxcelTM Adapt se perfila como una solución revolucionaria para la industria acuícola en América Latina, ofreciendo beneficios tangibles, tanto en términos de mejora en la salud y crecimiento de los camarones como en la sostenibilidad de las prácticas de cultivo, a través de su capacidad para adaptarse a condiciones específicas y desafiantes. AquaxcelTM Adapt está marcando un nuevo camino hacia un futuro más resiliente y productivo en la acuicultura. Las granjas que adopten estas soluciones innovadoras no solo verán mejoras en la rentabilidad y en la gestión ambiental, sino que también estarán a la vanguardia en la adopción de tecnologías que respetan y potencian los ecosistemas acuícolas.

Este artículo es patrocinado por CARGILL.
Para mayor información acerca de AquaxcelTM Adapt, consultar: www.aquaxcel.com https://www.facebook.com/ AquaxcelGlobal
La industria acuícola continúa enfrentando desafíos significativos relacionados con la salud y la productividad de los camarones, particularmente en lo que respecta a las infecciones bacterianas extracelulares. En respuesta a estos retos, se han realizado pruebas en campo con la dieta AquaxcelTM Adapt Shock de Cargill®, diseñada para combatir eficazmente las cargas bacterianas en entornos de cultivo. Los resultados de estas pruebas ofrecen una visión comprensiva del impacto y eficacia de esta solución innovadora.
Metodología de las pruebas
Las pruebas se llevaron a cabo en dos localidades diferentes, evaluando múltiples variables como la calidad del agua y la microbiología de suelo, agua y camarón. Se analizaron muestras de seis piscinas, con diez camarones por piscina, en intervalos de tiempo 0, 5 y 10 días. El objetivo principal fue reducir significativamente las cargas bacterianas, apuntando a una disminución de mínimo una exponencial (por ejemplo 104 a 103).
Resultados en campo de reducción del conteo de vibrios en el hepatopáncreas del camarón
El análisis de las muestras de camarón reflejó una disminución notable en la carga bacteriana, especialmente en las piscinas tratadas con AquaxcelTM Adapt Shock (Figura 1).
En la Localidad 1, los resultados mostraron una tendencia positiva en la reducción de vibrios totales (colonias sacarosa positiva y negativa) en el hepatopáncreas de los organismos analizados, lo que indica una mejora en la calidad general de la salud de los camarones (Figura 2).
En la Localidad 2, así como en la Localidad 1, se observó una disminución en el conteo total de vibrios (colonias sacarosa positiva y negativas) en el tiempo, reafirmando la efectividad de AquaxcelTM Adapt Shock en diferentes condiciones ambientales y de cultivo (Figura 3).
Las pruebas de campo de AquaxcelTM Adapt Shock han demostrado ser exitosas en la reducción de las cargas bacterianas en hepatopáncreas, mejorando signi-




ficativamente la salud de los camarones. Estos resultados no solo validan la efectividad de la dieta en diferentes condiciones y localidades, sino que también ofrecen una promesa considerable para su implementación a mayor escala en la industria acuícola de América Latina.
La adopción de AquaxcelTM Adapt Shock puede significar un cambio sustancial en la manera como los productores gestionan la salud de los camarones, llevando a prácticas más sostenibles y económicamente viables. Con la continua retroalimentación y el soporte técnico proporcionado por Cargill®, los productores están mejor equipados para enfrentar los desafíos del cultivo de camarones en el futuro.
Manteniendo el alto performance del cultivo en estas condiciones retadoras.
Phodé ha aprovechado su experiencia en la industria para lanzar una nueva línea de productos para acuicultura: la línea Olpheel. Especialmente formulado para camarones, Olpheel Good permite aumentar la eficiencia del consumo de alimento y reducir el estrés, arrojando resultados muy prometedores en laboratorios de Ecuador y confirmados en condiciones intensivas en laboratorios en los estados de Sonora y Sinaloa, México.
Por: Amine Chaabane*
En nuestro artículo anterior, destacamos la relevancia del manejo de la fase larvaria en la producción de camarón, mencionando su impacto sobre las etapas subsecuentes, y las diversas estrategias de manejo existentes para mejorar la productividad de los laboratorios. Por lo general, esta se mide a través de indicadores como alta talla/peso de organismos y altos
niveles de supervivencia, permitiendo obtener una biomasa óptima con un beneficio económico importante para los acuicultores.
Mejorar el crecimiento
El principal enfoque para mejorar el crecimiento del camarón es su alimentación. Hoy día, los avances relacionados con la nutrición de sus larvas han permitido generar estrategias de alimentación com-
plejas con alimento vivo o seco. En alimentación balanceada seca, se están desarrollando nuevas tecnologías de fabricación de alimentos de pequeño tamaño (por ejemplo, microextruidos), o encapsulación de ingredientes activos, mejorando significativamente la eficiencia de las estrategias de alimentación en laboratorios de larvas.
Sin embargo, optimizar el aspecto nutricional de un alimento no es

Olpheel Good está diseñado para camarones, con el objetivo de aumentar la eficiencia del consumo de alimento y reducir el estrés, arrojando resultados muy prometedores en laboratorios de Ecuador.

suficiente para aprovechar sus beneficios. En efecto, asegurarse de que una buena cantidad de alimento sea ingerida por cada larva es imperativo. Situaciones de subalimentación pueden llevar a comportamientos de canibalismo, resultando en mutilación de individuos y mortalidad. Por el contrario, una situación de sobrealimentación conduce, con demasiada frecuencia, a deterioro de la calidad del agua y aumento de la materia orgánica en los estanques, favoreciendo el crecimiento de microorganismos, los cuales pueden ser potencialmente patógenos.
En opinión de los productores, los patógenos son la principal causa de mortalidad. Brotes de enfermedades pueden aniquilar un ciclo entero de producción de camarón, tanto en larvas como en engorda. El camarón es un organismo invertebrado que dispone de un sistema inmunitario innato, con mecanismos automáticos de defensa en presencia de un patógeno. Sin embargo, no dispone de un sistema inmunitario adaptativo, tal como en los vertebrados (respuesta específica a un agente externo por aprendizaje tras contacto anterior).
En presencia de una carga bacteriana alta y cepas patógenas, el equilibrio entre presión bacteriana y defensas se rompe, desencadenando enfermedades de distintos tipos. Se suele olvidar que los patógenos están naturalmente presentes en el agua, y que la infección del camarón solo ocurre en estas situaciones de desequilibrio, favorecidas por mal manejo y deterioro de la calidad del agua, por ejemplo, causada por alimento no consumido en lixiviación.
A pesar de todas las innovaciones vinculadas a nutrición y prevención de enfermedades, muchos laboratorios siguen con problemas de crecimiento y baja supervivencia al momento de la cosecha, reduciendo la productividad y rentabilidad de su sistema, impidiendo llegar al potencial esperado. Entre las causas se encuentra un aspecto subestimado del manejo, como lo es la generación de estrés. El estrés consiste en la respuesta de un organismo a un estímulo externo imprevisto, desconocido e incontrolable, para la cual va a “movilizar” su metabolismo con el fin de producir y usar energía. Al emplear esta energía para responder al estrés, disminuye la capacidad del camarón para atender sus otras necesidades, como homeos-
tasis, crecimiento y funcionamiento del sistema inmune. De esta manera, los organismos más frágiles, por la falta de energía, están más expuestos a enfermedades, cansancio y, en consecuencia, mortalidad. Además, si el camarón no consume la cantidad suficiente de alimento, no contará con la energía requerida para enfrentar esta situación.
Manejar ambos aspectos, consumo de alimento y estrés, es una obligación para cualquier sistema de producción que desea llegar a altos nivel de supervivencia. Estos parámetros, que al inicio parecen muy distintos, en realidad se manejan por la misma vía.
El estrés, como mensaje cerebral para generar una respuesta fisiológica, tiene la misma cadena de señalización hormonal que el mensaje

En ambas fases, larvaria y maternidad, la reducción del estrés se tradujo en mejoras significativas (p < 0.05) en la supervivencia global de los estanques tratados con Olpheel Good, en comparación con los estanques de control, en el estudio realizado en el laboratorio de Sonora.
del apetito. Así, a nivel cerebral, no se pueden activar o combinar estos dos mensajes simultáneamente; es decir, un camarón en un estado de estrés no genera mensajes de apetito y un organismo con apetito en un momento “x”, no se estresa de forma fácil. Este vínculo existe, tanto en animales como en seres humanos, y a pesar de no tener un sistema cerebral desarrollado como otros animales de producción, también se aplica al camarón.
Los Laboratorios Phodé, expertos de la olfacción en seres vivos y su efecto a nivel cerebral sobre el bienestar, han estudiado esta relación durante años para diseñar productos que actúan en ese sentido. La tecnología Phodé se ha puesto en práctica en laboratorios del Ecuador, particularmente en granjas camaroneras.
Phodé ha aprovechado su experiencia en la industria para lanzar una nueva línea de productos para acuicultura: la línea Olpheel Especialmente formulado para camarones, Olpheel Good permite aumentar la eficiencia del consumo de alimento y reducir el estrés, arrojando resultados muy prometedores en laboratorios de Ecuador.
En su compromiso por la calidad de sus productos, Phodé continúa profundizando sus investigaciones dirigidas a validar el efecto del producto en condiciones más intensas, a través de la realización de varios estudios en laboratorios de México, en los estados de Sonora y Sinaloa.
Estudio en laboratorio de Sonora
El primer estudio realizado tuvo el objetivo de evaluar el efecto antiestrés del producto y su impacto sobre niveles de supervivencia larvaria. Los camarones empleados en la investigación se encontraban en estado larvario, los cuales se mantuvieron en salas de larvas y maternidades de una empresa comercial productora de larvas de camarón en Sonora, en las condiciones y el manejo de acuerdo con los protocolos comerciales de la empresa, durante los 45 días del ensayo.



Se tomaron muestras de los organismos y se analizaron para medir concentraciones de metabolitos (lactato) y parámetros productivos promedios. En cada fase, se usaron tres estanques por cada tratamiento (control negativo y tratamiento con Olpheel Good).
Al final de la fase larvaria y al final de la prueba en maternidades, se tomaron muestras de las larvas para medir el nivel promedio de lactato en cada tratamiento (Figura 1). El lactato es uno de los indicadores más conocidos del estrés en camarón. Al final de la fase larvaria,
En el laboratorio de Sinaloa, las postlarvas tratadas con Olpheel Good registraron un nivel de lactato más bajo, con aumento más controlado, en comparación con los tanques de control, indicando que estuvieron menos impactadas por el estrés durante producción.

se observó una diferencia significativa (p < 0.05) en cuanto a lactato entre los tanques control (con nivel más alto) y los tanques con Olpheel Good. Esta diferencia se mantuvo en el tiempo, presentando un incremento más alto del lactato en los estanques de control en maternidad, en comparación con los estanques con Olpheel Good. Estos resultados indicaron un efecto antiestrés continuo del producto, comprobado a nivel fisiológico.
En ambas fases, larvaria y maternidad, esta reducción del estrés se tradujo en mejoras significativas (p < 0.05) en la supervivencia global de los estanques tratados con Olpheel Good (Figura 2), en comparación con los estanques de control. En la fase larvaria, la supervivencia aumentó en 16.8 puntos, y 3.8 puntos en maternidad, lo que representó un importante beneficio económico para el productor.
Estudio en laboratorio de Sinaloa
Para corroborar esos resultados, se hizo otro estudio en un laboratorio comercial del estado de Sinaloa, en condiciones ambientales diferentes a las del estado de Sonora (mayor temperatura del agua). Esta
investigación se enfocó en la fase de maternidad.
Se realizó la medición diaria del nivel de lactato en los tanques de control y los tratados con Olpheel Good. Se observó una diferencia significativa (p < 0.05) en los niveles de lactato en las postlarvas (PL), las tratadas con Olpheel Good registraron un nivel más bajo, con aumento más controlado, en comparación con los tanques de control (Figura 3), indicando que las PL con Olpheel Good estuvieron menos impactadas por el estrés durante producción.
Al final de la prueba, se midió el peso individual promedio de las PL en ambos grupos. Se evidenció un aumento significativo del peso en el grupo Olpheel Good (p < 0.05), con larvas de 26.0 mg, en contraste con 20.9 mg promedio en el control. Esta ganancia de peso puede ser debida a un mejor consumo del alimento, tras la estimulación del apetito de Olpheel Good y reducción del estrés, permitiendo a las PL enfocarse en comer y a su metabolismo en crecer.
Conclusión
Estas dos pruebas realizadas en México arrojaron resultados consistentes y similares a los observados
en laboratorios en Ecuador, confirmando la importancia del producto neurosensorial, Olpheel Good, para mejorar la productividad de laboratorios de larvas, tras estimulación del apetito de los organismos y reducción del estrés, resultando en mayores tasas de supervivencia y ganancia de peso. Este vínculo entre apetito y estrés se aplica en todas etapas de la producción de camarón, y es esencial para optimizar su manejo productivo.
Este artículo es patrocinado por: LABORATOIRES PHODÉ.
Laboratoires Phodé, France
Animal Care Customer service: customerAC@phode.com
www.phode.com/en/olpheel/

Lo que comenzó como una pequeña empresa de software se ha convertido en aquaManager, una potencia mundial que ofrece una amplia gama de soluciones de última generación. Presentamos un ecosistema único que integra software de gestión, soluciones IoT, inteligencia empresarial, dispositivos inteligentes y herramientas de IA, con el objetivo de lograr una producción acuícola sostenible y respetuosa con el medio ambiente.
Por: aquaManager*
En el bullicioso corazón de Atenas, capital de Grecia, aquaManager lleva dos décadas impulsando la industria de la acuicultura hacia un éxito sin precedentes. Lo que comenzó como una pequeña empresa de software en una tranquila isla, se ha convertido en una potencia mundial que ofrece una amplia gama de soluciones de última generación.
La historia: dos décadas de excelencia en acuicultura
Los inicios
El viaje de aquaManager comenzó hace dos décadas, en una pequeña isla de Grecia. Aunque la idea inicial parecía simple, el desarrollo de la primera versión de aquaManager exigió casi dos años de dedicación y perseverancia. A pesar de los desafíos, esta versión inicial llamó la atención y atrajo a clientes deseosos de unirse a la familia. En lugar de dormirse en los laureles, el equipo trabajó sin descanso en la siguiente versión de aquaManager, introduciendo hardware para complementar sus servicios de software.
Elpresente
En la actualidad, el ecosistema de aquaManager abarca 55 países, lo que demuestra el impacto global de sus soluciones. El equipo aquaManager colabora estrechamente con sus clientes, desarrollando y perfeccionando soluciones a medida, para el beneficio tanto de sus negocios como del medioambiente.
Nuestra visión de la sostenibilidad
La sostenibilidad está en el centro de la ética de aquaManager, como
proveedor mundial de tecnología para la industria acuícola. Para aquaManager, la sostenibilidad consiste en preservar los recursos no renovables del planeta, garantizar su aprovechamiento responsable y brindar oportunidades a las generaciones futuras.
Dado que la demanda de productos del mar, sanos y nutritivos, sigue aumentando en todo el mundo, aquaManager reconoce que la acuicultura es uno de los métodos de producción de alimentos más respetuosos con el medio ambiente.

La empresa se ha comprometido a garantizar que la industria alcance su máximo potencial de sostenibilidad, contribuyendo a la gestión responsable de los recursos y al bienestar general de nuestro planeta. Así, aquaManager se sitúa a la vanguardia, impulsando al sector acuícola hacia un futuro en el que la excelencia se une a la responsabilidad medioambiental.
aquaManager en América Latina
En el apasionante panorama de América Latina, aquaManager ha establecido firmemente su presencia desde hace varios años, demostrando su compromiso con el crecimiento y el éxito de la acuicultura. Nuestro departamento hispanohablante, experto en atender las necesidades específicas del mercado latinoamericano, ha sido fundamental para fomentar la colaboración con empresas de renombre en distintos países. Nos enorgullece haber colaborado con gigantes del sector como Regal Springs, Spring Genetics, Martec, Promarisco del Grupo Nueva Pescanova, Ecosac, Forever Oceans y muchos otros, contribuyendo al avance de la piscicultura y la camaronicultura en México, Costa Rica, Colombia, Honduras, Perú y otros países.
En esta oportunidad, nos complace presentar nuestro ecosistema único, el cual integra software de gestión, soluciones de internet de las cosas (IoT, por sus siglas en inglés), inteligencia empresarial, dispositivos inteligentes y herramientas de inteligencia artificial (IA) de nueva generación. Todo ello, con el objetivo de capacitar, tanto a las empresas de cultivo de peces como de camarón, con el fin de optimizar la productividad, controlar y reducir costos, mejorar la calidad y alcanzar una producción sostenible y respetuosa con el medio ambiente.
Software de gestión
Módulo Engorde
El módulo Engorde de aquaManager es un ejemplo de innovación en las operaciones de piscicultura y camaronicultura. Los datos en tiempo real y los controles inteligentes suponen una ventaja competitiva que permite a los productores optimizar la eficiencia alimentaria, reducir los costos operativos y aumentar


la rentabilidad. El análisis detallado de costos, la gestión de inventarios y los informes detallados, son herramientas que contribuyen a la toma decisiones informadas para lograr el éxito de las empresas acuícolas. Este módulo es la clave para mejorar la gestión de la acuicultura.
Módulo Hatchery
El módulo Hatchery de aquaManager es una solución de software avanzada que agiliza la gestión y aumenta la eficiencia, representando una gran oportunidad para optimizar las operaciones de laboratorios de camarón y peces. Desde los reproductores hasta la gestión de alimento vivo, pasando por la cría de larvas y el vivero, aquaManager garantiza una trazabilidad completa. Los principales objetivos de este software son: monitorear con precisión la gestión de los reproductores, garantizar el seguimiento de la cantidad de alimento vivo y optimizar la cría de larvas. Las herramientas de planificación y programación mejoran la producción y la rentabilidad, mientras que el seguimiento integral de costos y la gestión de inventarios son
el impulso de las operaciones de Hatchery.
Aplicaciones móviles para la gestión remota
Pensando en los acuicultores, aquaManager amplía su alcance con aplicaciones móviles para los módulos Engorde y Hatchery. Estas aplicaciones brindan acceso en tiempo real a datos fundamentales, lo que permite a los usuarios supervisar y gestionar sus operaciones acuícolas en cualquier momento y desde cualquier lugar. Ya sea que se trate de ajustar las tablas de alimentación, revisar el estado del inventario o analizar los informes de productividad, las aplicaciones móviles de aquaManager llevan a la palma de la mano el poder de la gestión remota.
Inteligencia empresarial
Liberando el poder de los datos
Las soluciones de Business Intelligence (BI) de aquaManager redefinen el análisis de datos. Al crear sistemas que integran y comparten información en toda la empresa, aquaManager hace uso de bases de datos, procesamiento de datos en línea (OLAP, por sus

Las soluciones inteligentes de aquaManager permiten convertir los datos en conocimientos que potencian la productividad.
siglas en inglés) e informes Power BI. Esta información se presenta a la gerencia a través de dashboards e informes interactivos, facilitando la toma de decisiones fundamentadas para alcanzar mayores niveles de control de la gestión, optimizando el crecimiento y la eficiencia del rendimiento.
Tecnología OLAP para un análisis más profundo La tecnología OLAP de aquaManager, permite realizar análisis de datos más detallados y rápidos, sin necesidad de cargar bases de datos transaccionales. Los indicadores clave de la gestión (KPI, por sus siglas en inglés) se calculan a nivel de cubo, garantizando un “único punto de verdad”. Los usuarios de diferentes niveles pueden generar sus propios informes, garantizando que todos en la empresa hablen el mismo idioma. El equipo de BI de aquaManager se dedica a brindar asistencia durante todo el proceso de implantación y uso permanente de la solución BI, garantizando una rápida obtención de valor. Los expertos en BI también le ayudarán a realizar el análisis y le proporcionarán información para maximizar los beneficios derivados de sus datos.
Dashboards personalizados para necesidades empresariales exclusivas Junto con el equipo de aquaManager, podrá crear dashboards a medida que no solo visualicen sus datos, sino que le ayuden a utili-
zarlos para satisfacer sus necesidades empresariales exclusivas y precisas. Los dashboards e informes interactivos permiten a los usuarios, de todos los niveles, tomar decisiones fundamentadas, fomentando una cultura en la que todos los miembros de la organización están alineados y hablan el mismo lenguaje para la toma de decisiones basada en datos.
Inteligencia artificial
BlueMiner: reduciendo la brecha de conocimientos
Ya es posible sumergirse en el futuro de la acuicultura con las soluciones de IA de aquaManager, que incluyen la innovadora plataforma BlueMiner. Libere todo el potencial de sus datos, tome decisiones más inteligentes y aumente el rendimiento. BlueMiner reduce las lagunas de conocimiento en un sector repleto de datos. La evaluación proactiva de insumos, proveedores, hatcheries y estrategias, es posible gracias a las capacidades de la minería de datos. Al simplificar el análisis predictivo con herramientas interactivas, BlueMiner evalúa el impacto de los parámetros de entrada en el rendimiento, generando tablas con resultados de importancia crucial para la acuicultura.
Herramientas de IA de nueva generación
Una nueva era de herramientas de IA, desarrolladas por aquaManager, permite liberar todo el valor de los datos para tomar decisiones más inteligentes, aumentar el rendimiento y mejorar la eficiencia en la


gestión de la producción acuícola. Comúnmente se acepta la idea de que la acuicultura está inundada de datos, pero hambrienta de conocimientos. Las soluciones inteligentes de aquaManager permiten convertir los datos en conocimientos que potencian la productividad. Las imágenes de gran definición, generadas por nuestras cámaras AquaVision, sirven de base para algoritmos avanzados de detección. Estos algoritmos identifican los pellets de alimento, no consumidos por los peces, y analizan los patrones de comportamiento natatorio. El sistema facilita la toma de decisiones sobre los protocolos de alimentación y puede generar señales para controlar los sistemas de alimentación, ofreciendo un enfoque revolucionario de la gestión de la acuicultura.



La gestión eficiente de los equipos es primordial en acuicultura. El sistema iMaint de aquaManager mejora las operaciones de mantenimiento, reduce incidencias y tiempos de inactividad de los equipos, optimiza el rendimiento y racionaliza el uso de los recursos. También está disponible una versión especializada para la gestión de redes.
El registro flexible de datos y la plataforma IoT de aquaManager aportan la potencia del IoT a las operaciones acuícolas, recopilan y procesan datos en tiempo real y permiten a los acuicultores tomar decisiones basadas en hechos y supervisar las condiciones medioambientales. Aumentar la sostenibilidad, la eficiencia y la optimización de recursos, ya es posible con los equipos inteligentes y las soluciones IoT de aquaManager. Mientras continuamos nuestros esfuerzos de expansión en este dinámico mercado, aquaManager le invita a explorar nuestras innovado-
ras soluciones para la industria acuícola, a través de atractivas campañas y ofertas exclusivas para América Latina. Si desea información directa y personalizada, nuestro departamento de habla hispana está a su disposición para ayudarle a alcanzar la excelencia en acuicultura.


Las soluciones de base microbiana, suplementadas en el alimento o en el estanque, han despertado el interés en la acuicultura, debido a sus ventajas potenciales en la producción de camarones y peces. Hemos preguntado a los expertos Stéphane Ralite, director de Aplicaciones para Camarones de Lallemand Animal Nutrition, y François Cellier, director técnico de Acuicultura en LATAM, acerca de cómo puede ayudar, en la práctica, el mundo microbiano a la cría de camarón.
Por: Lallemand Animal Nutrition*
En América Latina y Asia, la acuicultura del camarón está preparada para una evolución significativa en los próximos años, impulsada por los avances tecnológicos. La industria ha sido testigo de un crecimiento sustancial en la última década, con países como Ecuador experimentando una tasa de crecimiento del 25% anual, desde 2020 hasta el segundo trimestre de 2023 (WAS, 2023). Asia sigue siendo un actor dominante, con China y Vietnam absorbiendo gran parte del aumento de la producción. Las innovaciones en tecnología acuícola varían según las regiones, desde sistemas extensivos en Ecuador hasta sistemas superintensivos en Vietnam o Tailandia, lo que indica un enfoque diverso para maximizar el rendimiento y la sostenibilidad. A medida que el sector afronte estos retos, factores como el costo de alimentos, los precios de mercado y la gestión de las enfermedades, determinarán su trayectoria en los años por venir.
Las soluciones de base microbiana, suplementadas en el alimento o en el estanque, han despertado el interés en la acuicultura, debido a sus ventajas potenciales en la producción de camarones y peces.
Hemos preguntado a los expertos Stéphane Ralite, director de Aplicaciones para Camarones de Lallemand Animal Nutrition, con una amplia experiencia en diferentes países asiáticos, y François Cellier, director técnico de Acuicultura en LATAM, cómo el mundo microbiano puede ayudar, en la práctica, a la cría de camarón.

1. ¿Por qué debemos considerar la gestión microbiana en la cría de camarón?
S. Ralite: Los microorganismos desempeñan un papel importante en el éxito de la cría de camarón. En primer lugar, los microorganismos del intestino son esenciales y cumplen múltiples funciones relacionadas


con la digestión y la salud general de los camarones: previenen el crecimiento de bacterias patógenas, regulan la respuesta inmunitaria, contribuyen a la absorción de nutrientes, regularizan la digestión y los procesos metabólicos, y permiten sintetizar vitaminas. En segundo lugar, el agua y el suelo de los estanques también albergan ecosistemas microbianos que son fundamentales en el proceso de recuperación de nutrientes y, más específicamente, en el control del nitrógeno.
2. ¿Podemos actuar sobre la microbiota del agua y del suelo?
S. Ralite: Sí, totalmente, y este es el papel de la biorremediación. La adición de bacterias seleccionadas directamente al agua mejora estos ecosistemas, traduciéndose en una mejora del ciclo del nitrógeno y de la gestión de la materia orgánica en el estanque. Además de gestionar la acumulación de lodos, las estrategias de biorremediación contribuyen a reforzar el ecosistema microbiano
general del estanque. De este modo, se influye de manera positiva en la calidad del agua y en la estabilidad general de los parámetros de agua y suelo, un requisito previo para alcanzar un rendimiento óptimo.
3. Estas bacterias de biorremediación, ¿son realmente eficaces?
F. Cellier: Lo sé, puede resultar difícil imaginar que la adición de unos pocos gramos de soluciones bacterianas a un estanque de camarones pueda tener un impacto en su microbiota. Por ello, nuestros científicos decidieron investigarlo a través de las técnicas más avanzadas disponibles en biología molecular para su estudio. Las técnicas que suelen aplicarse a la microbiota intestinal, nosotros las aplicamos al agua de camarones… ¿Y adivinan qué? De hecho, ¡vimos su efecto!
4. Realmente, ¿qué pasó?
F. Cellier: En primer lugar, realizamos un estudio en las fases de cría y vivero. Pudimos rastrear las bacterias de biorremediación usadas (LALSEA BIOREM, una

mezcla específica de bacterias seleccionadas para la gestión del entorno del estanque desarrollada por Lallemand Animal Nutrition) en el agua y, sobre todo, pudimos ver sus efectos en el equilibrio de la microbiota del agua: ¡Se detectaron más bacterias benéficas y menos patógenos potenciales!
Por ejemplo, al aplicar solución de Lallemand en el agua del estanque, se evidenció la drástica disminución de diferentes poblaciones microbianas, normalmente conocidas como indeseables. En el mismo estudio, en la fase de cría, se detectaron ciertas poblaciones microbianas en mayor proporción, con un efecto benéfico sobre la digestión o que pueden ser antagónicas contra Vibrio, en el estanque tratado con la solución microbiana de Lallemand.
5. Volviendo a la microbiota intestinal del camarón, ¿qué importancia tiene favorecerla?
S. Ralite: La microbiota intestinal es, para todos los animales, esencial para vivir. Así lo demuestran numerosas publicaciones científicas. En el caso del camarón, existen múltiples pruebas del potencial impacto positivo de la estimulación de la microbiota intestinal en la salud y el rendimiento de los cultivos.
F. Cellier: El aparato digestivo de los camarones es muy rudimentario, con pocos órganos:
3 El estómago, donde se produce la digestión; desempeña un papel crucial en la descomposición del alimento.
3 El hepatopáncreas, que segrega enzimas digestivas, absorbe los
Artículo
Pediococcus acidilactici CNCM I-4622 (BACTOCELL) ha sido ampliamente documentada por sus mecanismos de acción y beneficios en la cría de camarones y peces, obteniendo el único registro probiótico de la Unión Europea para esta aplicación.

alimentos digeridos y almacena los nutrientes. También, desempeña un papel crucial en la regulación de la inmunidad innata del huésped.
3 El intestino, responsable de la eliminación de residuos y de la absorción de pocos nutrientes.
Además, el tiempo de tránsito del alimento es muy corto en comparación con otros animales. Por lo tanto, es fácil entender que, si uno de estos tres órganos no hace su trabajo correctamente, la digestión, la absorción de nutrientes y la salud se ven afectadas de manera considerable, al igual que la eficiencia del alimento y, por último, los beneficios de los acuicultores.
6. Teniendo en cuenta este sistema rudimentario, ¿los probióticos funcionan realmente en los camarones?
S. Ralite: La verdad es que sí. Al menos una cepa probiótica muy específica, Pediococcus acidilactici CNCM I-4622 (BACTOCELL) ha sido ampliamente documentada por sus mecanismos de acción y beneficios en la cría de camarones y peces, obteniendo el único registro probiótico de la Unión Europea para esta aplicación.
En las últimas décadas, Lallemand ha invertido mucho en comprender cómo BACTOCELL puede beneficiar a los productores de camarones y peces. Por ejemplo, publicaciones recientes demuestran que es eficaz para favorecer la salud y la función digestiva de
los camarones, haciéndolo rentable para los camaronicultores como potenciador del factor de conversión alimenticia (FCR, por sus siglas en inglés) (Castex et al., 2021). Hoy en día, BACTOCELL se usa ampliamente para establecer y mantener un buen equilibrio de la microbiota en todas las etapas de la vida del camarón. Desde la incubación, para mejorar la calidad de las larvas e inocular una microbiota positiva, hasta la cría y la engorda para asegurar el entorno microbiano intestinal, BACTOCELL ha demostrado sistemáticamente sus beneficios en el rendimiento del camarón.
7. ¿También es posible reforzar el sistema inmunitario de los camarones mediante la alimentación?
S. Ralite: El sistema inmunitario de los camarones también es bastante simple. No se puede vacunar, así que, efectivamente, las estrategias nutricionales son clave. Diferentes tipos de productos naturales a
base de levadura pueden ayudar a reforzar las defensas inmunitarias dependiendo de la situación.
F. Cellier: Para las dietas estándar y hacer frente a los desafíos diarios (desafíos regulares de Vibrio, fluctuaciones de parámetros del agua, etc.), recomendamos la pared celular de levadura OPTIWALL. Es una fuente de betaglucanos y manano oligosacáridos, conocidos por ayudar a reforzar la salud intestinal y las defensas inmunitarias. Representa una solución versátil y de base para apoyar la robustez y el rendimiento de los camarones, con una inclusión económica y un buen retorno de la inversión.
Para alimentos más específicos y de primera calidad, durante épocas difíciles, periodos de grandes desafíos −riesgos de vibriosis, malas condiciones climáticas, síndrome de mortalidad temprana (EMS, por sus siglas en inglés), enfermedad de las heces blancas (WFD) o Enterocytozoon hepatopenaei (EHP), u otras enfermedades−, existe una fracción específica de levadura multicepas (YANG), desarrollada por su capacidad superior de unión a patógenos y su habilidad para provocar una regulación inmunitaria amplia y equilibrada, a través de efectos sinérgicos sobre los receptores inmunitarios, una solución innovadora y única, formulada para fortalecer ampliamente las defensas inmunitarias de los camarones con un efecto patentado*.
8. Por último, ¿por qué elegir a Lallemand como proveedor?
S. Ralite: A la hora de elegir un producto a base de levaduras o bacterias, es fundamental


Hoy en día, BACTOCELL se usa ampliamente para establecer y mantener un buen equilibrio de la microbiota en todas las etapas de la vida del camarón.
seleccionar un proveedor confiable que tenga un control total del producto, desde la selección de la cepa hasta la formulación final, para garantizar la calidad, consistencia y eficacia del ingrediente y, por tanto, del alimento.
Lallemand cuenta con más de un siglo de experiencia en el desarrollo y producción de soluciones microbianas para muchas aplicaciones de alimentos, con laboratorios y plantas de producción en todo el mundo. Lallemand es pionera en el desarrollo de la aplicación de soluciones microbianas específicas para la acuicultura. Desde el primer probiótico autorizado en la Unión Europea hasta el desarrollo de una amplia gama de soluciones nutricionales a base de levadura para alimentos acuícolas, Lallemand ha
participado en el desarrollo de soluciones sanitarias preventivas que contribuyen con las prácticas acuícolas sostenibles.
En la actualidad, la empresa desarrolla y aplica programas específicos centrados en la gestión de ecosistemas microbianos y la interacción microbio-huésped para maximizar las defensas naturales de camarones y peces, ayudar a mantener unas condiciones óptimas de cría, facilitar la gestión y optimizar el rendimiento de la producción. Nos asociamos con organizaciones líderes en investigación, para crear entornos de I+D que fomenten la innovación y las nuevas ideas. Nuestro equipo especializado en acuicultura está presente en los principales países productores de camarón, para contribuir con el

avance del conocimiento en gestión y prácticas microbianas, acompañar a los productores de camarón y afrontar los desafíos que enfrenta la industria

* La situación de la patente de la invención descrita puede variar según el país. No todos los productos están disponibles en todos los mercados ni todas las declaraciones asociadas están permitidas en todas las regiones.
Las referencias y fuentes consultadas por el autor en la elaboración de este artículo están disponibles bajo petición previa a nuestra redacción.
Para mayor información, contáctenos a través de:
www.lallemandanimalnutrition.com
Bernardo Ramírez Gerente general México, Argentina y Centroamérica bramirez@lallemand.com
Francois Cellier Director técnico de Acuicultura fcellier@lallemand.com

Descubre cómo la innovación y la tecnología están abordando los nuevos desafíos de la acuicultura
¡Únete
Este Simposio está dirigido al cultivo de camarón y tilapia, con el objetivo principal de seguir compartiendo los avances y desafíos de la industria acuícola en Guatemala, al mismo tiempo que se exploran las tendencias más relevantes en otros países para impulsar aún más su desarrollo.
Por: AGEXPORT*
El Sector de Acuicultura y Pesca de la Asociación Guatemalteca deExportadores, AGEXPORT, se complace en anunciar la celebración de la 3ª Edición del “Simposio de Acuicultura en Guatemala Innovación y Tecnología, Factores Clave para una Industria Resiliente”. Este evento se llevará a cabo del 22 al 24 de mayo en el Hotel Casa Santo Domingo, en La Antigua Guatemala, Guatemala. El objetivo principal de este Simposio es seguir compartiendo los avances y desafíos de la industria acuícola en Guatemala, al mismo tiempo que se exploran las tendencias más relevantes en otros países para impulsar aún más su desarrollo. El evento contará con la participación de conferencis-
tas nacionales e internacionales de reconocido prestigio en el ámbito de la acuicultura.
Este Simposio está dirigido al cultivo de camarón y tilapia, donde se presentarán más de 38 conferencias en materia de acuicultura. Adicionalmente, contará con un área de exhibición comercial de empresas proveedoras de equipos, productos e insumos para la acuicultura, quienes tendrán la oportunidad de posicionar su marca, además de generar nuevas oportunidades de negocios.
Esta edición cuenta con el patrocinio de importantes empresas nacionales e internacionales, quienes son fundamentales para el impulso y desarrollo de la industria de la acuicultura a nivel regional. Los participantes podrán asis-
tir a conferencias, recorrer el área comercial y, si lo desean, participar en visitas de campo guiadas.
Para adquirir las entradas, puede visitar nuestro sitio web, https://simposio.export.com.gt/. Se les invita a adquirir sus entradas antes del 30 de abril de 2024, para obtener el precio especial de USD 275.00. A partir del 1 de mayo de 2024, y sujeto a disponibilidad, el precio será de USD 325.00. Estos precios no incluyen visita guiada de campo.
¡No pierdas la oportunidad de ser parte de este importante evento para la industria de acuicultura!

Este artículo es patrocinado por AGEXPORT ACUICULTURA Y PESCA.
Esta edición cuenta con el patrocinio de importantes empresas nacionales e internacionales, quienes son fundamentales para el impulso y desarrollo de la industria de la acuicultura a nivel regional.


Es tiempo de acción
Durante el mes de febrero, se celebró el 4to. Summit por la Sustentabilidad Pesquera y Acuícola en Ciudad de México, donde no solo se cumplieron las expectativas, sino que fueron ampliamente rebasadas.
Por: COMEPESCA*El hoy Internacional movimiento #Pesca con Futuro de COMEPESCA, celebró los días 15, 16 y 17 de febrero el 4to. Summit por la Sustentabilidad Pesquera y Acuícola, en Ciudad de México. Bajo la premisa de construir un encuentro cada vez más amplio, incluyente, con resultados y acciones concretas en pro y cuidado de los océanos y mares a través de la sustentabilidad, se logró rebasar considerablemente todas las expectativas. Con salones llenos, hasta con un 50% por encima de su capacidad, se dieron cita productores, pescadores, comercializadores, académicos y organizaciones de todo el sector de la pesca y acuicultura, no solo de México, sino de talla mundial, como la Organización de las Naciones Unidas para Alimentación y la Agricultura (FAO), la Cámara Nacional de las Industrias Pesquera y Acuícola (CANAINPESCA), la CALAMASUR, el Comité de Pesca y Acuicultura de la Sociedad Nacional de Industrias, The Walton Family Foundation, la Confederación
Mexicana de Cooperativas Pesqueras (CONMECOOP) y la Secretaría de Pesca y Acuacultura del Gobierno del Estado de Baja California.
En este Summit, se plantearon tres ejes de coordinación de acciones: 1) Mercados, una herramienta de cambio hacia la sustentabilidad; 2) Pesca Ilegal, un problema urgente a combatir, y 3) Seguridad Alimentaria, objetivo sostenible a largo plazo.
En Mercados, la vinculación de productores responsables con los consumidores se destacó como una herramienta esencial para incentivar la adopción de prácticas de sustentabilidad, especialmente, para pequeños y medianos productores; además de ser una gran oportunidad de negocio y acceso a mejores mercados, permitiendo su desarrollo. Es decir, se incentiva un círculo virtuoso de producción sustentable-mercadodesarrollo de proveedores-producción sustentable.
También se realizó un workshop, un intercambio de puntos de vista, realmente enriquecedor, entre productores, pescadores, comercializa-
dores, cadenas de supermercados y autoridades, para impulsar la producción a través del desarrollo de proveedores pequeños, pero, comprometidos con la calidad y la sustentabilidad.
En cuanto a la Pesca Ilegal, se destacó la imposibilidad de que un solo actor ataque este problema, dada su magnitud y alcance, en la búsqueda de una estrategia integral que involucre a todos los eslabones de la cadena productiva: pescadores artesanales, comercializadores e industria, hasta los organismos responsables del ordenamiento pesquero y las autoridades de inspección y vigilancia. Con este fin, es crucial la reactivación de los planes de manejo pesquero y promover una gran alianza nacional contra la pesca ilegal.
Para que no quedara en solo buenas intenciones, se firmó el “Compromiso de Comercialización para la Adquisición Responsable de Pescados y Mariscos”, una iniciativa de Impacto Colectivo para la Pesca y Acuacultura Mexicanas (ICPMX), el
Un evento inspirador, de esperanza, pero, sobre todo de acción para construir un mejor futuro en el manejo y sustentabilidad de los recursos para la pesca y acuicultura…
cual busca convocar y comprometer a una parte importante del sector comercial de productos pesqueros y acuícolas con la implementación de prácticas para reducir la introducción de productos provenientes de la pesca ilegal, no declarada o no reglamentada (INDNR) en la cadena de suministro.
Finalmente, en relación con la Seguridad Alimentaria, se identificó la falta de una mayor difusión informada de los productos y mariscos de México a los consumidores, destacando sus enormes ventajas en cuanto a calidad, cercanía, frescura y una mucho menor huella de carbono. En tal sentido, se coincidió en darle mayor visibilidad a las historias de los pescadores y acuicultores, y su contexto, para promover el consumo de los excelentes productos del mar, sus ventajas para quien los consume y desarrollo para quien los produce… y, a mayor pro-
ducción nacional sostenible, mayor seguridad alimentaria, economía, redistribución justa de la riqueza y cuidado a los recursos naturales y el ambiente.
La reunión fue más allá de la firma del compromiso de comercialización responsable. También, se suscribió un acuerdo entre la Organización para la Conservación del Medio Ambiente, Bodai y COMEPESCA, cuyo objetivo principal es generar conciencia y llamar la atención sobre la crítica situación de la vaquita marina y los esfuerzos de conservación en curso mediante diversas campañas; asimismo, la colaboración de la Alianza Global del Marisco (GSA, por sus siglas en inglés) y COMEPESCA busca promover narrativas positivas relacionadas con la acuicultura y las pesquerías.
Adicionalmente, se pretende incentivar la participación de los jóvenes en iniciativas ambientales y
de conservación, y utilizar EarthxTV como plataforma para desmitificar conceptos erróneos sobre el medio ambiente y la ecología.
Se podría catalogar como un exitoso Summit de acción, compromiso y sumo interés, rompiendo récords con más de 290 asistentes presenciales, 19 países, 81 panelistas y 44 conferencias de alto nivel. Sin duda, fue un evento inspirador, de esperanza, pero, sobre todo de acción para construir un mejor futuro en el manejo y sustentabilidad de los recursos para la pesca y acuicultura… Único camino para tener seguridad alimentaria para un futuro sostenible y de regeneración para nuestra siempre generosa naturaleza.

Este artículo es patrocinado por COMEPESCA.
 Por: Carlos Wurmann G.*
Por: Carlos Wurmann G.*

En América Latina y el Caribe se ha invertido mucho esfuerzo, capacidades científicas y tecnológicas, así como gastos institucionales, en tratar de volcar nuestra acuicultura desde las especies “introducidas” hacia cultivos de especies autóctonas. Sin embargo, los esfuerzos no han sido particularmente exitosos. La gran interrogante es… ¿vamos a diversificarnos o a divertirnos?

En América Latina y el Caribe se ha invertido mucho esfuerzo, capacidades científicas y tecnológicas, así como gastos institucionales, en tratar de volcar nuestra acuicultura desde las especies “introducidas” hacia cultivos de especies autóctonas, en el afán de evitar problemas ambientales de diversa naturaleza. Acá, no debe olvidarse que los cul-
tivos más exitosos en muchos de nuestros países se basan en especies y cultivos exóticos, como el salmón y la trucha, el camarón Penaeus vannamei en muchos países, y la tilapia, por nombrar algunos.
Sin embargo, los esfuerzos destinados a producir tecnología para el cultivo de especies nativas no han sido particularmente exitosos, producto –por lo general– de una mala
planificación de las actividades de investigación y desarrollo (I+D); del trabajo en aspectos puntuales que no alcanzan a resolver las problemáticas productivas; de la falta de recursos económicos; de la interrupción de estos esfuerzos que suelen tomar más de 10 años, o de un pobre entendimiento de las perspectivas de mercado de especies que quizás son solo (o principalmente)
Se avanza en el conocimiento de algunos aspectos que son importantes para desarrollar tecnologías y/o mercados, pero en gran parte de los casos, dichos avances no llegan a tener un impacto en la producción y diversificación acuícola en nuestros países.
conocidas en mercados locales, y donde su venta masiva requiere de grandes inversiones de dinero y plazos extendidos para hacerse conocidas y permitir cultivos de tamaño comercialmente atractivos.
Así, por cierto, se avanza en el conocimiento de algunos aspectos que son importantes para desarrollar tecnologías y/o mercados, pero en gran parte de los casos, dichos avances no llegan a tener un impacto en la producción y diversificación acuícola en nuestros países, lo que a estas alturas debe ser cuestionado, para forzar a quienes manejan los fondos e inversiones en desarrollo tecnológico y/o de mercados a asumir sus responsabilidades, y se les pida… ¡¡¡resultados concretos!!!
Nuestros países disponen de limitados recursos humanos y financieros como para ser conformistas en estas cuestiones, con lo que debemos rebelarnos frente a tales ineficiencias que nos desgastan y no producen mayores niveles de empleo, seguridad alimentaria y/o divisas.
Universidades, institutos tecnológicos, industria y organismos de Estado deben reunirse y diseñar procesos de asignación de recursos financieros adecuados para estos propósitos, y sobre todo, invertir en un número limitado de especies a la vez, para generar “masa crítica” en las actividades que permitan llegar a buen puerto. También, deben diseñarse procesos de evaluación continua, para ir desechando actividades que no vayan entregando resultados promisorios.
No nos dejemos ilusionar demasiado por los sueños académicos, la producción de conocimientos aislados o insuficientes, y trabajemos desde ahora para que en los años del 2030 podamos disponer de tecnologías de cultivo confiables, sostenibles y eficientes para especies nativas especialmente atractivas y con mercados y economías productivas bien calibradas y estudiadas. Comprometámonos ya a completar en los próximos 10 a 15 años –al menos– las técnicas productivas y el conocimiento de mercado para

el paíche o pirarucú, cuya producción se ha intentado por décadas en Perú, Brasil y Bolivia, pero se ven limitadas por la necesidad de mejorar los procesos reproductivos y disminuir los costos de alimentación; otra especie amazónica como la gamitana o tambaquí, de carne deliciosa, con problemas de espinas y requerimientos de mejoras en las técnicas productivas; el erizo blanco en Chile, para ofrecer especies de tamaño comercial en plazos razonables y con técnicas de engorda apropiadas para cultivar cientos de miles de ejemplares; la merluza austral, disponible en pesca extractiva en zonas patagónicas de Chile y Argentina, o con algún lenguado local, especie que hasta la fecha no ha logrado resultados convincentes en Chile, Argentina ni Perú, pero que
requiere atención por su extraordinario sabor y demanda insatisfecha. Alternativamente, y en la medida que las técnicas de recirculación se hagan más eficientes, ¿tal vez nos convenga continuar importando tecnología para otras especies de alto interés comercial, si los esfuerzos de diversificación con especies locales no rinden sus frutos en plazos razonables?
Así, ¿vamos a diversificarnos o a divertirnos?
*Carlos Wurmann G. Ing. Civil Industrial, M.Sc. Economía Presidente del Centro Internacional de Estudios Estratégicos para la Acuicultura (CIDEEA) Santiago de Chile. cwurmann@cideea.org

Debemos consolidar la cooperación de las diversas regiones.
¿Podrá la Comunidad de los Países del Golfo (GCC) poner el ejemplo?
Si bien todas las regiones deberían consolidar sus organizaciones nacionales y regionales, en la Comunidad de los Países del Golfo (GCC, por sus siglas en inglés), es imperativo generar una cooperación mucho más significativa, ya que, es crucial generar tanto la masa crítica como el ecosistema para que todo este esfuerzo se vea cristalizado.
¿Será el momento de crear el Capítulo GCC o Mena de la WAS?
Hace algunos años, cuando hablábamos de eventos acuícolas lo primero, o lo único, que se nos venía a la mente eran los eventos anuales de la Sociedad Mundial de Acuacultura (WAS, por sus siglas en inglés). En estos eventos, que ocurrían a lo largo y ancho del mundo, se presentaban los trabajos más innovadores de las diferentes especies y ramas de la acuicultura, siendo −además− el lugar donde prácticamente podíamos asegurar encontrarnos y convivir con los grandes gurús de la actividad a nivel mundial.
Hoy, la cosa es más complicada. El principal motivo es que existen muchísimas zonas en el mundo donde se desarrolla la ciencia relacionada a la acuicultura, y no solamente Estados Unidos y Europa. Además, existen muchos países que han tomado a la acuicultura como un estandarte para promover no solo el crecimiento económico, sino la seguridad alimentaria. Finalmente, existe un número enorme de profesionales del sector dispersos por todo el orbe y, desde hace 5 décadas, la acuicultura ha crecido de manera impresionante.
Hoy, la WAS representa −aproximadamente− a tan solo el 0.02% de las personas que se dedican a la actividad, y podemos ver como una gran parte de sus participantes

En pocas palabras, el mercado de los eventos se está haciendo cada vez más focalizado, y no es el productor el que debe ir a ver a los expositores, son los expositores los que se tienen que acercarse ahora a los productores.

están envejeciendo y retirándose, a un ritmo más acelerado de lo que pueden ser reemplazados por una nueva generación involucrada con la Sociedad. Si bien es cierto que el COVID tuvo un altísimo impacto en las finanzas de la WAS, lo cual fue palpable en el pobrísimo evento que vivimos en San Antonio, también es cierto que el formato sigue siendo exactamente el mismo que ha tenido desde el siglo pasado. Por más que se han propuesto cambios de formato y nuevas dinámicas, estas no han podido permear de manera permanente. La WAS debe entender que el que no evoluciona… se extingue. Aunque tiene la marca más importante del mundo, también la tuvo Kodak en un momento histórico determinado. Por otro lado, me llamó la atención haber participado en el evento de SIMEC, en Arabia Saudita, a inicios de este año. En lo particular, no esperaba mucho, pero me fui con un gran sabor de boca. En este evento se tomaron en cuenta a todos los actores. Se hizo un gran énfasis en las relaciones B2B, donde
se organizaron sesiones particulares y comidas de inscritos y expositores, dándole un gran impulso a la participación del sector productivo, siendo una parte fundamental y central del evento. Esto me recordó a los grandes eventos de AquaNor (Noruega), AquaSur (Chile) y AquaExpo (Ecuador), que se desarrollan de manera similar; además, de un número cada vez mayor de eventos acuícolas en muchos países de Asia, como VietShrimp, por poner un ejemplo.
En pocas palabras, el mercado de los eventos se está haciendo cada vez más focalizado, y no es el productor el que debe ir a ver a los expositores, ahora son los expositores quienes se tienen que acercarse a los productores. Si bien todas las regiones deberían consolidar sus organizaciones nacionales y regionales, en la Comunidad de los Países del Golfo (GCC, por sus siglas en inglés), que es la región en donde hoy en día probablemente existan más recursos, visión y voluntad política para impulsar la acuicultura, es imperativo generar
una cooperación mucho más significativa, ya que, es crucial generar tanto la masa crítica como el ecosistema para que todo este esfuerzo se vea cristalizado. ¿Será el momento de crear el Capítulo GCC o Mena de la WAS? ¿O será necesario crear otro tipo de organizaciones lideradas por los productores actuales? Cualquiera que sea la respuesta, necesitará compromiso, visión y mucha pasión. Después de haber estado un par de años en esta bellísima región del mundo, estoy seguro de que el reto que se les presente, podrán superarlo.
*Antonio Garza de Yta es Senior Fisheries and Aquaculture Advisor para AWJ Innovation, Vicepresidente del Centro Internacional de Estudioso Estratégicos para la Acuacultura (CIDEEA), Presidente de Acuacultura sin Fronteras (AwF), Expresidente de la Sociedad Mundial de Acuacultura (WAS), Exsecretario de Pesca y Acuacultura de Tamaulipas y Creador de la Certificación para Profesionales en Acuacultura (CAP) junto con la Universidad de Auburn.

En Islandia, las empresas pesqueras se han adecuado a un nuevo modelo de economía circular denominado Iceland Ocean Cluster. Un proyecto que inició al identificar las oportunidades que generan los residuos obtenidos al procesar el filete de bacalao.
En Islandia, las empresas pesqueras se han adecuado a un nuevo modelo de economía circular denominado Iceland Ocean Cluster. Un proyecto que inició al identificar las oportunidades que generan los residuos obtenidos al procesar el filete de bacalao, en promedio un 35-40% del peso total del animal, el resto se tiraba anteriormente. Este filete genera ingresos de 14 dólares por kilogramo.
El éxito de este proyecto se hace posible por el mejoramiento en procesamiento y manipulación, así como en investigación y desarrollo. Actualmente, el proyecto de clúster involucra alrededor de 70 empresas, emprendedores y socios de la cadena, que incluye empresas de acuicultura, ventas, tecnología marina, software, diseño, biotecnología, cosméticos y otras. Este proyecto lleva 10 años agrupando y buscando optimizar la materia prima de la pesca de bacalao y la acuicultura de salmón.
El aumento en los combustibles, las regulaciones y las restricciones de la administración de esta pesquería, han forzado a la innovación y búsqueda de nuevas formas de explotar los residuos de esta cadena productiva. En la actualidad, se aprovecha el 80% de la materia prima. Uno de los objetivos es mostrar a pescadores y cooperativas los resultados de la unión. La participación de esta red involucra academia, emprendedores, inversionistas, investigación y desarrollo. Hoy en día, se obtiene 30% más valor que el resto del

mundo. De acuerdo con esta red, en Europa y Norte América solo se aprovecha el 50% de los residuos de pescado.
El pescado no es el filete solamente; de la hueva obtenemos productos de salud, del hígado se obtienen farmacéuticos (cápsulas omega-3, aceites omega-3), de la cabeza y huesos se obtienen productos disecados y ahumados. De la piel se obtienen productos para vestimenta, como cintos y zapatos. Del hígado y carne entreverada se obtiene paté de hígado enlatado. De las enzimas se obtienen omega-3 y colágeno. De los restos se elaboran alimentos para mascotas. Todos estos subproductos vendidos generan…
Esta iniciativa del clúster es liderada por el Dr. Thor Sigfusson, quien cuenta con una licenciatura en Economía por la Universidad de Carolina del Norte, una maestría en Negocios por la misma Universidad y un doctorado por la Universidad de Islandia en Administración. El Dr Sigfusson es autor del libro “100% fish”, libro que explica la
estrategia de este gran proyecto. Adicionalmente, el clúster cuenta con un equipo de 12 ejecutivos y administradores de proyectos que asesoran a la red, así como nuevos proyectos en otros países.
Estos equipos de soporte administran proyectos que emanan de la red del clúster; de igual forma, presentan y están en una constante búsqueda de financiamientos, inversionistas y gobiernos que desean colaborar e invertir en los proyectos de inversión identificados.
El éxito de este modelo de cooperación se ha implementado en el Clúster Oceánico de Nueva Inglaterra, el Clúster de New Bedford, el Clúster Oceánico de Connecticut, y el Clúster Oceánico de Alaska. Igualmente, tienen colaboración con el Clúster Oceánico de Río en Brasil, el Clúster Nua na mara en Irlanda, el laboratorio colaborativo de bioeconomía de Portugal y el Clúster Oceánico de las Islas Faroe.
En México existen varios centros de investigación, como los Centros Regionales de Investigación Acuícola y Pesquera (CRIAP), Centro
La economía azul actual, requiere de nuevos modelos de negocios para optimizar los niveles de utilidad y optimizar la materia prima.
PRODUCTOS DEL MAR DE CALIDAD

PRODUCTOS DEL MAR SOSTENIBLES DE CALIDAD
PRODUCTOSENLATADOS YPATÉDEHÍGADO
ENZIMAS , PIELYOMEGA-3 USADOSENPRODUCTOSFARMACEÚTICOS
de Investigación y de Estudios Avanzados del Instituto Politécnico Nacional (Cinvestav), Centro de Investigaciones Biológicas del Noroeste y Centro de Investigación en Alimentos y Desarrollo (CIAD). Ahora, recientemente, el Instituto Mexicano de Investigación en Pesca y Acuacultura, antes INAPESCA. Sin embargo, estas instituciones, públicas y privadas, realizan esfuerzos aislados de estudios de la industria, no existe una red o clúster científico que permita atraer inversión, facilite desarrollo e innovación a las necesidades prioritarias de la industria acuícola y pesquera. No obstante, es de reconocer que gran parte del desarrollo de
ENZIMAS Y OMEGA-3PARA CREMAS YCOSMÉTICOS
LOSSUBPRODUCTOSSECONVIERTEN ENSUPLEMENTOSALIMENTIC I OS
la industria acuícola y pesquera se deben al apoyo de estas instituciones, solo que requiere un nuevo encauce para la innovación urgente y necesaria para esta industria, así como la atracción de nuevos capitales de inversión.
La economía azul actual, requiere de nuevos modelos de negocios para optimizar los niveles de utilidad y optimizar la materia prima. El aumento de los costos de energéticos, así como el aumento en los alimentos balanceados, la competitividad internacional, los subsidios y las subvenciones ocultos de algunos gobiernos de países productores, vuelven la actividad acuícola y pesquera menos rentable.
Me retiro mis estimados lectores, voy a buscar quien compre cabeza de camarón y los otros residuos… ¡Ahí está el negocio!
*Alejandro Godoy es consultor de empresas, gobiernos, organizaciones acuícolas y pesqueras globalmente, tiene más de 14 años de experiencia en inteligencia comercial y ha desarrollado misiones comerciales a Japón, Europa y Estados Unidos. Fue coordinador del Consejo Mexicano del Atún, COMEPESCA (Consejo Mexicano de Promoción de Productos Pesqueros y Acuícolas), y Consejo Mexicano del Camarón. Actualmente es fundador de Seafood Business Solutions.
Contacto: alejandro@sbs-seafood.com

Todo proyecto de inversión debe contar con un plan social que permita obtener la aprobación de las comunidades dentro del área de influencia del proyecto. Omitir esto puede ser un error muy costoso.

la acuicultura se ha vuelto, cada vez, más crucial para satisfacer las necesidades alimentarias globales. Sin embargo, enfrenta desafíos como el licenciamiento social, el cual implica la aceptación y aprobación de la comunidad para nuevos proyectos.
A menudo, este aspecto no se contempla en la planificación inicial, lo que puede llevar a consecuencias graves y costosas. Es esencial involucrar a las comunidades locales desde el inicio, considerando sus opiniones y preocupaciones, para garantizar el éxito y la sostenibilidad de los proyectos acuícolas.
La consideración de la licencia social es crucial en la planificación de proyectos acuícolas para evitar conflictos y obtener el respaldo de las comunidades locales, lo que con-
duce a un desarrollo más sostenible y exitoso.
La oposición de las comunidades y grupos de interés se manifiesta de diversas maneras, desde recursos legales para detener la construcción hasta bloqueos físicos y actos de intimidación, especialmente comunes en países latinoamericanos. Con independencia de la forma de oposición, esto suele tener consecuencias graves para la empresa, desde la paralización temporal hasta la cancelación definitiva del proyecto.
Las razones para oponerse varían según la comunidad y el proyecto, pero comúnmente incluyen, entre otras:
1. Preocupaciones ambientales. En los países desarrollados, las comunidades suelen preocuparse por los impactos nega-
tivos de la acuicultura en el medio ambiente. Esto incluye el temor a la contaminación de las aguas residuales, con exceso de nutrientes y antibióticos, así como a la posible alteración de los ecosistemas marinos cercanos al proyecto debido a la salinidad y los volúmenes de descarga. Además, existe la preocupación por el escape de organismos cultivados y su potencial impacto en la contaminación genética de las poblaciones naturales, en especial, en comunidades que dependen de la pesca para su sustento.
2. Preocupaciones socioeconómicas. Los habitantes de las comunidades locales pueden ver los nuevos proyectos como una amenaza para sus medios de vida tradicionales, como en comu-
Es esencial involucrar a las comunidades locales desde el inicio, considerando sus opiniones y preocupaciones, para garantizar el éxito y la sostenibilidad de los proyectos acuícolas.
nidades pesqueras y acuícolas. Existe el temor de que la competencia de las especies producidas por los grandes proyectos afecte la viabilidad económica de los acuicultores y pescadores locales, eliminando su competitividad en los mercados regionales. La posible afectación del turismo, especialmente en zonas costeras, también preocupa a las comunidades locales, ya que esta actividad desempeña un papel crucial en sus economías.
3. Falta de transparencia y comunicación. La percepción de riesgo de los pobladores de las comunidades hacia los nuevos proyectos está influenciada por la mala comunicación de la empresa responsable y la poca información proporcionada a la comunidad. Cuando las empresas no comunican de manera efectiva los planes y posibles impactos a las comunidades, puede generar desconfianza y sospechas. La falta de participación e inclusión de la comunidad en los procesos de toma de decisiones también puede aumentar la oposición.
Para obtener el respaldo y la colaboración de la comunidad, las empresas acuícolas deben implementar un Plan Social integral antes del inicio del proyecto. Este plan debe abordar y mitigar las preocupaciones de la comunidad, demostrando un compromiso con la responsabilidad social y ambiental. Además, es crucial participar en programas de certificación de terceros para fortalecer la gobernanza ambiental.
Algunas medidas a tomar para generar confianza con las comunidades y obtener su licencia social incluyen:
1. Establecer canales claros de comunicación para informar a la comunidad sobre el proyecto y sus posibles impactos. Es crucial interactuar regularmente con las comunidades a través de reuniones abiertas, sesiones informativas y canales de comunicación accesibles. Esto permite discusiones abier-
tas sobre los posibles impactos, las estrategias de mitigación y el abordaje de las preocupaciones de la comunidad. Se debe ser transparente en la divulgación de información relevante y resultados de la implicación comunitaria, así como definir, de forma clara, los valores y objetivos compartidos con la comunidad para construir relaciones sólidas.
2. Promover la participación comunitaria. Es fundamental promover asociaciones auténticas con las comunidades mediante procesos colaborativos de toma de decisiones. Integrar el conocimiento local en la planificación y ejecución de los proyectos ayuda a abordar las necesidades y preocupaciones de la comunidad, asegurando así su apoyo y contribución al éxito del proyecto.
3. Desarrollar proyectos con responsabilidad ambiental. Para garantizar la sostenibilidad de la acuicultura, es crucial adoptar prácticas que reduzcan al mínimo su impacto en el medio ambiente. Esto implica la utilización de tecnologías amigables con el entorno, la gestión adecuada de los residuos generados durante el proceso y el monitoreo constante de los indicadores ambientales para asegurar el cumplimiento de los estándares establecidos.
4. Invertir en la comunidad. Las empresas pueden demostrar su compromiso con la comunidad invirtiendo en infraestructura local, apoyando a las empresas locales y creando oportunidades de empleo. El apoyo a causas sociales, como escuelas o servicios de salud, son gestos valorados por los pobladores.
5. Respetar los valores culturales. Comprender y respetar los valores y tradiciones culturales es esencial para evitar conflictos y generar confianza. Interactuar con los líderes de la comunidad y los representantes culturales puede proporcionar información valiosa y fomentar asociaciones significativas.
Al tomar estas medidas, las empresas pueden demostrar su compromiso con las prácticas responsables y sostenibles, abordando las preocupaciones de la comunidad y obteniendo la licencia social para operar con éxito. Esto no solo beneficia a la empresa, sino que también fomenta el desarrollo social y económico a largo plazo para la comunidad y el medio ambiente. Es importante, tener en cuenta que obtener la licencia social es un proceso continuo que requiere diálogo permanente, transparencia y un compromiso para abordar las preocupaciones de la comunidad. Al priorizar las prácticas responsables y generar confianza con las comunidades, la acuicultura puede contribuir a un futuro más sostenible y equitativo para todas las partes interesadas.
Al abordar las preocupaciones de la comunidad y obtener la licencia social para operar, las empresas acuícolas no solo demuestran su compromiso con la responsabilidad y la sostenibilidad, sino que también promueven el desarrollo a largo plazo para la comunidad y el medio ambiente.
*Roberto Arosemena es ingeniero Bioquímico con especialidad en Ciencias Marinas por el Instituto Tecnológico y de Estudios Superiores de Monterrey, Campus Guaymas, y obtuvo su maestría en Acuacultura por la Universidad de Auburn, Alabama en Estados Unidos. Cuenta con más de 35 años de experiencia en el sector acuícola nacional e internacional. Ha ocupado diferentes cargos tanto en el sector tanto privado como gubernamental entre los que destacan haber sido. Presidente fundador de Productores Acuícolas Integrados de Sinaloa A.C., empresa integradora constituida por 32 granjas camaroneras. Fue director general fundador del Instituto Sinaloense de Acuacultura por más de 9 años. Se desempeñó como secretario técnico de la Comisión de Pesca en la Legislatura LXII en la Cámara de Diputados del Congreso de la Unión. Asimismo, ocupó el cargo de director ejecutivo del Consejo Empresarial de Tilapia Mexicana A.C., Actualmente se desempeña como director general de NDC Consulting Group y como socio fundador y director ejecutivo del Centro Internacional de Estudios Estratégicos para la Acuicultura (Panamá).

enfermedad
Algunos países niegan que la cepa de Vibrio parahaemolyticus causante del AHPNS esté presente en sus cultivos de camarones, siendo probable que la situación sea similar con las que causan la enfermedad altamente letal del vibrio (HLVD/ GPD/TPD). En esta segunda parte del artículo, se aborda el componente ambiental relacionado con AHPND y GDP, así como las recomendaciones acerca de las estrategias a seguir para el control de estas patología.
Un componente medioambiental
Los primeros esfuerzos para controlar el agente patógeno del síndrome de necrosis hepatopancreática aguda (AHPNS, por sus siglas en inglés), se centraron principalmente en el uso de cloro para matarlo y eliminar cualquier vector potencial. En retrospectiva, esto ha resultado ser un error, la enfermedad continúa allí donde se mantiene esta práctica. El cloro elimina grandes cantidades de la flora microbiana natural del medioambiente, lo cual parece dar una ventaja competitiva a las cepas de Vibrio parahaemolyticus (VP) que causan AHPNS. El
sistema de secreción antibacteriano de tipo VI (T6SS, por sus siglas en inglés), mecanismo que estas cepas utilizan para matar a otras bacterias, garantiza el dominio del VP, ya que se reproduce muy rápidamente, y algunos informes sugieren que, en condiciones ideales, lo hacen en diez minutos o menos.
Es probable que las cepas responsables de la enfermedad de las postlarvas de cristal (GPD, por sus siglas en inglés), se comporten de forma similar. Mantener un microbioma “sano” parece ser fundamental para minimizar el impacto. Existen observaciones de campo que relacionan el uso de la clora-
ción en la preparación de estanques con la propagación de esta cepa de VP a expensas de muchas otras bacterias. Esto podría explicar la razón por la cual el cocultivo de camarón con tilapia, tanto directamente en estanques de camarón o, preferiblemente, en estanques adyacentes donde el agua de estos estanques se usa en los estanques de camarón, reduce la gravedad y la incidencia de la enfermedad AHPNS. El microbioma garantiza que, aunque el patógeno esté presente, no domine la enfermedad.
Una vez que el problema está presente en un grado significativo, no es fácil abordarlo de forma

reactiva y coherente para limitar su impacto. El intercambio de grandes cantidades de agua puede disminuir las cargas, pero, en el mejor de los casos, esto puede ser temporal. Ningún país ha logrado erradicar totalmente el AHPNS, aunque el grado en que afecta a una industria nacional determinada es muy variable. Los primeros indicios sugieren que el GPD puede ser más de lo mismo. En Tailandia, hay ejemplos en los que los acuicultores dejaron de aplicar cloro; mientras que sus vecinos, que lo usaban habitualmente, siguen sufriendo pérdidas por AHPNS.
La densidad de población parece influir en la susceptibilidad, al igual que la cantidad de biomasa. Las altas densidades pueden estresar a los organismos que no están preparados para estas condiciones y facilitar la propagación del patógeno. Los camarones grandes tienen mucho más tejido hepatopancreático e, incluso cuando está dañado, puede quedar suficiente tejido sano para que los organismos prosperen. Es lógico que los camarones grandes con hepatopáncreas (HP) mucho más grande, sean capaces de
tolerar exposiciones que dañarían el HP de los camarones más pequeños hasta el punto de causarles la muerte. Lo que ocurre con la GPD es probablemente similar.
Además del tamaño de los organismos, la genética también desempeña un papel en la susceptibilidad. Es probable que los reproductores mantenidos al aire libre, en instalaciones no bioseguras, se infecten, lo cual puede no ser detectable con los métodos tradicionales de análisis. Una vez que desovan, la infección puede propagarse. Puede estar presente en la planta de incubación a un nivel bajo que los métodos estándar no detecten. Una vez almacenadas las postlarvas (PL), los niveles aumentan gradualmente hasta el punto en que la enfermedad se agrava. El uso de desinfectantes que alteran de manera significativa el microbioma también parece ser un factor de riesgo. Las cepas de VP que contienen los plásmidos PIRa y PIRb, y las toxinas Tc, tienen un mecanismo (T6SS) que les permite eliminar a sus competidores en entornos en los que las poblaciones bacterianas han sido dañadas por el uso de cloro.
En conclusión, la erradicación de las cepas de VP que causan AHPNS y GPD es un reto. Muchos expertos en la materia le dirán que debe vivir con ellas. Obviamente, esto es problemático. Además, es probable que un acuicultor esté mejor con un microbioma equilibrado, donde tales patógenos puedan estar presentes en niveles bajos, que con un microbioma desequilibrado que permita la proliferación de estas cepas a niveles elevados. Los enfoques sugeridos para controlarlos son:
1. Los reproductores deben mantenerse en condiciones bioseguras, y debe hacerse todo lo posible para garantizar que no reciban alimentos contaminados, ni se infecten inadvertidamente por descuido. Los reproductores limpios producen PL limpios. Es esencial examinar, de forma individual, a los reproductores. El cribado de la población no eliminará los vibriones.
2. Se debe tener cuidado al usar cloro para tratar estanques, embalses, etc. No emplear cloro es un paso que muchos serían
Es probable que un acuicultor esté mejor con un microbioma equilibrado, donde estos patógenos puedan estar presentes en niveles bajos, que con un microbioma desequilibrado que permita la proliferación de estas cepas a niveles elevados.

Tenga en cuenta que, como ocurre con otros tipos de enfermedades similares, la situación es compleja. Lo que funciona en unas condiciones ambientales puede no tener tanto éxito en otras.
reacios a considerar. El dogma ha sido que esto es necesario para mantener los patógenos fuera de los sistemas de producción. En la mayoría de los casos, no parece funcionar con el AHPNS y, probablemente, tampoco funcione con la GPD. Es importante evitar el uso de cloro y otros desinfectantes. Es posible que los acuicultores estén mejor con microbiomas sanos, en los que el VP puede estar presente, pero, no se le da la oportunidad de proliferar en un microbioma dañado.
3. El desarrollo de cepas de camarón tolerantes e incluso resistentes al efecto de las toxinas, es un aspecto clave a largo plazo. Los camarones tienen un gran potencial genético que puede explotarse.
4. Comprender la naturaleza de la patología es importante para poder determinar si sus características están presentes en los organismos. Puede haber una amplia gama de daños dependiendo de los niveles de toxina. Con el GPD, parece que un virus también puede causar una enfermedad muy similar en ausencia de la toxina Tc descrita que contiene el VP. Esto debe examinarse más detenidamente.
5. Para verificar la presencia de VP, puede ser necesario enriquecer la muestra al emplear métodos estándar.
6. Minimizar el estrés al cual están sometidos los camarones es esencial para mitigar el impacto de la mayoría de las enfermedades que los afectan. Por lo general, los organismos debilitados serán mucho más susceptibles a una amplia variedad de enfermedades. Minimizar el estrés implica usar cepas de camarón criadas para tolerar las altas densidades, entre otras cosas, que se están convirtiendo en la norma de producción en Vietnam y, potencialmente, en otros lugares.
7. Es esencial garantizar que el oxígeno se mantenga en niveles de saturación, o próximos a ellos, mediante la aireación.
8. Minimizar el estrés de la alimentación, mediante el uso de alimentadores automáticos, también disminuirá el estrés general, garantizando que los organismos puedan acceder al alimento de manera constante y consumir la mayor parte del alimento necesario, si no todo.
9. El muestreo semanal de la salud de los camarones y la observación del HP, por personal cali-
ficado para detectar la patología característica, deben formar parte de la estrategia general. Es importante realizar análisis periódicos de los organismos moribundos. El objetivo debe ser obtener una ventaja sobre el patógeno.
10. Las altas densidades de camarones que no están bien adaptados a estas condiciones, aumentan las posibilidades de propagación de la enfermedad.
11. El uso de la biorremediación, mediante la administración selectiva de especies de Bacillus empleando PRO4000X para reducir la acumulación de materia orgánica, reducirá las fuentes de alimento disponibles para VP y otros patógenos potenciales.
La mayoría de las pruebas apunta a que la EMS/AHPNS es una enfermedad ambiental. Lo más probable es que la GPD sea similar. La cloración daña el microbioma, y permite que las cepas de VP que poseen plásmidos generadores de toxinas y producen T6SS proliferen a expensas de todas las demás bacterias, favoreciendo estas cepas dominen. Si ocurre al principio del proceso de producción, observamos grandes niveles de mortalidad temprana. Si ocurre más tarde en el ciclo, dependiendo de las cargas de toxinas y de la salud general de la población, se puede ver una gama de impactos que van desde mínimos hasta poblaciones que gradualmente dejan de comer, y en la cosecha mortalidades de moderadas a altas (a veces solo por el estrés de ser cosechadas), daños por patógenos secundarios (haciendo que el camarón no sea exportable y/o no consumible), etc. La Tabla 1, modificada del Seminario/Taller Técnico Internacional “EMS/AHPND” de junio de 2015, resume los factores de riesgo conocidos con algunas sugerencias de gestión. Estas serán las mismas para GPD.
Si las cepas de VP que causan AHPNS o GPD forman parte de un microbioma sano, su presencia en sí misma no provoca invariablemente una enfermedad aguda. La patología varía de mínima a grave dependiendo de la cantidad de exposición a la toxina. Los camarones sanos, fuertes y sin estrés, pueden resultar dañados en cierta medida, pero aun así pueden aca-


bar formando parte de un cultivo rentable. Es necesario considerar que, como ocurre con otros tipos de enfermedades similares, la situación es compleja. Lo que funciona en unas condiciones ambientales,
objeto de una investigación considerable. No hay soluciones mágicas. Lo mejor para hacer frente a estos patógenos es crear entornos de producción que favorezcan al camarón y permitan un equilibrio. Es fundamental reducir las cargas, aunque no es posible eliminarlas. Para minimizar su impacto, es fundamental mantener un microbioma sano y dinámico que impida a estos patógenos dominar.
*Stephen Newman es doctor en Microbiología Marina con más de 30 años de experiencia. Es experto en calidad del agua, salud animal, bioseguridad y sostenibilidad con especial enfoque en camarón, salmónidos y otras especies. Actualmente es CEO de Aqua InTech y consultor para Gerson Lehrman Group, Zintro y Coleman Research Group. Contacto: sgnewm@aqua-in-tech.com www.aqua-in-tech.com www.bioremediationaquaculture.com www.sustainablegreenaquaculture.com




Desde hundibles a flotantes. Desde micro a pellets. Cuando seleccione un Sistema de Proceso de Extrusión de Extru-Tech, tiene un Universo completo, con la capacidad de mantener un rendimiento de tamaño sobre el 95%. A medida que su negocio evoluciona, tiene la flexibilidad de cambiar su producto terminado, sin necesidad de grandes gastos de capital



En una industria en la que la alimentación acuática puede representar más del 50% de su costo de la operación, no apueste. Contacte a Extru-Tech y optimice su flexibilidad y rentabilidad.
Móvil: +1-785-285-8866
Email: osvaldom@extru-techinc.com

Existe un asesino silencioso y responsable del 30% de los problemas de estrés en cultivos acuícolas, al que no se le suele prestar mucha atención: el lodo del fondo de los estanques.
En innumerables ocasiones, eventos de enfermedad y estrés en producciones acuícolas son achacados a la mala calidad del agua, alimento inadecuado o a una deficiente aireación. Sin embargo, existe un asesino silencioso y responsable del 30% de los problemas de estrés en cultivos acuícolas, al que no se le suele prestar mucha atención: el lodo del fondo de los estanques.
Estos lodos contienen un alto volumen de compuestos nitrogenados, los cuales, al acumularse en el fondo, generan un aumento de la actividad bacteriana aeróbica. Esta consumirá gran parte del oxígeno del cuerpo de agua (Jasmin et al., 2020), desembocando en eventos de anoxia y procesos de descomposición anaeróbica.
Riesgos asociados a la presencia de lodos
Los principales contaminantes presentes en el lodo son materia orgánica, compuestos nitrogenados particulados, amoníaco, fósforo y sulfuros. Estos provienen fundamentalmente del alimento no consumido, desechos metabólicos y fertilizantes. El sulfuro de hidrógeno, es fruto de la reducción de sulfatos por medio de las bacterias reductoras de sulfato (SRB, por sus siglas en inglés) (Soto, 2022). La alta concentración de este compuesto interrumpirá el contacto de los sólidos con el agua; además, la respiración de los organismos causa estrés
y los hace susceptibles a enfermedades (Boyd, 2014). También, puede desencadenar problemas de eutrofización, disminución de la calidad del agua y proliferación de patógenos.
Tradicionalmente, la extracción física de los lodos ha sido la principal estrategia para abordar este problema, pero sus altos costos la hacen inviable para tres de cada cuatro proyectos.
Uso de microorganismos biorremediadores con tecnología simbiótica
Se ha comprobado que la aplicación de fermentos específicos y microorganismos seleccionados estimula procesos naturales de degradación de la materia orgánica. Este enfoque permite controlar la eutrofización y promover un equilibrio biológico saludable en los estanques de acuicultura, lo que a su vez contribuye a la salud y el bienestar de los organismos cultivados.
En la Tabla 1, se presentan algunas especies de microorganismos usados como biorremediadores (Jazmín et al., 2020).
Estos microorganismos ejercen su actuación beneficiosa, principalmente, usando la materia orgánica, el amoniaco y el fósforo como sustrato a digerir. La digestión de estas moléculas conlleva igualmente la oxidación de la misma en la capa más superficial, evitando que se entierren con más sedimentos y, una vez enterrados, sin
oxígeno generen eventos anóxicos. La oxidación de la materia orgánica mediante bacterias probióticas debe ser apoyada de manera técnica, asegurando una aireación suficiente, ya que habrá un cierto consumo de oxígeno. Si se trata de un proyecto en extensivo, sin aireación, la aplicación de los fermentos es igualmente necesaria, mientras estas se realizan a primera hora de la mañana. El stock de oxígeno natural del estanque y la producción primaria asegurarán el suministro necesario para la degradación de los lodos. En proyectos con alto contenido en materia orgánica y baja concentración de oxígeno es muy recomendable el uso de fermentos para que, en la medida de lo posible, se vayan oxidando los compuestos orgánicos, amonio y de fósforo, evitando que se acumulen o entierren, lo cual supondría un riesgo mucho mayor.
Las enzimas como actrices clave en la biorremediación de lodos
Uno de los mecanismos más importantes de actuación de los fermentos simbióticos no es solo el hecho de verter bacterias y levaduras devoradoras de materia orgánica, sino el rol que juegan las enzimas que contienen. Durante el proceso de fermentación, las bacterias usadas expelen una gran cantidad de enzimas. Esta gran diversidad de moléculas enzimáticas va desde las conocidas amilasas o proteasas, a esterasas, betaglucasas, fitasas,

celulasas, colagenasas, xilanasa, pectinasa, lipasas, entre otras. Estas enzimas son de gran importancia en la eliminación de los lodos debido a que degradan y rompen grandes moléculas, permitiendo su transformación a moléculas más livianas y libres que pueden ser
secuestradas por microorganismos y, especialmente, por flóculos con un consumo muy bajo de oxígeno.
Por su parte, Santos (2013) menciona la importancia de las enzimas según la capacidad de actuar como catalizadores, que aceleran las reacciones bioquímicas en suelo y agua,
ayudando a degradar los principales constituyentes orgánicos que normalmente se encuentran en los estanques de acuicultura. La aplicación de biorremediadores y enzimas ha generado como resultado suelos más firmes con una coloración amarilla (Figura 1), en

La oxidación de la materia orgánica mediante bacterias probióticas debe ser apoyada de manera técnica, asegurando una aireación suficiente, ya que habrá un cierto consumo de oxígeno.


comparación con el grupo control que muestra suelos más oscuros y reducidos (Figura 2).
Selección de los fermentos adecuados
Existen fermentos más adecuados que otros para la digestión de los
lodos de los estanques. Es por ello que, en la tecnología simbiótica bioaquafloc estamos desarrollando fermentos específicos para la degradación de la materia orgánica de los suelos (www.bioaquafloc. com). Como ejemplo, los fermentos más recomendables para atacar
problemas de lodos son aquellos que contienen cepas bacterianas del género Bacillus sp, tal como Bacillus licheniformis, B. subtilis o B. megaterium. Asimismo, el uso de levaduras como Saccharomyces cerevisae también ha reportado unos excelentes resultados en la degradación de lodos.
Estos fermentos son de baja carga y forman parte de la nueva tendencia en tecnología simbiótica de baja carga. Para la descomposición de lodos del estanque no podemos permitirnos integrar más materia orgánica; por ello, usamos fermentos de baja carga, donde la conseguimos con una alta concentración de probióticos, casi sin materia orgánica.
Por el contrario, el fermento bocashi no sería recomendable, puesto que aportaría demasiada materia orgánica.
La selección adecuada de fermentos y microorganismo es un aspecto clave para garantizar la eficacia y la sostenibilidad a largo plazo de los sistemas Bioaquafloc (Figura 3).
En resumen, la tecnología Bioaquafloc representa una herramienta poderosa y versátil para el tratamiento de lodos en estanques de acuicultura. Su enfoque basado en la simbiosis entre microorganismos de los fermentos y los organismos de cultivo, ofrece una solución integral y rentable para abordar la gestión de residuos y la restauración ambiental en la acuicultura.
Este artículo ha sido escrito con la colaboración del Ing. Juan Manuel Cuayal.
Las referencias y fuentes consultadas por el autor en la elaboración de este artículo están disponibles bajo petición previa a nuestra redacción.
David Celdrán es Doctor en Ecología Marina, Máster en acuicultura y Licenciado en Ciencias Ambientales por la Universidad de Murcia. Colaborador de investigación en laboratorios en Francia, Corea del Sur, Australia y México. Fue investigador nacional SNI1 en México. Consultor de Conservation International Foundation en Costa Rica y Asesor internacional de empresas productivas en tecnologías acuícolas simbióticas. Revisor de la Revista Ingeniantes CITT. Tutor académico de tesis de doctorado en tecnologías simbióticas. Fundador y gerente de la web de acuicultura simbiótica www.bioaquafloc.com

Entre los factores que más influyen en la producción de alimentos balanceados se encuentra la falta de suministros de materia prima, y esto se debe principalmente a los cambios climáticos.

¿Qué es “El Niño”?
Es un fenómeno que se desarrolla actualmente en México, el cual provoca calentamiento en la atmósfera y cambia los patrones de circulación en todo el mundo. Ha originado un incremento de agua cálida en la entrada del Golfo de California, registrando un aumento de temperatura de hasta cinco grados Celsius, causando disminución de fitoplancton, nutrientes y una mayor salinidad, lo que impacta en la industria pesquera, volviendo aún más escasa la harina de pescado, una de las materias primas más cotizadas por su alto valor nutricional.
Universidades reconocidas, entre ellas la Universidad Nacional Autónoma de México (UNAM), se han adentrado más a fondo en el tema, realizando estudios para entender este fenómeno. La UNAM detalló que es el fenómeno de variabilidad océano-atmósfera más importante del Pacífico tropical, siendo uno de los principales causantes de cambios estacionales, variabilidad en el patrón del viento y temperatura del
mar, un evento que tiene una ciclicidad de 2 a 7 años.
A causa de estos eventos climáticos, la escasez de la harina de pescado se ha vuelto un problema muy grave, haciendo que las empresas sustituyan esta materia prima por otras, como las de origen vegetal, pero, esto no será siempre así, debido a que los cambios climáticos también han afectado los campos de cultivo.
Los alimentos balanceados no solo son elaborados con materias primas de origen animal, también se incluye un porcentaje de origen vegetal. Por lo tanto, la escasez se centra tanto en las materias primas de origen animal, como en las de origen vegetal.
La sequía y la falta de agua han causado que la cosecha de granos vaya en disminución, originando pérdidas monetarias en estas industrias procesadoras de alimentos balanceados.
Debido a estos fenómenos naturales, las plantas de rendimiento, así como las plantas procesadoras
de granos se han visto obligados a encarecer estas materias primas.
El cambio climático se considera un riesgo para la producción mundial de alimentos y una gran amenaza para la calidad y cantidad de producción. Los efectos del cambio climático en la acuicultura han ido en aumento, causando el retraso de la producción de especies. Estas empresas se han visto obligadas a buscar alternativas y estrategias de adaptación para no ver afectados sus sistemas de producción acuícola, dejando otros componentes de la cadena de valor poco claros. Los efectos del cambio climático en la acuicultura se han estudiado y examinado exhaustivamente, tanto en la escala regional como mundial, debido a la importante contribución del sector a la seguridad alimentaria, la nutrición y los medios de vida mundiales.
Las referencias y fuentes consultadas por el autor en la elaboración de este artículo están disponibles bajo petición previa a nuestra redacción.
Lilia Marín es Ingeniero Químico, egresada de la Universidad de Guadalajara, con especialidad en Nutrición, Producción de Alimentos para Mascotas y Acuicultura por la Universidad T&M. Se ha desarrollado en Jefaturas y Gerencias de Calidad y Producción en Aceiteras y Empresas de Alimentos Balanceados. Consultora Internacional y Nacional para Empresas de Plantas de Rendimiento de subproductos de origen animal terrestre y marino y consultora en microscopia de alimentos, entre otros.
CEO de Proteínas Marinas y Agropecuarias S.A. de C.V. (PROTMAGRO) y PROTMARIN S.A. de C.V. y de Marín Consultores Analíticos.

Incluso en la era de las redes sociales, el correo electrónico sigue siendo una herramienta importante en la estrategia de marketing empresarial. Entre las muchas ventajas de mantener una estrategia de marketing por correo electrónico están el conservar la propiedad de la lista de destinatarios, las conexiones directas con clientes actuales y potenciales, la personalización y la segmentación de la audiencia.
Incluso en la era de las redes sociales, el correo electrónico sigue siendo una herramienta importante en la estrategia de marketing empresarial. Entre las muchas ventajas de mantener una estrategia de email marketing están el conservar la propiedad de la lista de destinatarios, las conexiones directas con clientes actuales y potenciales, la personalización y la segmentación de la audiencia. Constant Contact, una plataforma de email marketing, estima que el retorno medio de la inversión (ROI, por sus siglas en inglés) del marketing por correo electrónico es del 36% (Sirohi, 2023). Esta cifra es superior al mejor ROI observado en las plataformas de redes sociales, donde se calcula que Instagram tiene un ROI del 25%, seguido de cerca por Facebook, con un 23% (Forsey, 2023).
Para aprovechar este potencial, es esencial que su estrategia esté bien planificada y ejecutada. Un mal rendimiento del email marketing puede deberse (sin ningún orden en particular) a:
9 Mal diseño del correo electrónico.
9 Falta de personalización.
9 Líneas de asunto débiles o con spam
9 Falta de una lista de correo relevante.
9 Lista de correo no segmentada.
9 Llamada a la acción débil.
Estos fallos pueden dar lugar a un bajo porcentaje de apertura y clics y a un alto porcentaje de bajas y rebotes; métricas que pueden llevar a los propietarios de empresas/ empresarios de mercadeo a reconsiderar su uso del correo electrónico. La tasa de apertura (open rate) es el porcentaje de correos electrónicos abiertos en comparación con el número de correos enviados. La tasa de clics (clik rate) mide el porcentaje de destinatarios que hicieron clic en el correo electrónico sobre el total que lo recibió. La tasa de baja (unsubscribe rate) es el porcentaje
de destinatarios que hacen clic en darse de baja en el correo electrónico. La tasa de rebote (bounce rate) es el porcentaje de correos electrónicos que no se pueden entregar del número enviado.
Las tasas promedio para la industria agroalimentaria y todas las industrias en diciembre de 2023 se sitúan en los intervalos indicados en la Tabla 1 (Anónimo, n.d., Elder, 2023).
El seguimiento de los datos analíticos del correo electrónico puede ayudar a identificar dónde puede estar el problema y proporcionar


El seguimiento de los datos analíticos del correo electrónico puede ayudar a identificar dónde puede estar el problema y proporcionar un punto de partida para realizar los ajustes necesarios con el fin de mejorar el rendimiento.
un punto de partida para realizar los ajustes necesarios con el fin de mejorar el rendimiento. La mayoría de los servicios de email marketing, como Constant Contact o Mail Chimp, proporcionan datos analíticos a los suscriptores (aunque la cantidad y el tipo de datos pueden variar en función del nivel de suscripción). Entre las acciones que puede emprender para mejorar el rendimiento de su email marketing se incluyen las siguientes:
Asegúrese de que el correo electrónico y la plantilla son compatibles con dispositivos móviles. Las estadísticas indican que entre el 50% y el 80% de los correos electrónicos se abren y leen en un dispositivo móvil. Por lo tanto, debe asegurarse de que los correos electrónicos que envía están formateados para ese público. El contenido que requiere que los destinatarios se desplacen hacia los lados o de izquierda a derecha, por ejemplo, es más difícil de leer en un smartphone. El uso de plataformas de email marketing puede
garantizar que los mensajes estén optimizados para su visualización en móviles.
Mantenga el correo electrónico limpio y despejado. Un correo electrónico atractivo y organizado puede atraer a la gente, mientras que aquellos demasiado largos y mucho contenido (imágenes, enlaces, contenido, vídeo, etc.) pueden disuadir a la gente de leerlo y, en última instancia, de hacer clic en él. Limpie su(s) lista(s) de correo electrónico. Una lista de correo electrónico limpia mejorará las tasas de apertura, clics, bajas y rebotes. Elimine las direcciones de los destinatarios que no hayan abierto los correos electrónicos después de cierto tiempo (por ejemplo, nueve meses) o después de que se les haya enviado un determinado número de correos electrónicos. Elimine también las direcciones para las que reciba mensajes no entregables. Limpiar una lista de correo electrónico puede llevar tiempo, pero le proporcionará una base sólida para sus decisiones de email marketing.
Segmente su lista de correo electrónico. Si solo tiene una lista de correos electrónicos, considere la posibilidad de segmentarla en dos (o más) listas. La segmentación le da la oportunidad de crear correos electrónicos diferentes para cada grupo de destinatarios, adaptados a sus necesidades y aumentando la probabilidad de fidelización (engagement). Por ejemplo, un segmento podría ser el de los suscriptores más recientes, de menos de un año, mientras que otro podría ser el de los responsables clave de la toma de decisiones en su empresa.
Escriba líneas de asunto convincentes. Piense en el asunto como un cebo para hacer clic. Una línea de asunto corta y creativa puede ayudar a que su correo electrónico destaque e incite al destinatario a abrirlo. En cambio, un asunto que suene a “spam”, con palabras como “gratis” o “ganar”, será rápidamente detectado por muchos filtros.
Aporte valor. Respalde la línea de asunto con contenido que los destinatarios deseen y valoren. A nadie le gusta sentir que ha perdido el tiempo leyendo un correo electrónico, y un contenido de poco valor hará precisamente eso, además de enviar futuros correos a la papelera. ¿Qué información compartirá que sea interesante o útil para el destinatario? Una trampa común es creer que el valor reside solo en los descuentos o los códigos de venta. Sin embargo, para el destinatario, el valor puede ser tan simple como una idea para un uso alternativo del producto, o una historia humorística y relevante para la marca que le alegre el día. La clave está en conocer a su público y saber en que punto del proceso de marketing se encuentra.
Haga una llamada a la acción. ¿Qué acción quiere que realicen los destinatarios al abrir y leer su correo electrónico? Puede ser ir a su sitio web, concertar una cita con usted o ver un vídeo explicativo. La llamada a la acción (call-to-action, CTA) es un elemento fundamental de un


El uso de plataformas de email marketing puede garantizar que sus mensajes estén optimizados para su visualización en dispositivos móviles.
email marketing eficaz y refuerza el contenido. Lo ideal es que solo haya una llamada a la acción por correo electrónico y que destaque.

Mejorar los índices de entrega. Tras el esfuerzo de recopilar direcciones de correo electrónico, crear listas segmentadas y redactar líneas de asunto y contenidos atractivos, lo que quiere es que su mensaje llegue a la bandeja de entrada y no a la de spam. Dos formas de conseguirlo son utilizar el doble opt-in y pedir a los destinatarios que añadan su dirección de correo electrónico como contacto de confianza. Envíe correos electrónicos en los momentos óptimos. Puede resultar difícil de creer, pero sus contactos no están sentados en sus ordenadores o sosteniendo sus dispositivos móviles esperando su correo electrónico. La mayoría de los proveedores de servicios de correo electrónico ofrecen ahora la posibilidad de programar el envío, lo que te permite redactar tu correo a las 2 de la madrugada, pero
enviarlo cuando los destinatarios tengan más probabilidades de verlo y abrirlo. Además de las funciones de programación, las plataformas de email marketing recopilan y comparten datos sobre cuándo se abren los correos electrónicos en los análisis que proporcionan.
Probar, medir y adaptar. Los sofisticados servicios de email marketing disponibles facilitan la comprobación de la eficacia de diferentes plantillas de correo electrónico, botones CTA, líneas de asunto, diseño de contenidos y mucho más. Aproveche estas posibilidades, pero no olvide medir los resultados y hacer los ajustes necesarios.
El email marketing puede ser muy eficaz y rentable si se le dedica el tiempo y la atención adecuados. Aproveche las herramientas disponibles para adaptarlo a sus objetivos y a las necesidades y preferencias de su público. No tenga miedo de experimentar a la hora de realizar cambios, algo que puede resultar difícil cuando se trabaja con una estrategia de larga duración. Aunque mejorar el rendimiento de una estrategia de email marketing puede llevar tiempo, los beneficios valdrán la pena.

Las referencias y fuentes consultadas por el autor en la elaboración de este artículo están disponibles bajo petición previa a nuestra redacción.
Sarah Cornelisse forma parte del equipo de extensión en emprendimiento agrícola y gestión empresarial en la Universidad de Penn State dentro del Departamento de Economía Agrícola, Sociología y Educación. Sarah tiene experiencia en marketing directo, valor agregado, espíritu empresarial y marketing de productos alimenticios. Se especializa en el uso de medios digitales y sociales para la producción agrícola, el marketing de empresas alimentarias, su planificación y toma de decisiones en negocios. Es originaria del estado de Nueva York, tiene una licenciatura en matemáticas por la Universidad Estatal de Nueva York y dos grados de maestría en Economía Agrícola y Ciencias Animales, ambos por la Universidad de Penn State.
Correo electrónico de correspondencia: sar243@psu.edu


ALIMENTOS BALANCEADOS
CARGILL SEGUNDA DE FORROS, 5 y CONTRAPORTADA
Carretera Internacional y Calle Fresno S/N Parque
Industrial No. 2
C.P. 85000 | Cd. Obregón, Sonora.
Contacto: Osvaldo Anaya / Clarissa Navarro
Tel: 644 410 6235
E-mail: clarissa_navarro@cargill.com W: www.cargill.com.mx
MEGASUPPLY
Centroamérica, EE.UU., Europa, Sudamérica, Asia y Medio Oriente
Tel: +1 305 381 0210
E-mail: orders@megasupply.net
W: www.megasupply.net
35
AQUACULTURE AFRICA 2024 81
Nov. 20-23, 2024
Hammamet, Túnez
T: (+1) 760 751 5005
Fax: (+1) 760 751 5003
E: worldaqua@was.org
W: www.was.org
ASIAN-PACIFIC AQUACULTURE 2024 81
Julio 2-5, 2024
Surabaya, Indonesia
T: (+1) 760 751 5005
Fax: (+1) 760 751 5003
E: worldaqua@was.org
W: www.was.org
SIMPOSIO DE ACUICULTURA GUATEMALA 59
Mayo 22-24, 2024
La antigua Guatemala, Guatemala
Tel: (502) 5596-8781
NATIONAL RENDERERS ASSOCIATION, INC 25
Oficina para Latinoamérica: Sierra Candela 111 Oficina 501. Lomas de Chapultepec
C.P. 11000 CDMX
Contacto: Luz María Cano
Tel: (55) 55 5980 6080
E-mail: nramex@nralatinamerica.org
ZEIGLER BROS, INC
400 Gardners, Station RD, Gardners, PA. 17324, EE.UU. Contacto: Susan Thompson
41
Tel: 717 677 6181
E-mail: sales@zeiglerfeed.com www.zeiglerfeed.com
ANTIBIÓTICOS, PROBIÓTICOS Y ADITIVOS PARA ALIMENTOS
MEGASUPPLY
Centroamérica, EE.UU., Europa, Sudamérica, Asia y Medio Oriente
Tel: +1 305 381 0210
E-mail: orders@megasupply.net W: www.megasupply.net
PHODÉ
E- mail: phode@phode.com www.phode.com
E-mail: simposiodeacuiculturag@agexport.org.gt https://simposio.export.com.gt/
LATIN AMERICAN & CARIBBEAN AQUACULTURE
2024 81 y TERCERA DE FORROS
Sept. 24-27, 2024
Medellín, Colombia
T: (+1) 760 751 5005
E: worldaqua@was.org W: www.was.org
SERVICIOS DE INFORMACIÓN
61 www.comepesca.com
35
1
PRILABSA INTERNATIONAL CORP 17 2970 W. 84 St. Bay #1, Hialeah, FL. 33018, EE.UU. Contacto: Roberto Ribas. Tel: 305 822 8201, 305 822 8211 E-mail: rribas@prilabsa.com www.prilabsa.com
COSECHADORAS, MAQUINARIA Y EQUIPO PARA FABRICACIÓN DE ALIMENTOS
EXTRUTECH
343 W. Hwy 24, Downs, KS 67437, EE.UU. Contacto: Judy Long. Tel: 785 454 3383, 785 284 2153, 52 2955 2574
E-mail: extru-techinc@extru-techinc.com, osvaldom@extru-techinc.com W: www.extru-techinc.com
EQUIPOS DE AIREACIÓN, BOMBEO, FILTROS, MOBILIARIO PARA LABORATORIO E INSTRUMENTOS DE MEDICIÓN
73
PANORAMA ACUÍCOLA MAGAZINE
Empresarios No. #135 Int. Piso 7 Oficina 723
Col. Puerta de Hierro, C.P.45116. Zapopan, Jal. México. Cruza con las calles Av. Paseo Royal Country y Blvrd. Puerta de Hierro
Tels: +52 (33) 8000 0578
Contacto 1: Suscripciones
E-mail: suscripciones@panoramaacuicola.com
Tel: +52 (33) 8000 0629 y (33) 8000 0653
Contacto 2: Juan Carlos Elizalde, ventas y mercadotecnia
E-mail: crm@dpinternationalinc.com www.panoramaacuicola.com
85
SUN ASIA AERATION INT´L Co., Ltd......................9 15f, 7, Ssu-wei 4 road, Ling-ya District, Kaohsiung, 82047 Táiwan R.O.C.
Contacto: Ema Ma.
Tel: 886 7537 0017, 886 7537 0016
E-mail: sales@pioneer.tw.com www.pioneer-tw.com
EVENTOS Y EXPOSICIONES
AQUA 2024 BLUE FOOD / GREEN SOLUTION 81
Agosto 26 - 30, 2024. Copenhagen, Dinamarca. Tel: +1 760 751 5005
E-mail: worldaqua@aol.com www.was.org
Aquaculture Magazine
Design Publications International Inc.
203 S. St. Mary’s St. Ste. 160
San Antonio, TX 78205, EE.UU.
Oficina en EE.UU: +(210) 229 9036
Oficina en EE.UU, Directo: +(210) 504 3642
Oficina en México: (+52) (33) 3632 2355
Suscripciones: iwantasubscription@dpinternationalinc.com
Publicidad: crm@dpinternationalinc.com / sse@dpinternationalinc.com www.aquaculturemag.com
SEAFOOD EXPO NORTH AMERICA 2024
Marzo 10-12, 2024
Boston Convention and Exhibition Center
Boston, EE.UU.
T: +1 207-842-5504
E: sales-na@seafoodexpo.com; info-na@seafoodexpo.com; customerservice@divcom.com
W: www.seafoodexpo.com/north-america
AQUASUR. FOR A BLUE TRANSFORMATION
Marzo 19-21, 2024
Puerto Montt, Chile
T: +56 9 8188 8565
E:info@aqua-sur.cl
W: www.aqua-sur.cl
SALÓN DE LA CONCHYLICULTURE ET DES CULTURES MARINES 2024
Marzo 20-21, 2024
La Tremblade, Francia
T: 05 46 36 99 17
E: salon@la-tremblade.com
W: https://www.salon-conchyliculture.com/
THE GLOBAL SEAFOOD MARKETPLACE
Abril 23-25, 2024
Barcelona, España
T: +1 207-842-5590
E: sales-global@seafoodexpo.com; customerservice@divcom.com; cperkins@divcom.com
W: https://www.seafoodexpo.com/global/
AQUACULTURE UK 2024
Mayo 14-15,2024
Macdonald Aviemore, Escocia
T: +44 (0)1273 063841
E: aharrison@divcom.co.uk
W: https://aquacultureuk.com/
AUSTRALIAN CONFERENCE AQUA FARM
2024
Mayo 14-17, 2024
Gold Coast, Australia
T: +61 390163202
E: rakshith.kumar@aquacultureconference. com.au
W: https://aquacultureconference.com.au/
AQUAEXPO MANABÍ 2024
Mayo 15, 2024
Manabí, Ecuador
T: (+593) 4 268 3017 ext. 124
E: cmosquera@cna-ecuador.com
W: www.aquaexpo.com.ec/
WORLD SEAFOOD INDUSTRY
Mayo 15-17, 2024
Guadalajara, Jalisco
T: (+52) 55 7028 3335
E: infoagrotechwsi@igeco.mx
W: worldseafoodindustry.mx/
SIMPOSIO DE ACUICULTURA
GUATEMALA
Mayo 22-24, 2024
La antigua Guatemala, Guatemala
Tel: (502) 5596-8781
E-mail: simposiodeacuiculturag@agexport. org.gt https://simposio.export.com.gt/
XXI SIMPOSIO INTERNACIONAL SOBRE NUTRICIÓN Y ALIMENTACIÓN DE PECES
Mayo 27-31, 2024
Puerto Vallarta, México.
T: +52 (55) 1090 2474
E: isfnf2024secretariat@gmail.com, isfnf2024sponsor@gmail.com
W: http://isfnf2024.com/
AQUAVISION 2024
Junio 10-12, 2024
Stavanger, Noruega W: www.skretting.com/aquavision/
GLOBAL TILAPIA LEADERS
Junio 26-28, 2024
San Salvador, El Salvador W: http://globaltilapialeaders.com/
ASIAN-PACIFIC AQUACULTURE 2024
Julio 2-5, 2024
Surabaya, Indonesia
T: (+1) 760 751 5005
Fax: (+1) 760 751 5003
E: worldaqua@was.org W: www.was.org
AQUAEXPO EL ORO 2024
Julio 9-11, 2024
El Oro, Machala, Ecuador
T: (+593) 4 268 3017 ext. 124
E: cmosquera@cna-ecuador.com W: www.aquaexpo.com.ec/
BLUE FOOD/GREEN SOLUTIONS AQUA 2024
Ago. 26-30, 2024
Copenhagen, Dinamarca
T: (+1) 760 751 5005
Fax: (+1) 760 751 5003
E: worldaqua@was.org
W: www.was.org, www.aquaeas.org



Los efectos del cambio climático en el crecimiento de la producción acuícola mundial: desafíos, afectaciones e impacto económico
El cambio climático está alterando significativamente el panorama global de la acuicultura, una industria crucial para la seguridad alimentaria mundial. Con el calentamiento global, esta industria enfrenta desafíos sin precedentes que podrían afectar su crecimiento y sustentabilidad. Este artículo examina los principales retos, las posibles afectaciones y el probable impacto económico de estas transformaciones.
Por: Artemia Salinas*Principales retos frente al cambio climático
La acuicultura depende intrínsecamente del clima y del medio ambiente. Con el cambio climático, esta industria enfrenta varios retos fundamentales:
9 Cambios en la temperatura del agua: el aumento de las temperaturas puede afectar la salud y el crecimiento de las especies acuícolas, alterando sus ciclos de vida y aumentando su susceptibilidad a enfermedades.
9 Acidificación de los océanos: la creciente acidificación de los océanos, causada por la absorción de CO², afecta negativamente a especies clave, como moluscos y crustáceos, cuyos esqueletos y conchas pueden debilitarse.
9 Eventos climáticos extremos: huracanes, tormentas y fenómenos climáticos extremos se han vuelto más frecuentes y severos,
poniendo en riesgo las instalaciones acuícolas y la seguridad del suministro.
Posibles afectaciones a la producción acuícola
Las alteraciones climáticas traen consigo impactos directos e indirectos en la acuicultura:
9 Reducción en la producción: las especies pueden experimentar tasas de crecimiento más lentas o mayores tasas de mortalidad, lo que conduce a una disminución en los volúmenes de producción.
9 Pérdida de biodiversidad: el cambio climático puede conducir a la pérdida de hábitats naturales y a la disminución de la biodiversidad, afectando la base de la cadena alimentaria acuícola.
9 Diseminación de enfermedades: el aumento de la temperatura favorece la proliferación
de patógenos y parásitos, lo que puede llevar a brotes de enfermedades más frecuentes y severos.
Impacto Económico
El impacto económico del cambio climático en la acuicultura es multifacético:
9 Aumento de costos operativos: la necesidad de adaptarse a condiciones cambiantes, como la instalación de sistemas de refrigeración o el tratamiento de enfermedades, puede aumentar significativamente los costos operativos.
9 Disminución de ingresos: la reducción en la producción y la calidad puede llevar a una disminución de los ingresos para los productores acuícolas.
9 Inversión en adaptación y mitigación: para combatir los efectos del cambio climático, se requieren inversiones significa-


tivas en investigación y desarrollo, así como en la adaptación de infraestructuras y prácticas.
Adaptación de la industria acuícola global al cambio climático: acciones actuales y estrategias futuras
El cambio climático es una realidad ineludible, y su impacto en la industria acuícola global ha desencadenado una serie de iniciativas y estrategias para adaptarse a este nuevo escenario. La acuicultura, siendo una fuente vital de alimentos y empleo a nivel mundial, enfrenta desafíos únicos que requieren soluciones innovadoras y sostenibles.
Acciones actuales en la industria acuícola
9 Mejora de la resiliencia genética: la selección y el cultivo de especies y variedades resistentes al estrés térmico y enfermedades se han vuelto prioritarios. El mejoramiento genético, apoyado por la biotecnología, está ayudando a desarrollar stocks más robustos.
9 Sistemas de recirculación de agua (RAS): la implementación de RAS en la acuicultura de tierra adentro permite un control más preciso sobre las condiciones ambientales, reduciendo la vulnerabilidad a los cambios climáticos.
9 Gestión de riesgos y planes de contingencia: la industria está adoptando sistemas de monitoreo ambiental y protocolos de emergencia para responder rápidamente a eventos
extremos, como inundaciones o tormentas.
9 Prácticas de acuicultura sostenible: se promueve la acuicultura de bajo impacto, utilizando prácticas que minimizan la huella ambiental, como la alimentación eficiente y la gestión adecuada de residuos.
Estrategias de adaptación y mitigación
Para enfrentar estos desafíos, la industria acuícola debe adoptar estrategias proactivas:
9 Innovación y diversificación de especies: investigar y cultivar especies más resistentes al cambio climático puede ayudar a mantener la producción.
9 Mejoras en la gestión y la infraestructura: implementar prácticas de gestión más eficientes y desarrollar infraestructuras resilientes puede minimizar los impactos negativos.
9 Sistemas de monitoreo y alerta temprana: establecer sistemas para monitoreo de la salud de los cultivos y prevenir brotes de enfermedades es crucial para la gestión de riesgos.
Conclusión
El cambio climático representa un desafío significativo para la acuicultura mundial. Sin embargo, con la implementación de estrategias adecuadas de adaptación y mitigación, es posible minimizar sus impactos. La inversión en investigación, tecnología y prácticas sostenibles será clave para asegurar el futuro de una industria vital para la seguridad
alimentaria global. La capacidad de la industria para adaptarse no solo determinará su viabilidad económica, sino también su contribución a la nutrición y al bienestar de las poblaciones en todo el mundo.
Calcular el costo del calentamiento global en la acuicultura global representará un desafío complejo y multifacético, dada la diversidad de especies cultivadas y la variedad de ecosistemas acuícolas afectados. Factores como el aumento en la temperatura del agua, la acidificación de los océanos y la frecuencia de eventos climáticos extremos tendrán efectos directos e indirectos sobre la productividad y la sostenibilidad de las operaciones acuícolas.
Estos impactos se traducirán en costos incrementales relacionados con la adaptación de infraestructuras, la inversión en sistemas de monitoreo y manejo de enfermedades, así como la potencial disminución en los rendimientos de producción. Además, habrá costos menos tangibles, pero igualmente significativos, como la pérdida de biodiversidad y las alteraciones en la cadena alimentaria acuícola. En conjunto, estos factores podrían significar millones de dólares en pérdidas y gastos adicionales para la industria acuícola global, afectando su viabilidad económica y su capacidad para contribuir a la seguridad alimentaria mundial. La necesidad de investigaciones y modelos económicos más robustos es imperativa, para comprender y mitigar estas repercusiones financieras a corto y mediano plazo.
